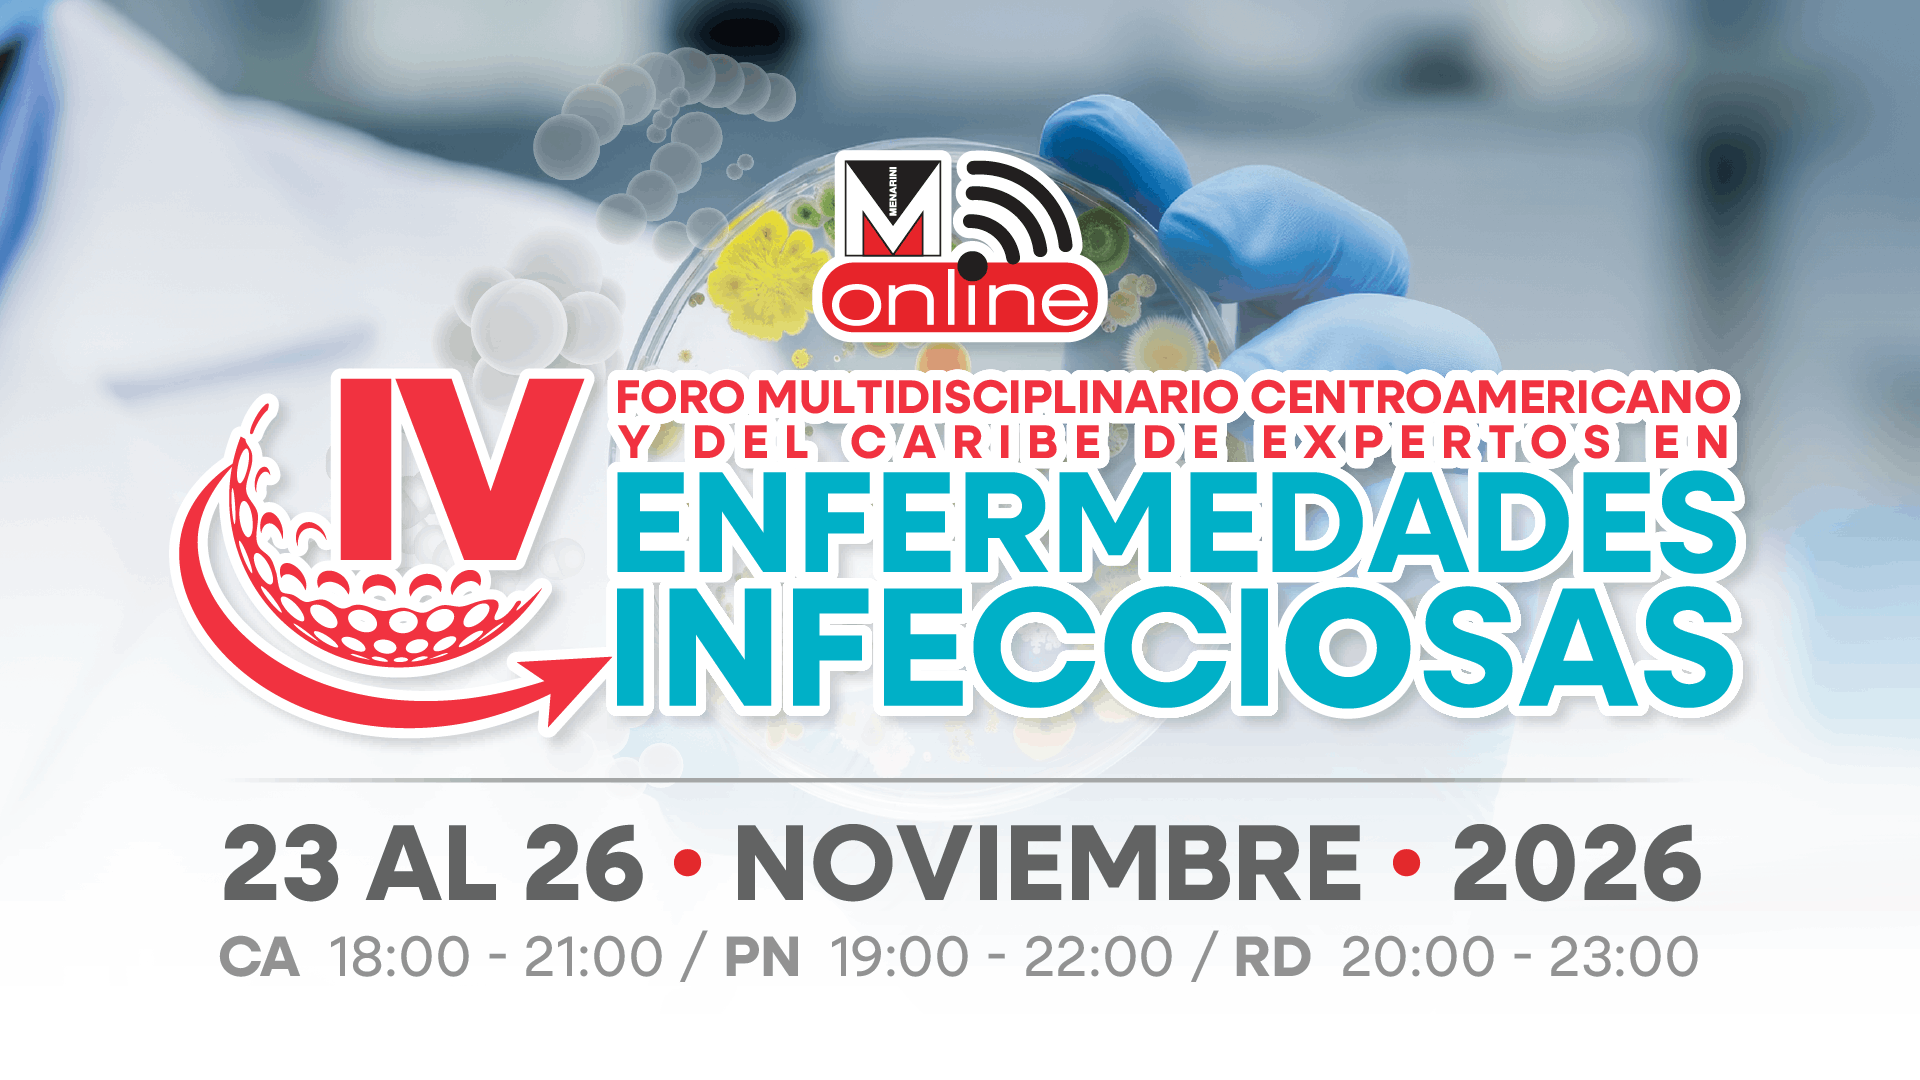
Imagen del evento

01 junio
Como parte del continuo proceso de crecimiento y aprendizaje Grupo Menarini a través de Área Científica Menarini Online organiza y patrocina la actividad científica: RECOMENDACIONES TERAPÉUTICAS PARA LOS PROBLEMAS DERIVADOS DE LA DENTICIÓN EN LOS BEBÉS, con la cual se busca establecer y facilitar el conocimiento de cualquier patología oral con todos los pormenores y generar discusión de los casos presentados con los excelentes conferencistas de las diferentes especialidades médicas y odontológicas que dará como resultado un diagnóstico más seguro y un tratamiento efectivo para beneficio en el desarrollo del bebé.

13 abril
La importancia de las enfermedades alérgicas radica en su propia naturaleza. Son procesos muy frecuentes, que afectan al paciente, en las fases de su vida en las que la producción laboral o académica es más intensa, además interfieren de forma significativa en las actividades cotidianas y perturban el sueño a menudo. Nuestro XIV Simposium Centroamericano y Del Caribe Multidisciplinario de Enfermedades Alérgicas y de Piel está orientado al manejo integral de las enfermedades alérgicas, enfocándose principalmente en rinitis y urticaria, mediante presentaciones y debates de temas de actualidad. Además, resaltará la importancia de un manejo más profundo de estas patologías a través de métodos que permitan al médico tener el control de los síntomas asociados y brindarle a cada uno de los pacientes una mejor calidad de vida.

11 mayo
Debido a la relevancia epidemiológica de las enfermedades cardiovasculares y considerando que su morbilidad representa un alto costo para nuestros países y las familias afectadas, el objetivo de este XV Simposium Centroamericano y del Caribe Online de Actualización en Enfermedad Cardiovascular es fortalecer los conocimientos sobre las enfermedades cardiovasculares, así como promover la conciencia sobre la importancia de la modificación de los hábitos de vida dirigida a reducir los factores de riesgo que conforman la enfermedad cardiovascular.

18 mayo
La Sociedad Europea de Hipertensión (ESH), la Sociedad Interamericana de Hipertensión (ISH) y la Sociedad Latinoamericana de Hipertensión (LASH) conscientes de la necesidad de la educación médica continua de calidad en el gremio médico y teniendo en cuenta que tiene su núcleo fundamental en el autoaprendizaje individual, realiza este Master Course Online en Hipertensión y Riesgo Cardiovascular, para compartir el conocimiento y crear una relación científica entre las Sociedades y los especialistas de esta región en la actualización del diagnóstico y tratamiento de la hipertensión arterial y sus factores de riesgo, para contribuir a la prevención de la enfermedad cardiovascular en Centroamérica y el Caribe.

20 abril
Las enfermedades alérgicas afectan actualmente a más de 1,000 millones de personas en el mundo y su prevalencia continúa en aumento, esperándose duplicar o incluso triplicar esta cifra para el año 2,050 (50% de la población). Entre las enfermedades alérgicas y sus asociaciones más comunes se encuentran la rinitis/conjuntivitis y asma alérgica, la rinosinusitis con o sin poliposis nasosinusal y la urticaria crónica. La rinitis alérgica (RA) representa un problema de salud mundial que afecta del 10 al 20% de la población total, lo que la convierte en la enfermedad crónica no transmisible de mayor prevalencia. Por lo tanto, el impacto económico de la RA provoca costos directos e indirectos significativos que no se deben subestimar y ésto sin tener en cuenta su estrecha relación con el asma. La prevalencia de asma en sujetos con rinitis alérgica oscila entre el 20 y el 40% y la prevalencia de RA en pacientes asmáticos se ha estimado en cerca de 80%. El asma afecta al 5-10% de la población general y diversos estudios han identificado a la rinitis como un factor de riesgo para el asma. En la mayor parte de los pacientes con asma ésta es de origen alérgico. En la población general, la rinosinusitis crónica afecta al 10-15% y la poliposis nasal al 2-5%, aumentando esta prevalencia hasta el 20-40% en los asmáticos, sobretodo en el asma grave y a más del 90% en los asmáticos con intolerancia a los AINES. El impacto de la rinosinusitis sobre la calidad de vida de los pacientes es superior al de la hipertensión, la diabetes y las enfermedades cardiovasculares. La urticaria crónica puede afectar al 1% de la población general causando una importante disminución de la calidad de vida al afectar el rendimiento laboral y escolar, el sueño y las actividades diarias. Debido a la gran cantidad de personas afectadas por estas enfermedades, tanto niños como adultos, la sociedad se enfrenta a un alto coste económico, tanto por sus costes directos (gasto sanitario y fármacos principalmente) como indirectos (presentismo, baja productividad y absentismo laboral).

23 julio
Grupo Menarini, a través de Área Científica Menarini, consciente de la necesidad e importancia de la Educación Médica Continua, realiza el XII Simposium Centroamericano y del Caribe de Actualización en Odontoestomatología, con el fin de transmitir el conocimiento de causa y efecto de cualquier patología oral con todos los pormenores y generar discusión de los casos odontológicos presentados, con los colegas de las diferentes áreas y especialidades médicas que darán como resultado un diagnóstico más seguro de la entidad que está en curso y un tratamiento efectivo para beneficio de la persona que merece todo el esfuerzo por parte del profesional para obtener el mejor resultado del paciente.

20 julio
El punto de venta farmacéutico es hoy en día uno de los mercados más competitivos a nivel centroamericano, esto ha generado que las farmacias busquen diferenciarse de sus competidores no solo a nivel de precios sino a través del servicio al cliente y el valor agregado que invite al consumidor a vivir una experiencia de compra diferenciada.

25 junio
El dolor postoperatorio es en la actualidad uno de los problemas asistenciales más comunes en los hospitales, a pesar de los medios terapéuticos que se disponen para su tratamiento. Incide en la morbimortalidad y en la satisfacción de los pacientes e incrementa los costos hospitalarios. Es por ello que en este XIII Simposium Centroamericano y Del Caribe Online de Actualización de Dolor Postoperatorio abordaremos temas útiles para la formación médica continua, para afianzar la protocolización según información científica y experiencia clínica de expertos en el manejo del dolor postoperatorio, haciendo hincapié en la necesaria colaboración multidisciplinaria de médicos especialistas para una mejor recuperación del paciente

22 junio
Una de las complicaciones en nuestro sistema de salud, a pesar de los esfuerzos en la educación para su prevención y tratamiento, es la Enfermedad Tromboembólica Venosa. Los eventos tromboembólicos agrupan las embolias pulmonares (EP) y eventos de trombosis venosa profunda (TVP), sintomáticos o asintomáticos. Un hospital que protocoliza, es un hospital que protege. Uno de los objetivos de este XII Foro Multidisciplinario Online de Expertos en Tromboprofilaxis de Centroamérica y El Caribe es actualizar el conocimiento y brindar educación médica continua de tromboprofilaxis y permitir el intercambio de experiencias en la aplicación de protocolos apegados a las guías internacionales, para que la embolia pulmonar deje de ser la causa principal de muerte prevenible en los hospitales

22 julio
La comunicación entre clínicos de diferentes especialidades ha cambiado en los últimos años, con una gran mejora al respecto. En la actualidad, existen diferentes herramientas y tecnologías que nos ayudan a interactuar y compartir entre los diferentes equipos de trabajo clínico y de laboratorio.

15 junio
En la actualidad la transformación e innovación digital es un tema recurrente en todo el mundo. Todos los sectores y ámbitos sociales se ven impactados con mayor o menor intensidad por esta ola transformadora de la cual los principales medios de comunicación de todo el mundo están hablando. Y por supuesto, la transformación digital también ha llegado al sector salud. A veces, incluso, sin que los propios actores sean muy conscientes del impacto y profundidad de los cambios que vienen. En este sentido es importante analizar y reforzar la dimensión real del concepto de transformación digital, siendo un proceso continuo y complejo, multidimensional, vinculado a factores sociales, económicos y tecnológicos que trascienden las paredes de las clínicas y hospitales e impacta la esencia misma de lo que se es y se hace en la actualidad. La transformación e innovación digital así como la tecnología en el sector salud, lejos de alejar, puede y debe humanizar “encuentros” y facilitar intercambios médico-paciente, con comunicación segura y confidencial médico-paciente

22 enero
La enfermedad tromboembólica venosa (ETV), que comprende la Trombosis Venosa Profunda (TVP) y la Embolia Pulmonar (EP), es un proceso que se ha considerado grave y potencialmente mortal, el cual se caracteriza por la aparición de un trombo, inicialmente, en el interior del sistema venoso profundo, que puede crecer y fragmentarse. Esta Jornada de Abordaje de la ETV, la cual cuenta con el aval de la Asociación Hondureña y la Federación Centroamericana y del Caribe de Neumología y Cirugía de Tórax, busca reunir a expertos de distintas especialidades y de diferentes países de nuestra región, para compartir sus experiencias y recomendaciones en torno al manejo integral de esta enfermedad durante su estadía y después del alta hospitalaria.

28 enero
Grupo Menarini, a través de Área Científica Menarini, consciente de la necesidad e importancia de la Educación Médica Continua, desarrolla la actividad científica PROTECCIÓN Y REPARACIÓN DE LOS TEJIDOS DE LA MUCOSA BUCAL, con el fin de transmitir el conocimiento de causa y efecto de cualquier patología oral con todos los pormenores y generar discusión, de los casos presentados, con los colegas de las diferentes áreas y especialidades médicas que dará como resultado un diagnóstico más seguro y un tratamiento efectivo para beneficio del paciente.

29 enero
Como parte del continuo proceso de crecimiento y aprendizaje Grupo Menarini a través de Área Científica Menarini Online organiza y patrocina la actividad científica: RECOMENDACIONES TERAPÉUTICAS PARA LOS PROBLEMAS DERIVADOS DE LA DENTICIÓN EN LOS BEBÉS, con la cual se busca establecer y facilitar el conocimiento de cualquier patología oral con todos los pormenores y generar discusión de los casos presentados con los excelentes conferencistas de las diferentes especialidades médicas y odontológicas que dará como resultado un diagnóstico más seguro y un tratamiento efectivo para beneficio en el desarrollo del bebé.

16 julio
Este curso está enfocado en el abordaje multidisciplinario de las crisis hipertensivas para fortalecer los conocimientos sobre el diagnóstico, tratamiento y seguimiento adecuado de esta patología, tanto en el paciente adulto como la mujer embarazada, así como promover la conciencia sobre la importancia del buen control de la presión arterial, que es el principal factor que genera crisis hipertensiva, así como la modificación de los hábitos de vida dirigida a reducir los factores de riesgo que conforman la enfermedad cardiovascular.

23 febrero

09 febrero
Las enfermedades cardiovasculares siguen siendo al día de hoy la primera causa de mortalidad en pleno siglo XXI. Nuestra población latinoamericana presenta múltiples factores de riesgo cardiovascular tales como hipertensión, hiperlipidemias, obesidad, diabetes, sedentarismo, tabaquismo, alcoholismo entre otras. Este II Simposium de Síndrome Coronario Crónico 2021 virtual de nuestra plataforma de Área Científica Menarini Online tiene como objetivo presentar los aspectos más actualizados en el diagnóstico y tratamiento de esta condición, especialmente el papel de Ranolazina como parte fundamental del tratamiento médico óptimo.

02 junio
Hablar sobre problemas sexuales es siempre complicado y provoca vergüenza y ansiedad, especialmente para los hombres. Sin embargo, es quizás aún más difícil porque esto no es siempre visto como un problema médico real con una causa y tratamientos viables. En cualquier caso, la consulta con un médico es recomendada para un correcto diagnóstico y tratamiento.

09 junio
La calidad asistencial hospitalaria, se define como “el conjunto de propiedades y características de un servicio que le confiere su aptitud para satisfacer las necesidades expresadas o implícitas de los pacientes”. Conseguir un nivel de calidad óptimo equivale, por tanto, a desarrollar grados de efectividad, de eficiencia, de adecuación y de calidad científico-técnica en la práctica asistencial que satisfagan por igual a administradores, profesionales y usuarios. Además se debe proveer la elaboración y cumplimiento de protocolos que prevengan riesgos y complicaciones a los pacientes hospitalizados, tales como: tromboprofilaxis, tratamiento de la enfermedad tromboembólica venosa en su fase aguda y a largo plazo, y manejo adecuado del dolor. Al realizar el V Simposium Centroamericano y del Caribe de Enfermería de Hospital en su versión Online, deseamos lograr un consenso para fortalecer el manejo de tromboprofilaxis y protocolización del manejo del dolor en los diferentes escenarios hospitalarios, fundamentados en experiencia clínica y científica, aportando como Grupo Menarini formación científica de alto nivel y temas de vanguardia al gremio de enfermería, comprometido con la calidad asistencial, en el abordaje terapéutico del paciente hospitalizado

09 marzo
La atención primaria de salud es la asistencia sanitaria esencial accesible a todos los individuos adoptando una visión holística de la salud que va mucho más allá del limitado modelo médico. El X Simposium Centroamericano y del Caribe de Actualización en Atención Primaria, tiene como objetivo facilitar al profesional de la salud, la capacidad de comprender de manera directa la complejidad de las patologías que aquejan a nuestra sociedad, integrando también patologías de la cavidad oral y del área de neurociencias de tal forma que pueda poner en práctica el correcto abordaje y tratamiento, pero ante todo la Prevención.

20 marzo

27 julio
Las hepatitis virales, especialmente hepatitis B y hepatitis C, conforman un importante problema de salud pública a nivel mundial, con importantes repercusiones económicas para nuestra región. La detección, el diagnóstico, reporte y enlace al tratamiento de las hepatitis virales se limita a algunos especialistas del sector privado y público, que cuentan con las herramientas de diagnóstico y la formación clínica para hacerlo, pero la tarea en este tema en nuestra región es un reto formidable, que puede empezar a ser abordado con educación a los profesionales de la salud así como promover un reporte y seguimiento adecuado en las entidades que brindan estos servicios de salud.

11 agosto
La farmacia hospitalaria es el servicio de atención médica que se encarga de elegir, preparar, almacenar, combinar y dispensar medicamentos y productos sanitarios, asesorando a profesionales de la salud y pacientes sobre su uso seguro, efectivo y eficiente. Es la profesión que se esfuerza por mantener y mejorar continuamente la gestión de medicamentos y la atención farmacéutica de los pacientes con los más altos estándares en un entorno hospitalario. En esta ocasión, le presentamos el X SIMPOSIUM CENTROAMERICANO Y DEL CARIBE DE FARMACÉUTICOS DE HOSPITAL donde se amplían las áreas terapéuticas en las que profundizaremos con excelencia científica. Los tópicos principales serán la Farmacoeconomía, farmacovigilancia, enfermedad tromboembólica venosa, uso de heparinas de bajo peso molecular y anticoagulación oral; dolor agudo, gluco corticoterapia, dolor visceral, crisis hipertensiva, hepatitis virales, entre otros.

11 junio
Este curso de actualización busco reunir a expertos de distintas especialidades y de diferentes países de nuestra región, para compartir sus experiencias y recomendaciones en torno a la anticoagulación en pacientes con COVID-19 durante su estadía hospitalaria y después del alta.

03 septiembre

26 agosto
La calidad asistencial hospitalaria, se define como “el conjunto de propiedades y características de un servicio que le confiere su aptitud para satisfacer las necesidades expresadas o implícitas de los pacientes”. Conseguir un nivel de calidad óptimo equivale, por tanto, a desarrollar grados de efectividad, de eficiencia, de adecuación y de calidad científico-técnica en la práctica asistencial que satisfagan por igual a administradores, profesionales y usuarios. Además se debe proveer la elaboración y cumplimiento de protocolos que prevengan riesgos y complicaciones a los pacientes hospitalizados, tales como: tromboprofilaxis, tratamiento de la enfermedad tromboembólica venosa en su fase aguda y a largo plazo, y manejo adecuado del dolor. Al realizar el IV Simposium Centroamericano y del Caribe de Enfermería de Hospital en su versión Online, deseamos lograr un consenso para fortalecer el manejo de tromboprofilaxis y protocolización del manejo del dolor en los diferentes escenarios hospitalarios, fundamentados en experiencia clínica y científica, aportando como Grupo Menarini formación científica de alto nivel y temas de vanguardia al gremio de enfermería, comprometido con la calidad asistencial, en el abordaje terapéutico del paciente hospitalizado.

17 septiembre
Una de las complicaciones en nuestro sistema de salud, a pesar de los esfuerzos en la educación para su prevención y tratamiento, es la Enfermedad Tromboembólica Venosa. Los eventos tromboembólicos agrupan las embolias pulmonares (EP) y eventos de trombosis venosa profunda (TVP), sintomáticos o asintomáticos Un hospital que protocoliza, es un hospital que protege. Uno de los objetivos de este XI Foro Multidisciplinario Online de Expertos en Tromboprofilaxis de Centroamérica y El Caribe es actualizar el conocimiento y brindar educación médica continua de tromboprofilaxis y permitir el intercambio de experiencias en la aplicación de protocolos apegados a las guías internacionales, para que la embolia pulmonar deje de ser la causa principal de muerte prevenible en los hospitales

16 junio
Las enfermedades cardiovasculares siguen siendo la principal causa de muertes y discapacidad en el mundo actual. El estilo de vida, el medio ambiente y la genética se presentan como factores de riesgo para el desarrollo de enfermedades cardiovasculares. Este simposio tiene como objetivo el presentar los aspectos más actualizados en cuanto a factores de riesgo, diagnóstico y tratamiento para esta condición que ha tenido mucha actualización en la última década. Tanto las guías del Colegio Americano de Cardiología como las Europeas de Cardiología, toman en cuenta al tratamiento farmacológico innovador como lo es ranolazina

13 octubre
El día 13 de octubre se celebra el Día Mundial de la Trombosis, una afección que muchas veces se ignora o no se comprende, en honor a Rudolf Virchow, pionero en la fisiopatología de la trombosis. Se realizan diversas actividades a nivel mundial para generar conciencia mundial sobre la trombosis, sus causas, factores de riesgo, signos o síntomas, así como su prevención y el tratamiento con evidencia científico-estadísticas. El Grupo Cooperativo Latinoamericano de Hemostasia y Trombosis (CLATH) con el patrocinio de Grupo Menarini Centroamérica y El Caribe, han decidido unirse a estas actividades mundiales, organizando esta actividad científica a través de la plataforma de Área Científica Menarini Online

25 agosto
El VI Simposium Centroamericano y del Caribe de Actualización en Atención Farmacéutica en su versión Online, dirige su máximo esfuerzo en la actualización del personal de farmacia de los principales retailers farmacéuticos de la región y del personal de contacto con el usuario final, proporcionando un medio por el cual el asistente reciba información técnico científica encaminada a la profesionalización de la administración de categorías, la mejora de habilidades comerciales, servicio al cliente y la adecuada orientación y utilización de medicamentos de calidad.

28 octubre
La práctica odontológica es dinámica y con el tiempo sigue evolucionando, es por ello que la enseñanza es un aprendizaje continuo. Las actividades de educación médica-odontológica continua son vitales para el desarrollo profesional del odontólogo, sin olvidar al estudiante de los últimos años de la carrera, a quienes les permite estar al corriente de los avances y novedades de la odontología moderna, mantener los conocimientos y la experiencia necesaria para prestar una atención de alta calidad a sus pacientes. Es por ello que todos los futuros odontólogos tienen la responsabilidad consigo mismos y con su profesión, de mantener altos niveles de formación y actualización. El I Congreso Estudiantil Centroamericano y del Caribe Interfacultades de Odontología, una iniciativa de Área Científica Menarini, busca dar respuesta a las necesidades de formación de los Futuros Odontólogos y ampliar los conocimientos de las técnicas y protocolos clínicos más recientes en Odontología Digital.

27 noviembre
La Nutrición Clínica en el contexto de la pandemia por Covid-19 ha debido adaptarse a un nuevo escenario médico. Muchos pacientes han necesitado tratamiento médico nutricional. En este sentido, resulta fundamental la participación coordinada de los miembros de las unidades de nutrición y otros servicios incluyendo médicos, dietistas, nutricionistas y farmacéuticos que desempeñan un papel muy relevante en esta crisis. La alimentación juega un papel primordial en la prevención y/o disminución de los efectos producidos por Covid-19, ya que al tener una dieta adecuada durante la cuarentena contribuye a controlar las comorbilidades presentes, reducir el estrés y aminorar algunos de los síntomas gastrointestinales que se han relacionado con Covid-19.

10 noviembre
La población pediátrica se encuentra expuesta a diferentes tipos de ambientes, los cuales tienen una profunda influencia en su crecimiento y desarrollo. Las exposiciones medioambientales, son tanto nocivas como beneficiosas para la salud, y no funcionan por separado, sino que interactúan como determinantes sociales y nutricionales de la salud, para influir en el bienestar de cada uno de ellos. Sean cuales sean los recursos naturales y el nivel de desarrollo económico, para todos los países y todas las comunidades, la población pediátrica representa el futuro, el cual debe cultivarse y protegerse. Por lo cual en el I Simposium Centroamericano y del Caribe Multidisciplinario de Actualización en Pediatría, se abordarán temas de relevancia científica y actual en el manejo de patologías presentes en el consultorio como lo son: las enfermedades respiratorias, alérgicas y gastrointestinales, además del adecuado manejo de la salud bucal en el paciente pediátrico.

06 noviembre
El ser humano ha venido desarrollando a través de la historia, diferentes estructuras sociales, desde tribus hasta grandes imperios, basado esto en el pensamiento y la conducta lo que a su vez ha dado lugar a la formación de diversas culturas y al desarrollo de nuevas tecnologías. Estamos pues ante un inminente encuentro entre dos ciencias que comparten mucho más de lo que teóricamente les separa, la Psiquiatría y la Neurología, dos enfoques complementarios y profundamente necesarios para la mejor comprensión de funciones complejas del Sistema Nervioso y cuya brecha es cada vez más estrecha.

02 diciembre
Grupo Menarini, a través de Área Científica Menarini, ha sido pionera en la implementación de la educación continua en las diferentes ramas que brindan atención en la salud de la población en general. Dentro de este contexto, los ginecólogos y obstetras juegan un papel fundamental en el cuidado integral de la salud de la mayor parte de la población, atendiendo las necesidades de la mujer a lo largo de su vida. Este II Simposium busca fomentar el trabajo multidisciplinario y el abordaje integral de los temas relevantes en la salud femenina, con especial énfasis en el embarazo de alto riesgo y dolor postoperatorio en los diferentes escenarios clínicos, permitiendo el intercambio de experiencias clínicas y científicas, aportando como Área Científica formación de alto nivel y temas de vanguardia

29 octubre
La comunicación entre clínicos de diferentes especialidades ha cambiado en los últimos años, con una gran mejora al respecto. En la actualidad, existen diferentes herramientas y tecnologías que nos ayudan a interactuar y compartir entre los diferentes equipos de trabajo clínico y de laboratorio. El III Curso Centroamericano y del Caribe de Diseño Digital de Sonrisa, una iniciativa de Área Científica Menarini, busca dar respuesta a las necesidades de formación de las especialidades odontológicas y ampliar conocimientos en las técnicas más recientes sobre diseño de sonrisa

15 octubre
Según la Organización Mundial de la Salud (OMS), la hepatitis, es un reto de salud mundial. Las hepatitis víricas causaron 1.34 millones de muertes en 2015, comparable a la tuberculosis y mucho mayor que el VIH o la malaria. A pesar de su importancia, las hepatitis víricas han sido ignoradas, como algo prioritario en términos de salud y desarrollo hasta hace apenas unos años. Pero gracias a la resolución de la Agenda para el Desarrollo Sostenible 2030, la enfermedad pasó a tener la importancia que merecía y se decretó una estrategia global para su eliminación. Según la OMS, se pretende para el 2030 lograr: 90% de las personas diagnosticadas, 80% tratadas y reducir la mortalidad en un 65% Es bien conocido que España, es un país referente en el abordaje de los pacientes con Hepatitis C, desde la implementación del “Plan Estratégico para el Abordaje de la Hepatitis C, en enero del 2015. Esta fue una iniciativa pionera, tanto a nivel europeo como a nivel mundial, ha logrado tratar a más del 40% del número estimado de pacientes. Parte importante del desarrollo de este plan, ha sido la priorización en la identificación de pacientes no diagnosticados. En la actualidad, cuentan con un importante arsenal terapéutico para curar esta enfermedad.

21 agosto
El dolor es uno de los problemas sanitarios más importantes del siglo XXI y su tratamiento sigue siendo uno de los desafíos clínicos que con mayor frecuencia enfrentan los médicos. Las repercusiones del dolor producen efectos de alcance social y económico de la sociedad en su conjunto, afectando a las personas en el mercado laboral y en el uso de los recursos asistenciales. En los últimos veinte años, el tratamiento del dolor postoperatorio ha cambiado de forma radical debido a la transformación progresiva de una atención a tiempo parcial en la sala de reanimación postquirúrgica, con programas terapéuticos multimodales y en el que están implicadas varias especialidades médicas. El dexketoprofeno y el tramadol presentan distintos mecanismos y sitios de acción, además de diferentes perfiles farmacocinéticos, por lo que se prevé que la combinación de dexketoprofeno con tramadol proporcione un efecto analgésico caracterizado por un inicio rápido (debido al DKP) y una duración sostenida (debida al TRAM).

01 octubre
El comercio minorista es uno de los sectores más importantes y dinámicos de la economía de cualquier país, ya que a través de él se operan volúmenes que hacen que tenga un peso relevante dentro del producto interno bruto, por lo cual se hace necesario que los jugadores que en él se desempeñan se adapten a los continuos cambios que sufren. Por otro lado, en el mercado farmacéutico, existe una creciente multiplicación de proveedores, marcas y presentaciones, con la que se genera la necesidad de colaboración entre proveedores y distribuidores, introduciendo de este modo a la relación netamente comercial, otros elementos que buscan beneficio mutuo como la información relevante del consumidor y comprador, la infraestructura del punto de venta y el talento humano capacitado para la atención y las demandas de los consumidores.

20 agosto
El papel del Ácido Úrico Sérico (AUs) como factor de riesgo para la enfermedad cardiovascular (CV) ha sido ampliamente debatido durante muchos años. En particular, la mayor parte de la evidencia sobre el papel patogénico del ácido úrico en la enfermedad CV se ha logrado en la población de pacientes con hiperuricemia o gota severa, mientras que la relevancia establecida en pacientes con niveles séricos moderadamente elevados de ácido úrico ha sido muy baja. El ácido úrico sérico había sido descrito como un importante factor de riesgo independiente de la enfermedad CV y la enfermedad renal en la población en general, así como en pacientes con gota, hipertensión, insuficiencia cardíaca, o diabetes.

03 octubre
El V Simposium Centroamericano y del Caribe de Actualización en Atención Farmacéutica en su versión Online, dirige su máximo esfuerzo en la actualización del personal de farmacia de los principales retailers farmacéuticos de la región y del personal de contacto con el usuario final, proporcionando un medio por el cual el asistente reciba información técnico científica encaminada a la profesionalización de la administración de categorías, la mejora de habilidades comerciales, servicio al cliente y la adecuada orientación y utilización de medicamentos de calidad. El temario de este V Simposium ha sido enfocado para ser expuesto por ponentes profesionales del ámbito de los negocios y profesionales de la salud; líderes de opinión en sus áreas y que por su experiencia y trayectoria, pueden compartir con los asistentes al evento información vital y con altos estándares técnico-científicos. Esperamos de esta manera colaborar con el enriquecimiento intelectual del gremio farmacéutico y asistentes de farmacia para garantizar el profesionalismo y una dispensación de medicamentos responsable.

16 octubre
El campo de la gastroenterología está evolucionando con nuevos descubrimientos y avances en el tratamiento de las Enfermedades Digestivas y Hepáticas, haciendo mandatorio que todos los Profesionales de la Salud especializados en esta área estén actualizados y que los Expertos en el tema compartan su conocimiento y tengan una opinión crítica sobre su trabajo. Las Enfermedades Digestivas y Hepáticas son trastornos del tracto gastrointestinal y hepático que si se vuelven crónicas pueden llegar a tener un carácter permanente, que causa alguna incapacidad residual, que requiere un largo período de tratamiento o cuidado y un enfoque multidisciplinario. Por todo ello, cualquier enfermedad digestiva y hepática como: malabsorción por deficiencias enzimáticas, desórdenes gastroesofágicos y desórdenes intestinales, infección crónica por VHC y VHB, puede tener una limitación persistente en la salud del paciente que la padece, afectando su estado completo de bienestar físico, mental y social.

21 julio
Las enfermedades alérgicas afectan actualmente a más de 1,000 millones de personas en el mundo y su prevalencia continúa en aumento, esperándose duplicar o incluso triplicar esta cifra para el año 2,050 (50% de la población). Entre las enfermedades alérgicas y sus asociaciones más comunes se encuentran la rinitis/conjuntivitis y asma alérgica, la rinosinusitis con o sin poliposis nasosinusal y la urticaria crónica. La rinitis alérgica (RA) representa un problema de salud mundial que afecta del 10 al 20% de la población total, lo que la convierte en la enfermedad crónica no transmisible de mayor prevalencia. Por lo tanto, el impacto económico de la RA provoca costos directos e indirectos significativos que no se deben subestimar y ésto sin tener en cuenta su estrecha relación con el asma. La prevalencia de asma en sujetos con rinitis alérgica oscila entre el 20 y el 40% y la prevalencia de RA en pacientes asmáticos se ha estimado en cerca de 80%. El asma afecta al 5-10% de la población general y diversos estudios han identificado a la rinitis como un factor de riesgo para el asma. En la mayor parte de los pacientes con asma ésta es de origen alérgico. En la población general, la rinosinusitis crónica afecta al 10-15% y la poliposis nasal al 2-5%, aumentando esta prevalencia hasta el 20-40% en los asmáticos, sobretodo en el asma grave y a más del 90% en los asmáticos con intolerancia a los AINES. El impacto de la rinosinusitis sobre la calidad de vida de los pacientes es superior al de la hipertensión, la diabetes y las enfermedades cardiovasculares. La urticaria crónica puede afectar al 1% de la población general causando una importante disminución de la calidad de vida al afectar el rendimiento laboral y escolar, el sueño y las actividades diarias. Debido a la gran cantidad de personas afectadas por estas enfermedades, tanto niños como adultos, la sociedad se enfrenta a un alto coste económico, tanto por sus costes directos (gasto sanitario y fármacos principalmente) como indirectos (presentismo, baja productividad y absentismo laboral).

04 agosto
La hipertensión arterial y la cardiopatía isquémica, constituyen la principal causa de mortalidad en el mundo y por ello es considerada la pandemia del tercer milenio. Si bien en la actualidad se hace mucho hincapié en el riesgo cardiovascular general derivado de la combinación de una Presión Arterial (PA) elevada, la presencia de factores de riesgo cardiovascular, la diabetes mellitus, el síndrome metabólico y el daño orgánico subclínico o establecido, el nivel de la PA por sí sola está íntimamente relacionado con el riesgo de mortalidad por motivos cardiovasculares. La Sociedad Europea de Hipertensión (ESH), la Sociedad Interamericana de Hipertensión (ISH) y la Sociedad Latinoamericana de Hipertensión (LASH) conscientes de la necesidad de la educación médica continua de calidad en el gremio médico y teniendo en cuenta que tiene su núcleo fundamental en el autoaprendizaje individual, realiza este Master Course Online en Hipertensión y Riesgo Cardiovascular, para compartir el conocimiento y crear una relación científica entre las Sociedades y los especialistas de esta región en la actualización del diagnóstico y tratamiento de la hipertensión arterial y sus factores de riesgo, para contribuir a la prevención de la enfermedad cardiovascular en Centroamérica y el Caribe.

30 octubre
Las enfermedades bucodentales han afectado a la humanidad desde sus mismos inicios, en especial el dolor agudo dentario producido por una caries profunda o un absceso periapical. Técnicas curativas y rehabilitadoras han sido practicadas por muchos médicos a lo largo de la historia. La práctica de la odontología es dinámica y sigue evolucionando y es por esto que la enseñanza odontológica es un aprendizaje continuo. Las actividades de educación médico/odontológica continua son indispensables para el desarrollo profesional del odontólogo general y especialista, permitiendo estar al corriente del progreso de la odontología clínica, mantener los conocimientos y la experiencia necesaria para prestar una atención de alta calidad. Es por esto que todos los odontólogos generales y especialistas tienen la responsabilidad consigo mismos y con la profesión de mantener altos niveles de formación odontológica y de actualización

14 julio
La importancia de las enfermedades alérgicas radica en su propia naturaleza. Son procesos muy frecuentes, que afectan al paciente, en las fases de su vida en las que la producción laboral o académica es más intensa, además interfieren de forma significativa en las actividades cotidianas y perturban el sueño a menudo. Nuestro XIII Simposium Centroamericano y Del Caribe Multidisciplinario Online de Enfermedades Alérgicas y de Piel está orientado al manejo integral de las enfermedades alérgicas, enfocándose principalmente en Rinitis y Urticaria, mediante presentaciones y debates de temas de actualidad.

11 agosto
Las enfermedades cardiovasculares constituyen una de las causas más importantes de discapacidad y muerte prematura en todo el mundo. El problema subyacente es la aterosclerosis, que progresa a lo largo de los años, de modo que cuando aparecen los síntomas, generalmente a mediana edad, suele estar en una fase avanzada. Los episodios coronarios y cerebrovasculares agudos se producen de forma repentina y conducen a menudo a la muerte antes de que pueda brindarse la atención médica requerida. Debido a la relevancia epidemiológica de las enfermedades cardiovasculares y considerando que su morbilidad representa un alto costo para nuestros países y las familias afectadas, el objetivo de este XIV Simposium Centroamericano y del Caribe Online de Actualización en Enfermedad Cardiovascular es fortalecer los conocimientos sobre las enfermedades cardiovasculares, así como promover la conciencia sobre la importancia de la modificación de los hábitos de vida dirigida a reducir los factores de riesgo que conforman la enfermedad cardiovascular.

14 febrero
La Atención Primaria de Salud es la asistencia sanitaria esencial accesible a todos los individuos y familias de la comunidad a través de medios aceptables para ellos, con su plena participación y a un costo asequible para la comunidad y el país. El VIII Simposium Centroamericano y del Caribe de Actualización en Atención Primaria tiene como objetivo facilitar al Médico de Atención Primaria la capacidad de comprender de manera directa la complejidad de las patologías que aquejan a nuestra sociedad, para que estas mismas sean puestas en práctica en el nivel de atención de mayor importancia en todo sistema de salud: La Prevención.

24 noviembre
El servicio de Emergencia es aquel ambiente dentro de un centro hospitalario, donde se prestan servicios de salud durante las veinticuatro horas del día a pacientes que demandan atención inmediata. En esta época de pandemia en donde todos hemos aprendido a volvernos a inventar, exige que tengamos conocimientos diversos tanto científicos como personales y es por esto que tenemos a bien ofrecerles el I SIMPOSIUM CENTROAMERICANO Y DEL CARIBE DE EMERGENCIAS, en donde se disertará durante tres sesiones, algunos de los motivos de consulta más frecuentes a nivel hospitalario, con ponentes de referencia que apoyarán la educación médica continua.

11 octubre
La fibrilación auricular (FA) es la arritmia cardíaca más frecuente. La prevalencia actual estimada de la FA en los adultos se sitúa entre el 2% y el 4%, y se espera que se multiplique por 2.3, debido a la mayor longevidad de la población general y a la intensificación de la búsqueda de FA no diagnosticada.1 Este I Simposium Centroamericano y del Caribe de Actualización Integral en Anticoagulación tiene como objetivo concientizar acerca de la carga de mortalidad causada por la trombosis en general, la necesidad de acción y, más específicamente, la amenaza no reconocida y las graves consecuencias de la ETV y la FA. Así mismo, los investigadores y ponentes principales a nivel mundial de estas condiciones, compartirán su experiencia en distintos escenarios que permitan una actualización importante en su abordaje integral.

27 octubre
Los cambios estructurales y funcionales asociados con el envejecimiento cardiovascular, disminuyen de forma significativa el umbral en el cual las enfermedades cardíacas llegan a ser evidentes, por esta razón el II Foro Centroamericano y del Caribe de Geriatría, organizado en conjunto con la Asociación Guatemalteca de Medicina del Adulto Mayor (AGMA), se llama Cardio Geriatría, ¡un reto! que es la práctica de la medicina cardiovascular adaptada al anciano

16 septiembre
La Nutrición Clínica es la disciplina que se ocupa de la prevención, diagnóstico y tratamiento de los cambios nutricionales y metabólicos relacionados con enfermedades agudas o crónicas y con condiciones causadas por un exceso o falta de energía. En el campo científico, la nutrición se ocupa de todos los aspectos relacionados con la interacción entre alimentos, nutrientes, vida, salud y enfermedad, teniendo como objeto de estudio, el proceso por el cual un organismo ingiere, absorbe, transporta, utiliza y excreta sustancias alimenticias.

08 noviembre
La población pediátrica se encuentra expuesta a diferentes tipos de ambientes, los cuales tienen una profunda influencia en su crecimiento y desarrollo. Las exposiciones medioambientales, son tanto nocivas como beneficiosas para la salud, y no funcionan por separado, sino que interactúan como determinantes sociales y nutricionales de la salud, para influir en el bienestar de cada uno de ellos. Sean cuales sean los recursos naturales y el nivel de desarrollo económico, para todos los países y todas las comunidades, la población pediátrica representa el futuro, el cual debe cultivarse y protegerse. Por ello, la Organización Mundial de la Salud declara que el crecimiento y desarrollo infantil saludable debe ser una de las máximas prioridades para todas las sociedades. La población pediátrica es especialmente vulnerable frente a enfermedades que son prevenibles o tratables en su mayoría.

19 octubre
El ser humano ha venido desarrollando a través de la historia diferentes estructuras sociales, desde tribus hasta grandes imperios, basado esto en el pensamiento y la conducta lo que a su vez ha dado lugar a la formación de diversas culturas y al desarrollo de nuevas tecnologías. Estamos pues ante un inminente encuentro entre dos ciencias que comparten mucho más de lo que teóricamente les separa, la psiquiatría y la neurología, dos enfoques complementarios y profundamente necesarios para la mejor comprensión de funciones complejas del sistema nervioso y cuya brecha es cada vez más estrecha.

15 noviembre
Las mujeres tienen necesidades de salud únicas, como el cuidado previo, durante y posterior al embarazo y la menopausia, e, incluso, padecimientos que pueden afectar su calidad de vida de manera diferente, como el Síndrome de Anticuerpos Antifosfolípidos, las Hepatitis Virales Crónicas, y el manejo del dolor ante las distintas comorbilidades. Este III Simposium busca fomentar el trabajo multidisciplinario y el abordaje integral de los temas relevantes en la salud femenina, con especial énfasis en el embarazo de alto riesgo y dolor postoperatorio en los diferentes escenarios clínicos, permitiendo el intercambio de experiencias clínicas y científicas, aportando como Área Científica formación de alto nivel y temas de vanguardia.

04 octubre
Según la Organización Mundial de la Salud (OMS), la hepatitis, es un reto de salud mundial. Las hepatitis víricas causaron 1.34 millones de muertes en 2015, comparable a la tuberculosis y mucho mayor que el VIH o la malaria. A pesar de su importancia, las hepatitis víricas han sido ignoradas, como algo prioritario en términos de salud y desarrollo hasta hace apenas unos años. Pero gracias a la resolución de la Agenda para el Desarrollo Sostenible 2030, la enfermedad pasó a tener la importancia que merecía y se decretó una estrategia global para su eliminación. Según la OMS, se pretende para el 2030 lograr: 90% de las personas diagnosticadas, 80% tratadas y reducir la mortalidad en un 65%. Es por esto, que se consideró de vital importancia en nuestra región centroamericana, crear un foro de expertos en el abordaje de la infección crónica por hepatitis C y por lo tanto traducirlos en posibles estrategias de erradicación, permitiéndonos incidir y debatir en la importancia que tiene, tanto para los pacientes como para el sistema sanitario. Una vez que el acceso universal al tratamiento en nuestros países es una realidad, hay que priorizar la identificación de pacientes no diagnosticados, ya que “existe un elevado número de personas que desconocen estar infectados y permanecen sin diagnosticar hasta que presentan síntomas graves”. Por lo tanto, se estima que los procesos de cribado a gran escala son imprescindibles para que la hepatitis C pase a ser una enfermedad prioritaria y podamos eliminarla, sobre todo en países como los nuestros, en donde no se cuenta con un registro real de la prevalencia de la enfermedad.

07 marzo
La importancia de las enfermedades alérgicas radica en su propia naturaleza. Son procesos muy frecuentes, que afectan al paciente, en las fases de su vida en las que la producción laboral o académica es más intensa, además interfieren de forma significativa en las actividades cotidianas y perturban el sueño a menudo. El XII Simposium Centroamericano y Del Caribe Multidisciplinario de Enfermedades Alérgicas y de Piel está orientado al manejo integral de las enfermedades alérgicas, enfocándose principalmente en Rinitis y Urticaria, mediante presentaciones y debates de temas de actualidad.

04 abril
El daño a órgano blanco por factores de riesgo, como hipertensión y diabetes, se encuentra estrechamente relacionado con los efectos patológicos del sistema renina angiotensina-aldosterona y los efectos de su componente más importante, la angiotensina II. Debido a la relevancia epidemiológica de las Enfermedades Cardiovasculares y considerando que su morbilidad representa un alto costo para nuestros países y las familias afectadas, el objetivo de este Simposium es fortalecer los conocimientos sobre las Enfermedades Cardiovasculares, así como promover la conciencia sobre la importancia de la modificación de los hábitos de vida dirigida a reducir los factores de riesgo que conforman la Enfermedad Cardiovascular.

07 octubre
El campo de la gastroenterología está evolucionando con nuevos descubrimientos y avances en el tratamiento de las enfermedades digestivas y hepáticas, haciendo mandatorio que todos los profesionales de la salud especializados en esta área estén actualizados y que los expertos en el tema compartan su conocimiento y tengan una opinión crítica sobre su trabajo. Este IX Simposium Centroamericano y del Caribe de Actualización en Enfermedades Digestivas y Hepáticas en su versión online tiene como objetivo promover y facilitar a los médicos, educación médica continua, en el ámbito de diversas enfermedades digestivas y hepáticas y de los avances en su manejo clínico y tratamiento que permitan una actualización importante en gastroenterología y hepatología.

29 septiembre
La Sociedad Internacional para el estudio del Dolor (IASP) por sus siglas en inglés: El dolor es: “una experiencia sensorial y emocional desagradable, asociada a un daño tisular real o potencial o descrita en términos de tal daño”. La fiebre ha sido siempre reconocida como una de las más comunes e indiscutibles manifestaciones de enfermedad, tanto por médicos, padres o cualquier otra persona. De igual forma, la antipiresis es una de las más antiguas, extendidas y conocidas prácticas terapéuticas. Es por ello que la fiebre per se es causa de un elevado porcentaje de llamadas y visitas a los médicos e incluso puede ser considerada como un problema debilitante aun en ausencia de otros signos y síntomas. Grupo Menarini, es pionera en comercializar Mencetamol el primer Paracetamol bebible en formato stick pack, con un rápido inicio de acción en el manejo del dolor agudo de leve a moderado y el control de la fiebre.

23 septiembre
Tenemos el placer de invitarle a participar en el VIII Master Course Centroamericano y del Caribe de Patología Quirúrgica Musculoesquelética. Un año más, Área Científica Menarini ha tomado la iniciativa de patrocinar este proyecto. Se trata de una cita para la actualización académica y también una oportunidad de intercambiar experiencias con otros especialistas. Para ello contaremos con experimentados cirujanos que mantendrán la cercanía necesaria para que la reunión sea de lo más provechosa e interesante para todos. Sólo nos queda animarle a conocer nuestra manera de emplear las técnicas descritas en los temas seleccionados y a participar de la enriquecedora discusión que se establecerá dentro de esta reunión, que hemos preparado con nuestra mayor ilusión.

23 mayo
La calidad asistencial hospitalaria, se define como “el conjunto de propiedades y características de un servicio que le confiere su aptitud para satisfacer las necesidades expresadas o implícitas de los pacientes”. Conseguir un nivel de calidad óptimo equivale, por tanto, a desarrollar grados de efectividad, de eficiencia, de adecuación y de calidad científico-técnica en la práctica asistencial que satisfagan por igual a administradores, profesionales y usuarios. Además se debe proveer la elaboración y cumplimiento de protocolos que prevengan riesgos y complicaciones a los pacientes hospitalizados, tales como: tromboprofilaxis y manejo adecuado del dolor. Se logrará la calidad máxima de nuestro servicio si las personas que realizan la asistencia al enfermo tienen conocimientos científicos adecuados permanentemente actualizados. Es por ello que Área Científica de Grupo Menarini ha organizado el III Simposium Centroamericano y Del Caribe de Enfermería de Hospital.

20 junio
El dolor postoperatorio es en la actualidad uno de los problemas asistenciales más comunes en los hospitales, a pesar de los medios terapéuticos que se disponen para su tratamiento. Incide en la morbimortalidad y en la satisfacción de los pacientes e incrementa los costos hospitalarios. Es por ello que en este Simposium de actualización de dolor postoperatorio abordaremos temas útiles para la formación médica continua, para afianzar la protocolización según información científica y experiencia clínica de expertos en el manejo del dolor postoperatorio, haciendo hincapié en la necesaria colaboración multidisciplinaria de médicos especialistas para una mejor recuperación del paciente.

23 agosto
El comercio minorista es uno de los sectores más importantes y dinámicos de la economía de cualquier país, ya que a través de él se operan volúmenes que hacen que tenga un peso relevante dentro del producto interno bruto, por lo cual se hace necesario que los jugadores que en él se desempeñan se adapten a los continuos cambios que sufren.

23 julio

24 julio
La comunicación entre clínicos de diferentes especialidades ha cambiado en los últimos años, con una gran mejora al respecto. En la actualidad, existen diferentes herramientas y tecnologías que nos ayudan a interactuar y compartir entre los diferentes equipos de trabajo clínico y de laboratorio. El II Curso Centroamericano y del Caribe de Diseño Digital de Sonrisa, una iniciativa de Área Científica Menarini, busca dar respuesta a las necesidades de formación de las especialidades odontológicas y ampliar conocimientos en las técnicas más recientes sobre diseño de sonrisa.

25 julio
Las enfermedades bucodentales han afectado a la humanidad desde sus mismos inicios, en especial el dolor agudo dentario producido por una caries profunda o un absceso periapical. Técnicas curativas y rehabilitadoras han sido practicadas por muchos médicos a lo largo de la historia. Grupo Menarini, a través de Área Científica Menarini, consciente de la necesidad e importancia de la Educación Médica Continua, realiza la novena edición del X Simposium Centroamericano y del Caribe de Actualización en Odontoestomatología, con el fin de transmitir el conocimiento de causa y efecto de cualquier patología oral con todos los pormenores y generar discusión de los casos odontológicos presentados, con los colegas de las diferentes áreas y especialidades médicas que darán como resultado un diagnóstico más seguro de la entidad que está en curso y un tratamiento efectivo para beneficio de la persona que merece todo el esfuerzo por parte del profesional para obtener el mejor resultado, el paciente.

08 agosto
El ser humano ha venido desarrollando a través de la historia, diferentes estructuras sociales, desde tribus hasta grandes imperios, basado esto en el pensamiento y la conducta lo que a su vez ha dado lugar a la formación de diversas culturas y al desarrollo de nuevas tecnologías. Desde tiempos inmemoriales ha existido la necesidad en el ser humano de poder explicar y comprender de forma adecuada lo que se ha llegado a conocer como la mente e invariablemente poder asociarla a un órgano específico, en este caso es el cerebro al que se ha propuesto y estudiado como la estructura en la cual esta se asienta la misma, principalmente a partir de Anaxágoras de Klazomene (500-428 a.C.) quien propuso que el cerebro era el órgano de la mente y como este regula la imaginación, el razonamiento y la memoria (componentes básicos del intelecto según Galeno).

22 agosto
Grupo Menarini a través de Área Cientíca Menarini, ha sido pionera en la implementación de la educación continua en las diferentes ramas que brindan atención en salud de la población en general. Dentro de este contexto, el asistente de farmacia juega un papel fundamental en el asesoramiento del paciente y del adecuado uso de los fármacos, además forma parte de la imagen del punto de venta al cual representa. El IV Simposium Centroamericano y del Caribe de Actualización en Atención Farmacéutica, dirige su máximo esfuerzo en la actualización del personal de farmacia de los principales retailers farmacéuticos de la región y del personal de contacto con el usuario nal, proporcionando un medio por el cual el asistente reciba información técnico cientíca encaminada a la profesionalización de la administración de categorías, la mejora de habilidades comerciales, servicio al cliente y la adecuada orientación y utilización de medicamentos de calidad.

26 septiembre
Las mujeres tienen necesidades de salud únicas, como el cuidado previo, durante y posterior al embarazo y la menopausia, e, incluso, padecimientos que pueden afectar su calidad de vida de manera diferente, como el Síndrome de Anticuerpos Antifosfolípidos, las Hepatitis Virales Crónicas, y el manejo del dolor ante las distintas comorbilidades. Este I Simposium busca fomentar el trabajo multidisciplinario y el abordaje integral de los temas relevantes en la salud femenina, con especial énfasis en el embarazo de alto riesgo y dolor postoperatorio en los diferentes escenarios clínicos, permitiendo el intercambio de experiencias clínicas y científicas, aportando como Área Científica formación de alto nivel y temas de vanguardia.

07 septiembre
La necesidad de tratar las enfermedades autoinmunes se enfatiza por el hecho que estas afectan a millones de personas a nivel mundial y constituyen una de las principales causas de muerte principalmente en mujeres menores de 65 años. Aunque pueden afectar a cualquiera, más mujeres que hombres padecen estas enfermedades y frecuentemente se presentan durante la etapa reproductiva. Se estima que aproximadamente del 5 al 7% de la población mundial se encuentra afectada por las enfermedades autoinmunes y que su incidencia sigue aumentando rápidamente. La gran mayoría sufre alguno de los problemas más frecuentes: artritis reumatoide, lupus eritematoso sistémico, esclerosis múltiple, diabetes juvenil tipo 1, tiroiditis y enfermedad de Crohn. Durante la última década se han hecho esfuerzos por mejorar tanto el diagnóstico como los tratamientos de estas enfermedades. Actualmente los glucocorticoides son la piedra angular en el tratamiento de muchas de las enfermedades autoinmunes y por supuesto el reto sigue siendo contar con alternativas de esta clase que brinden un mejor perfil riesgo-beneficio para el paciente y permitan el mejor control de estas enfermedades.

07 noviembre
El campo de la gastroenterología está evolucionando con nuevos descubrimientos y avances en el tratamiento de las Enfermedades Digestivas y Hepáticas, haciendo mandatorio que todos los Profesionales de la Salud especializados en esta área estén actualizados y que los Expertos en el tema compartan su conocimiento y tengan una opinión crítica sobre su trabajo. Este VII Simposium Centroamericano y del Caribe de Actualización en Enfermedades Digestivas y Hepáticas tiene como objetivo el promover y facilitar a los médicos, educación médica continua, en el ámbito de diversas enfermedades digestivas y hepáticas y de los avances en su manejo clínico y tratamiento que permitan una actualización importante en Gastroenterología y Hepatología.

10 octubre
La necesidad de tratar las enfermedades autoinmunes se enfatiza por el hecho que estas afectan a millones de personas a nivel mundial y constituyen una de las principales causas de muerte principalmente en mujeres menores de 65 años. Aunque pueden afectar a cualquiera, más mujeres que hombres padecen estas enfermedades y frecuentemente se presentan durante la etapa reproductiva. Se estima que aproximadamente del 5 al 7% de la población mundial se encuentra afectada por las enfermedades autoinmunes y que su incidencia sigue aumentando rápidamente. La gran mayoría sufre alguno de los problemas más frecuentes: artritis reumatoide, lupus eritematoso sistémico, esclerosis múltiple, diabetes juvenil tipo 1, tiroiditis y enfermedad de Crohn. En la última década surge una nueva generación de glucocorticoides del grupo oxazolínico, Deflazacort, que proporciona un perfil farmacológico y farmacocinético con mayor seguridad diferente a los glucocorticoides de primera y segunda generación, con mínima repercusión sobre el metabolismo óseo, mínima interferencia con el perfil glucídico y lipídico, menor efecto cushing, lo cual lo convierte en una alternativa de primera elección.

09 octubre

16 septiembre
La telemedicina es una tendencia creciente en el ámbito médico. Esta puede ser definida como la transmisión de información médica y la presentación de servicios de salud a través de redes de telecomunicaciones, incluyendo la transmisión de imágenes fijas, videos y otras formas de datos médicos. El desarrollo de tecnologías más eficientes en las áreas de computación y comunicaciones ha proporcionado los medios para el impulso del desarrollo de la telemedicina como herramienta de consulta y diagnóstico a distancia, enfocándose en disipar las principales preocupaciones en cuanto a la seguridad, eficacia y confiabilidad de estos sistemas.

10 agosto
La farmacoeconomía se puede definir como la descripción y el análisis de los costos de la terapia de fármacos aplicada a los sistemas de salud y a la sociedad. En forma más específica, la investigación farmacoeconómica involucra la identificación, cálculo y comparación de los costos, riesgos y beneficios de programas, servicios o terapias y la determinación de las alternativas que produzcan el mejor resultado de salud acorde a los recursos invertido. Este tema es de suma importancia en el ámbito hospitalario, especialmente en nuestros países que se ven afectados por la carencia de recursos y la optimización de los mismos es sumamente importante y necesario

01 septiembre
El IV Seminario de Medicina del Deporte y Rehabilitación busca presentar una visión integrada de varias disciplinas clínicas y científicas aplicadas al deporte, actividad propia del ser humano, que ha ganado auge por los beneficios a la salud y bienestar general que ofrece a quienes lo practican. Se debe considerar que la Medicina del Deporte tiene sus fundamentos éticos en el Código Médico del Movimiento Olímpico, que se encarga de recordar las reglas básicas de las mejores prácticas médicas en el campo del deporte. Uno de sus principales objetivos es hacer prevalecer la salud y el bienestar del deportista.

17 agosto
Actividad científica organizada y avala por la Universidad Católica Redemptoris Mater - UNICA, patrocinada por ÁREA CIENTÍFICA MENARINI.

18 agosto
Sesión científica organizada y avalada por Hospital El Pilar y patrocinada por Área Científica Menarini.

19 agosto
Capacitación para el uso de la plataforma. Funcionalidades, recorrido general e instrucciones de uso de la plataforma.

08 septiembre
Capacitación para el uso de la plataforma. Funcionalidades, recorrido general e instrucciones de uso de la plataforma.

15 septiembre
PROGRAMA DE EDUCACIÓN MÉDICA CONTINUA DEL HOSPITAL EL PILAR, PATROCINADA POR GRUPO MENARINI.

14 septiembre
REUNIÓN MENSUAL DE LA ASOCIACIÓN GUATEMALTECA DE ANESTESIOLOGÍA, REANIMACIÓN Y TRATAMIENTO DEL DOLOR - AGARTD

05 agosto
La telemedicina es una tendencia creciente en el ámbito médico. Esta puede ser definida como la transmisión de información médica y la presentación de servicios de salud a través de redes de telecomunicaciones, incluyendo la transmisión de imágenes fijas, videos y otras formas de datos médicos. Es por esto que Grupo Menarini de la mano del “Programa de Todo Corazón”, comprometidos con el gremio médico lanza el Consultorio Digital de Telemedicina “Conectados de Todo Corazón”, buscando proveer de una solución digital para la salud de las personas y una herramienta gratuita para los médicos, que cumple con todos los estándares de seguridad necesarios para una plataforma de telemedicina.

21 septiembre
PROGRAMA DE EDUCACIÓN MÉDICA CONTINUA DE LA UNIVERSIDAD NACIONAL AUTÓNOMA DE HONDURAS, ASIGNATURA Y SALUD FAMILIAR PATROCINADA POR GRUPO MENARINI.

07 octubre
CAPACITACIÓN PARA EL USO DEL CONSULTORIO MÉDICO DIGITAL.

28 septiembre
SESIÓN CIENTÍFICA ORGANIZADA POR LA SOCIEDAD PANAMEÑA DE MEDICINA GENERAL, CON LA COLABORACIÓN DE GRUPO MENARINI

19 octubre
SESIÓN CIENTÍFICA ORGANIZADA POR EL HOSPITAL REGIONAL RAFAEL HERNÁNDEZ DE PANAMÁ, CON EL PATROCINIO DE GRUPO MENARINI

21 octubre
ACTIVIDAD CIENTÍFICA ORGANIZADA POR LA ASOCIACIÓN COSTARRICENSE DE DIETISTAS Y NUTRICIONISTAS CON EL PATROCINIO DE GRUPO MENARINI.

27 octubre
Sesión Científica organizada por el Hospital el Pilar con el patrocinio de Área Científica Menarini.

07 junio
.

15 febrero
.

19 noviembre
CAPACITACIÓN PARA EL USO DEL CONSULTORIO MÉDICO DIGITAL.

22 agosto
.

23 agosto
.

06 noviembre

04 octubre

16 noviembre
Actividad científica organizada por la ASOCIACIÓN NACIONAL DE TÉCNICOS EN ASISTENCIA ODONTOLÓGICA - ANTAO y patrocinada por Área Científica Menarini.

24 noviembre
PROGRAMA DE EDUCACIÓN MÉDICA CONTINUA DEL HOSPITAL EL PILAR, PATROCINADA POR ÁREA CIENTÍFICA MENARINI.

07 febrero
Las enfermedades cardiovasculares siguen siendo al día de hoy la primera causa de mortalidad en pleno siglo XXI. Nuestra población latinoamericana presenta múltiples factores de riesgo cardiovascular tales como hipertensión, hiperlipidemias, obesidad, diabetes, sedentarismo, tabaquismo, alcoholismo entre otras. Este III Simposium de Síndrome Coronario Crónico virtual de nuestra plataforma de Área Científica Menarini Online tiene como objetivo presentar los aspectos más actualizados en el diagnóstico y tratamiento de esta condición, especialmente el papel de Ranolazina como parte fundamental del tratamiento médico óptimo.

14 marzo

26 julio

02 diciembre
CAPACITACIÓN SOBRE EL USO DE LA PLATAFORMA DE TELEMEDICINA

06 diciembre
Actividad científica organizada por el Hospital Universitario CLINIC BARCELONA y Aula Clinic, con la colaboración de URIACH y Área Científica Menarini.

21 junio

21 febrero
El programa científico se desarrollará en 5 días, de lunes a viernes; en módulos de 2 horas con 30 minutos cada día. Cada módulo consta de 4 conferencias con una duración de 30 minutos cada una y al finalizar se tendrá una sesión de preguntas y respuestas, con participación de los conferencistas.

14 marzo
La educación médica continua en atención primaria tiene como finalidad proporcionar conocimiento válido, útil y preciso que permita tomar decisiones dirigidas a prestar una asistencia sanitaria a la población, más adecuada a sus necesidades, más efectiva y de mayor seguridad y calidad.

28 marzo
El objetivo principal del II Curso de Transformación Digital es poner a disposición de los profesionales de la salud los conocimientos necesarios por parte de ponentes referentes internacionales y regionales de gran prestigio en el ámbito de la salud digital, para que comprendan y aprovechen el uso de estas herramientas y puedan gestionarlas de mejor manera, llevando su práctica clínica al siguiente nivel, dando el salto a un liderazgo digital efectivo.

22 marzo
El Master Course se realizará en 8 módulos (6 de especialidades odontológicas y 2 interdisciplinares). Iniciando en el mes de marzo y finalizando en el mes de octubre, un módulo por mes. Cada módulo está conformado de 2 a 4 sesiones que se transmitirán 1 por día; con una duración de 3 horas aproximadamente cada sesión.

17 febrero
PROGRAMA DE EDUCACIÓN MÉDICA CONTINUA ORGANIZADA POR EL HOSPITAL EL PILAR Y PATROCINADA POR ÁREA CIENTÍFICA MENARINI ONLINE.

06 abril
El papel del Ácido Úrico Sérico (AUs) como factor de riesgo para la enfermedad cardiovascular (CV) ha sido ampliamente debatido durante muchos años. En particular, la mayor parte de la evidencia sobre el papel patogénico del ácido úrico en la enfermedad CV se ha logrado en la población de pacientes con hiperuricemia o gota severa, mientras que la relevancia establecida en pacientes con niveles séricos moderadamente elevados de ácido úrico ha sido muy baja. El ácido úrico sérico había sido descrito como un importante factor de riesgo independiente de la enfermedad CV y la enfermedad renal en la población en general, así como en pacientes con gota, hipertensión, insuficiencia cardíaca, o diabetes.

25 abril
El XV Simposium Centroamericano y Del Caribe Multidisciplinario de Enfermedades Alérgicas y de Piel está orientado al manejo integral de las enfermedades alérgicas, enfocándose principalmente en rinitis y urticaria, mediante presentaciones y debates de temas de actualidad. Además, resaltará la importancia de un manejo más profundo de estas patologías a través de métodos que permitan al médico tener el control de los síntomas asociados y brindarle a cada uno de los pacientes una mejor calidad de vida. Las guías recomiendan a los antihistamínicos de segunda generación, como tratamientos de primera línea en el control de los síntomas relacionados a los procesos alérgicos. Rupatadina es un nuevo antihistamínico de segunda generación, y antagonista del PAF (factor activador plaquetario), posee un perfil bioquímico que lo hace no sedante, selectivo, de acción prolongada, que carece de efectos indeseables, lo que lo convierte en un medicamento seguro y eficaz.

02 mayo
Las enfermedades alérgicas afectan actualmente a más de 1,000 millones de personas en el mundo y su prevalencia continúa en aumento, esperándose duplicar o incluso triplicar esta cifra para el año 2,050 (50% de la población). Entre las enfermedades alérgicas y sus asociaciones más comunes se encuentran la rinitis/conjuntivitis y asma alérgica, la rinosinusitis con o sin poliposis nasosinusal y la urticaria crónica. La rinitis alérgica (RA) representa un problema de salud mundial que afecta del 10 al 20% de la población total, lo que la convierte en la enfermedad crónica no transmisible de mayor prevalencia. Por lo tanto, el impacto económico de la RA provoca costos directos e indirectos significativos que no se deben subestimar y ésto sin tener en cuenta su estrecha relación con el asma. La prevalencia de asma en sujetos con rinitis alérgica oscila entre el 20 y el 40% y la prevalencia de RA en pacientes asmáticos se ha estimado en cerca de 80%. El asma afecta al 5-10% de la población general y diversos estudios han identificado a la rinitis como un factor de riesgo para el asma. En la mayor parte de los pacientes con asma ésta es de origen alérgico. En la población general, la rinosinusitis crónica afecta al 10-15% y la poliposis nasal al 2-5%, aumentando esta prevalencia hasta el 20-40% en los asmáticos, sobretodo en el asma grave y a más del 90% en los asmáticos con intolerancia a los AINES. El impacto de la rinosinusitis sobre la calidad de vida de los pacientes es superior al de la hipertensión, la diabetes y las enfermedades cardiovasculares. La urticaria crónica puede afectar al 1% de la población general causando una importante disminución de la calidad de vida al afectar el rendimiento laboral y escolar, el sueño y las actividades diarias. Debido a la gran cantidad de personas afectadas por estas enfermedades, tanto niños como adultos, la sociedad se enfrenta a un alto coste económico, tanto por sus costes directos (gasto sanitario y fármacos principalmente) como indirectos (presentismo, baja productividad y absentismo laboral).

09 mayo
El 25 aniversario del lanzamiento de Dexketoprofeno Trometamol (Enantyum®) en Centroamérica y el Caribe (1997-2022), es fruto del continuo reconocimiento y consideración terapéutica, durante todos estos años por parte de nuestro colectivo médico y sanitario de la región. Cada forma galénica desarrollada a través de este cuarto de siglo, ha encontrado eco en el profesional de la salud, adaptándose así a las necesidades de cada perfil de los pacientes, y convirtiéndose en herramientas versátiles, eficaces y seguras para tratar el dolor agudo. Por ello queremos celebrar los 25 años de Enantyum® de la manera que más nos caracteriza: compartiendo con ustedes conocimiento científico actualizado a través de este evento al que hemos denominado: “Semana Conmemorativa 25 años Aliviando el Dolor”. Desde Grupo Menarini nos sentimos muy orgullosos de alcanzar este aniversario y agradecemos profundamente su consideración terapéutica, esperando seguir formando parte importante de su día a día en el tratamiento y alivio del dolor de sus pacientes.

16 mayo
Las enfermedades cardiovasculares constituyen una de las causas más importantes de discapacidad y muerte prematura en todo el mundo. El problema subyacente es la aterosclerosis, que progresa a lo largo de los años, de modo que cuando aparecen los síntomas, generalmente a mediana edad, suele estar en una fase avanzada. Los episodios coronarios y cerebrovasculares agudos se producen de forma repentina y conducen a menudo a la muerte antes de que pueda brindarse la atención médica requerida. Existe una alta prevalencia de factores de riesgo cardiovascular en la población adulta, que en parte podría justificar la alta tasa de mortalidad cardiovascular existente a nivel mundial, la modificación de los factores de riesgo puede reducir los episodios cardiovasculares y la muerte prematura, tanto en las personas con enfermedad cardiovascular establecida, como en aquellas con alto riesgo cardiovascular con uno o más factores de riesgo. La eficacia de los medicamentos antihipertensivos ha mejorado, aumentando las dosis y/o combinando medicamentos con mecanismos de acción complementarios. Actualmente, se reconoce que la mayoría de pacientes con hipertensión necesitarán tratamiento combinado para poder alcanzar el control de la presión arterial.

23 mayo
La hipertensión arterial y la cardiopatía isquémica, constituyen la principal causa de mortalidad en el mundo y por ello es considerada la pandemia del tercer milenio. Si bien en la actualidad se hace mucho hincapié en el riesgo cardiovascular general derivado de la combinación de una Presión Arterial (PA) elevada, la presencia de factores de riesgo cardiovascular, la diabetes mellitus, el síndrome metabólico y el daño orgánico subclínico o establecido, el nivel de la PA por sí sola está íntimamente relacionado con el riesgo de mortalidad por motivos cardiovasculares. Teniendo en cuenta la íntima relación existente entre la PA elevada con mortalidad y morbilidad, se han recomendado una serie de objetivos de PA por las diferentes sociedades médicas internacionales como las Guías de Hipertensión Arterial de la Sociedad Europea de Hipertensión (ESH), la Sociedad Interamericana de Hipertensión (ISH) y la Sociedad Latinoamericana de Hipertensión (LASH). Con el paso de los años, estos objetivos se han reducido, dada la mayor consciencia del riesgo cardiovascular añadido de determinadas situaciones clínicas (por ejemplo, diabetes mellitus y la función renal), los objetivos recomendados se han ido diferenciando según el estadio I, II y III, de la PA y la estratificación de riesgo de los pacientes. La educación médica continua es el medio que, desde antaño, han utilizado los profesionales de la salud para el proceso ininterrumpido de aprendizaje que deben seguir para mantener un grado óptimo de competencia profesional, siendo esta requerida, por los continuos avances experimentados en las ciencias biosanitarias y por el deber médico de servicio para con la población en general. De este modo, la importancia de la educación médica continua radica en que deberán dar respuesta a las necesidades que día a día aparecen en las consultas que emergen en nuestra sociedad compleja, diversa y cambiante, para contribuir a que el profesional mantenga el equilibrio entre la vocación y las dificultades propias de la profesión. La formación médica continua se considera un pilar esencial en la profesión médica y mejora en la sostenibilidad sanitaria.

13 junio
La calidad asistencial hospitalaria, se define como “el conjunto de propiedades y características de un servicio que le confiere su aptitud para satisfacer las necesidades expresadas o implícitas de los pacientes”. Conseguir un nivel de calidad óptimo equivale, por tanto, a desarrollar grados de efectividad, de eficiencia, de adecuación y de calidad científico-técnica en la práctica asistencial que satisfagan por igual a administradores, profesionales y usuarios. Además se debe proveer la elaboración y cumplimiento de protocolos que prevengan riesgos y complicaciones a los pacientes hospitalizados, tales como: tromboprofilaxis, tratamiento de la enfermedad tromboembólica venosa en su fase aguda y a largo plazo, y manejo adecuado del dolor. La calidad en la Atención de Enfermería podemos definirla como: “la consecución del conjunto de características y acciones que posibilitan la restauración en cada paciente, del nivel de salud que nos es dado remitirle”. Se logrará la calidad máxima de nuestro servicio, si las personas que realizan la asistencia al enfermo, tienen conocimientos científicos adecuados permanentemente actualizados. Es por ello que Área Científica de Grupo Menarini ha organizado de forma Online el VI Simposium Centroamericano y del Caribe de Enfermería de Hospital.

20 junio
El programa científico se desarrollará durante 5 días, del lunes 20 al viernes 24 de junio. Los primeros tres días se abordarán temas sobre Tromboprofilaxis y los otros dos días estarán dedicados a Dolor Postoperatorio. Cada módulo está conformado por 3 o 4 conferencias, tienen una duración de 3 horas aproximadamente por día. Se otorgará certificado de participación al finalizar la actividad científica y horas crédito para Guatemala y República Dominicana.

05 julio
El V Seminario Centroamericano y del Caribe de Medicina del Deporte y Rehabilitación busca presentar una visión integrada de varias disciplinas clínicas y científicas aplicadas al deporte, actividad propia del ser humano, que ha ganado auge por los beneficios a la salud y bienestar general que ofrece a quienes lo practican. Se debe considerar que la Medicina del Deporte tiene sus fundamentos éticos en el Código Médico del Movimiento Olímpico, que se encarga de recordar las reglas básicas de las mejores prácticas médicas en el campo del deporte. Uno de sus principales objetivos es hacer prevalecer la salud y el bienestar del deportista. Por ello se hace indispensable considerar la salud de los pacientes y los efectos que el ejercicio tiene en la reducción del riesgo cardiovascular, enfermedades crónicas, obesidad, y en la salud mental: ansiedad, depresión y disminución del estrés; mejorando las capacidades cognitivas, habilidades sociales y resiliencia.

18 julio
El ser humano ha venido desarrollando a través de la historia diferentes estructuras sociales, desde tribus hasta grandes imperios, basado esto en el pensamiento y la conducta lo que a su vez ha dado lugar a la formación de diversas culturas y al desarrollo de nuevas tecnologías. Desde tiempos inmemoriales ha existido la necesidad en el ser humano de poder explicar y comprender de forma adecuada lo que se ha llegado a conocer como la mente e invariablemente poder asociarla a un órgano específico, en este caso es el cerebro al que se ha propuesto y estudiado como la estructura en la cual se asienta la misma, principalmente a partir de Anaxágoras de Klazomene (500-428 a.C.) quien propuso que el cerebro era el órgano de la mente y como este regula la imaginación, el razonamiento y la memoria (componentes básicos del intelecto según Galeno). A partir de esto se han propuesto ideas, teorías, puntos de vista, etc. hasta el establecimiento de escuelas de pensamiento, unos intentando unir mente y cerebro y otros separarlo, tratando de comprender de forma aislada a la mente y su funcionamiento tanto normal como patológico fuera del organicismo lo que llevó a una separación innecesaria antes de que formalmente nacieran la psiquiatría y la neurología como ciencias médicas, separación que gracias a los avances en el conocimiento y la tecnología se ha venido cerrando, demostrando que ambas ciencias pueden y deben explicar la compleja funcionalidad emotiva, afectiva, memorística, cognitiva, etc. basados en el cerebro y sus diferentes estructuras y funciones interrelacionadas principalmente a lo que recientemente se ha venido prestando mayor atención como lo son los neurotransmisores cuya función aumentada o disminuida pueden afectar no solo la parte afectiva sino en situaciones particulares también la parte motora de sistema nervioso central suponiendo un gran avance desde que Thomas Willis (1621-1675) introdujera el término neurología como "doctrina de los nervios”. Estamos pues ante un inminente encuentro entre dos ciencias que comparten mucho más de lo que teóricamente les separa, la psiquiatría y la neurología, dos enfoques complementarios y profundamente necesarios para la mejor comprensión de funciones complejas del sistema nervioso y cuya brecha es cada vez más estrecha. Grupo Menarini consciente de la necesidad de este acercamiento entre la psiquiatría y la neurología organiza el IV Simposium Centroamericano y del Caribe de Neurociencias.

08 agosto
En esta ocasión, le presentamos el II MASTER COURSE CENTROAMERICANO Y DEL CARIBE DE FARMACOECONOMÍA EN FARMACIA HOSPITALARIA donde se amplían las áreas terapéuticas en las que profundizaremos con excelencia científica. Los tópicos principales serán la farmacovigilancia, enfermedad tromboembólica venosa, uso de heparinas de bajo peso molecular y anticoagulación oral; dolor agudo, gluco corticoterapia, dolor visceral, crisis hipertensiva, entre otros. Pero no todo será conocimiento científico puro, porque necesitamos más que eso como profesión. Se necesita visión, objetivos, determinación y confianza en el desarrollo profesional como proveedores de valor asistencial a los pacientes. Necesitamos el qué, el por qué y el cómo, y por eso también se tratan estos temas en el programa que ha sido preparado de forma integral. Esta época de pandemia en donde todos hemos aprendido a volvernos a inventar, exige que tengamos conocimientos diversos tanto científico como personal. Esperamos que este programa sea de gran ayuda para los asistentes y que aporte mucho a su formación integral profesional.

09 agosto
La farmacia hospitalaria es el servicio de atención médica que se encarga de elegir, preparar,

22 agosto
El comercio minorista es uno de los sectores más importantes y dinámicos de la economía de cualquier país, ya que a través de él se operan volúmenes que hacen que tenga un peso relevante dentro del producto interno bruto, por lo cual se hace necesario que los jugadores que en él se desempeñan se adapten a los continuos cambios que sufren. En el último tiempo, se ha producido una saturación de aperturas de tiendas, en diferentes formatos. Hipermercados, supermercados, tiendas de conveniencia y farmacias, que abren el abanico de opciones a los compradores que están buscando satisfacer diversas misiones de compra: llenado, relleno, impulso, entre otras. Por otro lado, en el mercado farmacéutico, existe una creciente multiplicación de proveedores, marcas y presentaciones, con la que se genera la necesidad de colaboración entre proveedores y distribuidores, introduciendo de este modo a la relación netamente comercial, otros elementos que buscan beneficio mutuo como la información relevante del consumidor y comprador, la infraestructura del punto de venta y el talento humano capacitado para la atención y las demandas de los consumidores. Asimismo, la nueva normalidad ha acelerado el proceso de transformación digital en todos los sectores y el punto de venta farmacéutico no es ajeno a esta situación. Es por esto que Área Científica Menarini, comprometido con la formación del gremio farmacéutico, da origen al VII Seminario Centroamericano y del Caribe de Administración de Categorías para el Retail Farmacéutico en su versión Online, el cual busca apoyar las necesidades formativas y el desarrollo técnico en esta disciplina, para las farmacias de la región.

25 agosto
El VII Simposium Centroamericano y del Caribe de Actualización en Atención Farmacéutica en su versión Online, dirige su máximo esfuerzo en la actualización del personal de farmacia de los principales retailers farmacéuticos de la región y del personal de contacto con el usuario final, proporcionando un medio por el cual el asistente reciba información técnico científica encaminada a la profesionalización de la administración de categorías, la mejora de habilidades comerciales, servicio al cliente y la adecuada orientación y utilización de medicamentos de calidad. El punto de venta farmacéutico es hoy en día uno de los mercados más competitivos a nivel centroamericano, esto ha generado que las farmacias busquen diferenciarse de sus competidores no solo a nivel de precios sino a través del servicio al cliente y el valor agregado que invite al consumidor a vivir una experiencia de compra diferenciada. El temario de este VII Simposium ha sido enfocado para ser expuesto por ponentes profesionales del ámbito de los negocios y profesionales de la salud; líderes de opinión en sus áreas y que por su experiencia y trayectoria, pueden compartir con los asistentes al evento información vital y con altos estándares técnico-científicos. Esperamos de esta manera colaborar con el enriquecimiento intelectual del gremio farmacéutico y asistentes de farmacia para garantizar el profesionalismo y una dispensación de medicamentos responsable.

20 septiembre
Tenemos el placer de invitarle a participar en el IX Master Course Centroamericano y del Caribe de Patología Quirúrgica Musculoesquelética. Un año más, Área Científica Menarini ha tomado la iniciativa de patrocinar este proyecto. Se trata de una cita para la actualización académica y también una oportunidad de intercambiar experiencias con otros especialistas. Creemos en la necesidad de estas actividades docentes en nuestra especialidad, siempre dinámica y en constante renovación. Durante tres jornadas, los especialistas y médicos residentes dispondrán de una amplia oferta formativa, con la presentación de 12 ponencias, distribuidas en 3 módulos. Para ello contaremos con experimentados cirujanos que mantendrán la cercanía necesaria para que la reunión sea de lo más provechosa e interesante para todos. Sólo nos queda animarle a conocer nuestra manera de emplear las técnicas descritas en los temas seleccionados y a participar de la enriquecedora discusión que se establecerá dentro de esta reunión, que hemos preparado con nuestra mayor ilusión.

26 septiembre
Durante las últimas décadas, hemos observado cambios sustanciales en la práctica médica del gastroenterólogo, ya que los conocimientos, técnicas y procedimientos sufren modificaciones permanentemente, surgiendo la necesidad de actualizar y mantener la competencia profesional. El desarrollo profesional médico continuo, se lleva a cabo cuando el conocimiento teórico actualizado periódicamente (incluyendo formación en gestión, calidad, bioética y medicina basada en evidencia) se traslada a la práctica profesional, donde se conjuga con la experiencia y juicio crítico del médico y otros colegas, ofreciendo el mejor escenario para mantener y mejorar la competencia profesional. La educación médica continua en gastroenterología es un proceso de enseñanza-aprendizaje activo, con el fin de mejorar las capacidades frente a la evolución científica-tecnológica y los cambios en las necesidades sociales, para obtener nuevos conocimientos, valorando la vigencia de los adquiridos y complementando las carencias de manera que los resultados del ejercicio profesional sean de máxima calidad. Actualmente, dichas actividades se dirigen a mejorar la capacidad diagnóstica de las principales patologías del tracto gastrointestinal, aplicar nuevos tratamientos, de mejorar en la gestión y calidad integral de la atención especializada al paciente de una manera multidisciplinaria; ya que, cualquier enfermedad digestiva como: un síndrome de malabsorción por deficiencias enzimáticas, desórdenes intestinales y gastroesofágicos, podría conllevar a una afección persistente de la salud y del bienestar físico, mental y social del paciente que la padece. Grupo Menarini consciente de la necesidad de la educación médica continua de calidad en el gremio médico, teniendo en cuenta que tiene su núcleo fundamental en el autoaprendizaje individual, realiza este tipo de actividades a nivel mundial y se ha constituido como líder indiscutible en eventos de alto nivel científico en Centroamérica.

10 octubre
El II Simposium Centroamericano y del Caribe de Actualización Integral en Anticoagulación tiene como objetivo concientizar acerca de la carga de mortalidad causada por la trombosis en general, la necesidad de acción y, más específicamente, la amenaza no reconocida y las graves consecuencias de la ETV y la FA. Así mismo, los investigadores y ponentes principales a nivel mundial de estas condiciones, compartirán su experiencia en distintos escenarios que permitan una actualización importante en su abordaje integral. En MENARINI seguimos apostando por mejorar de Todo Corazón la Salud Cardiovascular de sus pacientes.

24 octubre
El III Congreso Estudiantil Centroamericano y del Caribe Interfacultades de Odontología, una iniciativa de Área Científica Menarini, busca dar respuesta a las necesidades de formación de los Futuros Odontólogos y ampliar los conocimientos de las técnicas y protocolos clínicos más recientes en Odontología Clínica. La Odontología Moderna es practicada hace años por profesionales y técnicos dentales entrenados con el objetivo de mejorar la calidad y exactitud de los tratamientos dentales, pero sobretodo la comodidad y confort de los pacientes. La implementación de los conocimientos adquiridos por los estudiantes en esta actividad permitirá a ellos mismos, un contacto personalizado con las técnicas más recientes sobre diseños, materiales y procedimientos diferentes, además de potenciar el trabajo en equipo de los futuros odontólogos, representando un avance en un campo novedoso como lo es la odontología estética. Sin lugar a dudas, esta iniciativa será de mucho provecho para el desarrollo profesional de los estudiantes asistentes.

26 octubre
Las enfermedades bucodentales han afectado a la humanidad desde sus mismos inicios, en especial el dolor agudo dentario producido por una caries profunda o un absceso periapical. Técnicas curativas y rehabilitadoras han sido practicadas por muchos médicos a lo largo de la historia. Teniendo en cuenta la íntima relación existente entre las enfermedades de la cavidad oral con la calidad de vida de la población, se han recomendado una serie de objetivos de cuidados bucales por las diferentes sociedades odontológicas internacionales y regionales. La práctica de la odontología es dinámica y sigue evolucionando y es por esto que la enseñanza odontológica es un aprendizaje continuo. Las actividades de educación médico/odontológica continua son indispensables para el desarrollo profesional del odontólogo general y especialista, permitiendo estar al corriente del progreso de la odontología clínica, mantener los conocimientos y la experiencia necesaria para prestar una atención de alta calidad. Es por esto que todos los odontólogos generales y especialistas tienen la responsabilidad consigo mismos y con la profesión de mantener altos niveles de formación odontológica y de actualización. De este modo, la importancia de la educación odontológica continua radica en que deberán dar respuesta a las necesidades que día a día aparecen en las consultas que emergen en nuestra sociedad compleja, diversa y cambiante, para contribuir a que el profesional mantenga el equilibrio entre la vocación y las dificultades propias de la profesión. La formación médica continua se considera un pilar esencial en la profesión odontológica y mejora la sostenibilidad sanitaria. Grupo Menarini, a través de Área Científica Menarini, consciente de la necesidad e importancia de la Educación Médica Continua, realiza el XIII Simposium Centroamericano y del Caribe de Actualización en Odontoestomatología, con el fin de transmitir el conocimiento de causa y efecto de cualquier patología oral con todos los pormenores y generar discusión de los casos odontológicos presentados, con los colegas de las diferentes áreas y especialidades médicas que darán como resultado un diagnóstico más seguro de la entidad que está en curso y un tratamiento efectivo para beneficio de la persona que merece todo el esfuerzo por parte del profesional para obtener el mejor resultado del paciente.

07 noviembre
La población pediátrica se encuentra expuesta a diferentes tipos de ambientes, los cuales tienen una profunda influencia en su crecimiento y desarrollo. Las exposiciones medioambientales, son tanto nocivas como beneficiosas para la salud, y no funcionan por separado, sino que interactúan como determinantes sociales y nutricionales de la salud, para influir en el bienestar de cada uno de ellos. Sean cuales sean los recursos naturales y el nivel de desarrollo económico, para todos los países y todas las comunidades, la población pediátrica representa el futuro, el cual debe cultivarse y protegerse. Por ello, la Organización Mundial de la Salud declara que el crecimiento y desarrollo infantil saludable debe ser una de las máximas prioridades para todas las sociedades. La población pediátrica es especialmente vulnerable frente a enfermedades que son prevenibles o tratables en su mayoría. Este grupo poblacional tiene características y necesidades específicas de salud, que requieren respuestas puntuales, por lo cual es indispensable generar mayor evidencia y conocimiento para el análisis y la implementación de soluciones a los problemas de salud que afectan a este grupo en particular. En la actualidad la salud infantil está mejorando, pero siguen existiendo serios desafíos para alcanzar metas globales que nos permitan reducir la morbi-mortalidad en éste ámbito. Cerca de dos tercios de muertes infantiles son prevenibles mediante intervenciones prácticas y una atención primaria eficaz. Por lo cual en el III Simposium Centroamericano y del Caribe Multidisciplinario de Actualización en Pediatría, se abordarán temas de relevancia científica y actualidad en el manejo de patologías presentes en el consultorio como lo son: las enfermedades respiratorias, alérgicas y gastrointestinales, además del adecuado manejo de la salud bucal en el paciente pediátrico. Como Área Científica Menarini, nuestro principal interés es la actualización y la educación médica continua, con ponentes referentes en el manejo del paciente pediátrico y de las patologías más frecuentes que afecta a la población infantil.

22 noviembre
El servicio de Emergencia es aquel ambiente dentro de un centro hospitalario, donde se prestan servicios de salud durante las veinticuatro horas del día a pacientes que demandan atención inmediata. Es en este servicio en donde se evalúa al paciente, se prioriza el daño y se inicia el tratamiento inicial para luego continuar con el manejo en las diferentes secciones del hospital o bien de forma ambulatoria. El personal que está a cargo de las emergencias debe ser muy profesional, capacitado y acreditado, para la atención de forma inmediata. A un servicio de emergencia pueden acudir diferentes pacientes con diversas patologías, desde una crisis hipertensiva, un dolor agudo tanto visceral como músculo-esquelético, una emergencia obstétrica, una complicación oncológica, entre otros. En esta época de pandemia en donde todos hemos aprendido a volvernos a inventar, exige que tengamos conocimientos diversos tanto científicos como personales y es por esto que tenemos a bien ofrecerles el II SIMPOSIUM CENTROAMERICANO Y DEL CARIBE DE EMERGENCIAS, en donde se disertará durante tres sesiones, algunos de los motivos de consulta más frecuentes a nivel hospitalario.

25 octubre
El V Curso Centroamericano y del Caribe de Actualización en Odontología Digital, una iniciativa de Área Científica Menarini, busca dar respuesta a las necesidades de formación de las especialidades odontológicas y ampliar conocimientos en las técnicas más recientes sobre diseño de sonrisa. El DSD se ha utilizado durante más de 10 años por algunos de los mejores técnicos dentales y odontólogos con el fin de mejorar la calidad de los tratamientos dentales estéticos. Este concepto se ha enseñado a más de 25,000 profesionales de la odontología en todo el mundo, y como concepto científico ha sido citado en numerosos artículos publicados en revistas internacionales de la profesión. La implementación de este V Curso Centroamericano y del Caribe de Actualización en Odontología Digital permite a odontólogos generales y especialistas un contacto personalizado con las técnicas más recientes sobre diseño de sonrisa, además de potenciar el trabajo en equipo de los odontólogos, y representa un avance en un campo novedoso como lo es la odontología estética. Sin lugar a dudas, la organización de este tipo de cursos, será de mucho provecho para el desarrollo profesional de los odontólogos de la región centroamericana y el caribe.

10 marzo
PROGRAMA DE EDUCACIÓN MÉDICA CONTINUA, ORGANIZADO POR EL HOSPITAL EL PILAR Y PATROCINADO POR ÁREA CIENTÍFICA MENARINI.

20 abril
Bienvenidos al I Master Course Centroamericano y del Caribe de Actualización en Odontoestomatología, soy el Profesor Cosme Gay-Escoda, Director de este Master Course, cuya finalidad es contribuir a la formación continuada de los Odontólogos, los Estomatólogos y de los distintos especialistas de esta área de las ciencias de la salud. También creemos que pueda ser de interés para los estudiantes de odontología especialmente de los últimos cursos y para los alumnos de los postgrados universitarios. Esperamos que los Colegios Profesionales de Odontología, las Sociedades Científicas de las diferentes especialidades y las Facultades de Odontología se interesen por este Master Course que pretende ayudar en la formación de sus asociados o alumnos.

06 junio
Hablar sobre problemas sexuales es siempre complicado y provoca vergüenza y ansiedad, especialmente para los hombres. Sin embargo, es quizás aún más difícil porque esto no es siempre visto como un problema médico real con una causa y tratamientos viables. En cualquier caso, la consulta con un médico es recomendada para un correcto diagnóstico y tratamiento. Las disfunciones sexuales se definen como la dificultad durante cualquier etapa del acto sexual (que incluye deseo, excitación, orgasmo y resolución) que evita al individuo o pareja el disfrute de la actividad sexual. Las disfunciones sexuales pueden manifestarse al comienzo de la vida sexual de la persona o pueden desarrollarse más adelante. Algunas de ellas pueden desarrollarse paulatinamente con el tiempo, y otras pueden aparecer súbitamente como incapacidad total o parcial para participar de una o más etapas del acto sexual. Las causas de las disfunciones sexuales pueden ser físicas, psicológicas o ambas. Por todo lo anterior, se comprende la importancia de dar a conocer información actualizada, mediante casos clínicos y presentaciones acerca de la prevalencia de la Eyaculación Precoz, así como de otras disfunciones sexuales masculinas de los avances en su manejo clínico y tratamiento. Permitiendo una mejoría importante en la salud sexual y mental del hombre y su pareja. Grupo Menarini consciente de la necesidad de la educación médica continua de calidad en el gremio médico, teniendo en cuenta que tiene su núcleo fundamental en el autoaprendizaje individual, realiza este tipo de actividades a nivel mundial y se ha constituido como líder indiscutible en eventos de alto nivel científico en Centroamérica y el Caribe.

21 abril
PROGRAMA DE EDUCACIÓN MÉDICA CONTINUA, ORGANIZADO POR EL HOSPITAL EL PILAR Y PATROCINADO POR ÁREA CIENTÍFICA MENARINI.

30 mayo
Bienvenidos al I Master Course Centroamericano y del Caribe de Actualización en Odontoestomatología, soy el Profesor Cosme Gay-Escoda, Director de este Master Course, cuya finalidad es contribuir a la formación continuada de los Odontólogos, los Estomatólogos y de los distintos especialistas de esta área de las ciencias de la salud. También creemos que pueda ser de interés para los estudiantes de odontología especialmente de los últimos cursos y para los alumnos de los postgrados universitarios. Esperamos que los Colegios Profesionales de Odontología, las Sociedades Científicas de las diferentes especialidades y las Facultades de Odontología se interesen por este Master Course que pretende ayudar en la formación de sus asociados o alumnos. Este Master Course va dirigido a todos los profesionales o alumnos de odontología de la comunidad latinoamericana de habla castellana que están esparcidos por todo el mundo y especialmente en los países de Norte América, Centroamérica, Caribe, Sudamérica, España y el resto de Europa.

05 mayo
Grupo Menarini, es pionera en comercializar el primer Paracetamol bebible en formato stick pack, forma farmacéutica que le confiere un rápido inicio de acción en el manejo del dolor agudo de leve a moderado y el control de la fiebre, bajo la marca Mencetamol®. De esta manera Mencetamol®, rápido alivio que se bebe, gracias a sus características innovadoras: su rápida absorción, no contiene gluten ni lactosa, es fácil de llevar y no necesita agua, se convertirá en una valiosa herramienta terapéutica que puede mejorar la calidad de vida de sus pacientes.

02 junio
Grupo Menarini, es pionera en comercializar el primer Paracetamol bebible en formato stick pack, forma farmacéutica que le confiere un rápido inicio de acción en el manejo del dolor agudo de leve a moderado y el control de la fiebre, bajo la marca Mencetamol®. De esta manera Mencetamol®, rápido alivio que se bebe, gracias a sus características innovadoras: su rápida absorción, no contiene gluten ni lactosa, es fácil de llevar y no necesita agua, se convertirá en una valiosa herramienta terapéutica que puede mejorar la calidad de vida de sus pacientes.

28 junio
Este Master Course va dirigido a todos los profesionales o alumnos de odontología de la comunidad latinoamericana de habla castellana que están esparcidos por todo el mundo y especialmente en los países de Norte América, Centroamérica, Caribe, Sudamérica, España y el resto de Europa. Este Master Course es gratuito y está esponsorizado por Grupo Menarini que ha procurado que este formato favorezca la compatibilidad de sus obligaciones profesionales, con las responsabilidades familiares y comunitarias en este tiempo tan duro que nos ha tocado vivir con la pandemia de la enfermedad COVID-19. El Master Course está estructurado en 8 módulos de los cuales 6 son de especialidades odontológicas y 2 son interdisciplinarios de la odontología con un total de 47 conferencias y un turno de preguntas en cada módulo.

14 junio
La investigación y desarrollo (I+D), es cada vez más condición, sinequanon y garantía para la supervivencia de cualquier industria moderna. Y en el sector de la salud, cuyo desempeño impacta directamente en el bienestar y calidad de vida de las personas, adquiere aún más importancia el continuar desarrollando innovadoras terapias que sean accesibles y cada vez más adaptadas a las necesidades de los pacientes. A pesar de los muchos avances en el conocimiento de la fisiopatología del dolor y en los mecanismos de acción de los medicamentos analgésicos, el tratamiento del dolor sigue siendo deficiente y constituye uno de los principales motivos de consulta en la práctica clínica diaria. Cabe resaltar que el dolor orofacial es un problema complejo, en el que pueden estar implicadas diversas regiones anatómicas y que puede responder a diferentes etiologías: neurológica, tumoral, traumática, iatrogénica y dental, entre otras. No obstante, las algias faciales se deben en su mayoría a causas de origen dental como caries, pulpitis y enfermedad periodontal. Las repercusiones del dolor producen efectos de alcance emocional, social y económico, afectando a las personas tanto en el ámbito familiar como en el mercado laboral y su consecuente uso de los recursos asistenciales. De estas consideraciones, Grupo Menarini se propuso desarrollar un AINE con mínimos efectos adversos que permitiera tratar el dolor de los pacientes con un alto perfil de eficacia y seguridad.

27 julio
Bienvenidos al I Master Course Centroamericano y del Caribe de Actualización en Odontoestomatología, soy el Profesor Cosme Gay-Escoda, Director de este Master Course, cuya finalidad es contribuir a la formación continuada de los Odontólogos, los Estomatólogos y de los distintos especialistas de esta área de las ciencias de la salud. También creemos que pueda ser de interés para los estudiantes de odontología especialmente de los últimos cursos y para los alumnos de los postgrados universitarios. Esperamos que los Colegios Profesionales de Odontología, las Sociedades Científicas de las diferentes especialidades y las Facultades de Odontología se interesen por este Master Course que pretende ayudar en la formación de sus asociados o alumnos. Este Master Course va dirigido a todos los profesionales o alumnos de odontología de la comunidad latinoamericana de habla castellana que están esparcidos por todo el mundo y especialmente en los países de Norte América, Centroamérica, Caribe, Sudamérica, España y el resto de Europa. Este Master Course es gratuito y está esponsorizado por Grupo Menarini que ha procurado que este formato favorezca la compatibilidad de sus obligaciones profesionales, con las responsabilidades familiares y comunitarias en este tiempo tan duro que nos ha tocado vivir con la pandemia de la enfermedad COVID-19. El Master Course está estructurado en 8 módulos de los cuales 6 son de especialidades odontológicas y 2 son interdisciplinarios de la odontología con un total de 47 conferencias y un turno de preguntas en cada módulo.

15 junio
PROGRAMA DE EDUCACIÓN MÉDICA CONTINUA, ORGANIZADO POR EL HOSPITAL EL PILAR Y PATROCINADO POR ÁREA CIENTÍFICA MENARINI.

11 julio
Para la Asociación de Medicina del Deporte de Guatemala (AMDG) es un orgullo el poder realizar este Simposio Panamericano de Medicina del Deporte 2022, en el cual se estará haciendo énfasis en la optimización del rendimiento deportivo, lesiones deportivas y su recuperación. Los distinguidos conferencistas forman parte del Comité Ejecutivo de la Confederación Panamericana de Medicina del Deporte (COPAMEDE) y las conferencias a disertar servirán al conglomerado médico para ampliar los conocimientos sobre Medicina del Deporte. Queremos agradecer el apoyo incondicional brindado por Grupo Menarini para lograr la realización de este magno evento.

16 agosto
El Master Course está estructurado en 8 módulos de los cuales 6 son de especialidades odontológicas y 2 son interdisciplinarios de la odontología con un total de 47 conferencias y un turno de preguntas en cada módulo. Los 6 módulos de especialidades Odontológicas son el primero de Cirugía Bucal y Maxilofacial coordinado por el Profesor José Luis Gutiérrez, el segundo es de Medicina Bucal y Patología Oral coordinado por el Profesor José Manuel Aguirre, el tercer módulo es de Patología y Terapéutica Dental y Endodoncia que está coordinado por la Profesora Montserrat Mercadé, el cuarto es de Prótesis y Estética Dental y está coordinado por el Profesor Tomás Escuin, el quinto módulo es de Periodoncia y está coordinado por la Doctora Nuria Vallarcoba y el sexto módulo es de Implantología y está coordinado por la Profesora María Ángeles Sánchez Garcés. Los dos módulos interdisciplinarios son, el séptimo módulo de Terapéutica Odontológica y Gestión de una Clínica Dental que está coordinado por el Profesor Eduardo Valmaceda y el octavo y último módulo es de Atención a Pacientes Odontológicos con Patología Sistémica conocidos como “Pacientes Especiales” que está coordinado por el Profesor Guillermo Machuca.

14 julio
Sesión Científica organizada por el Hospital el Pilar con el patrocinio de Área Científica Menarini.

12 septiembre
La Nutrición Clínica es la disciplina que se ocupa de la prevención, diagnóstico y tratamiento de los cambios nutricionales y metabólicos relacionados con enfermedades agudas o crónicas y con condiciones causadas por un exceso o falta de energía. En el campo científico, la nutrición se ocupa de todos los aspectos relacionados con la interacción entre alimentos, nutrientes, vida, salud y enfermedad, teniendo como objeto de estudio, el proceso por el cual un organismo ingiere, absorbe, transporta, utiliza y excreta sustancias alimenticias. Es necesario hacer énfasis en que la nutrición clínica no tiene solo un enfoque curativo, sino también preventivo; pues la terapia nutricional es clave en el tratamiento de las enfermedades crónico-degenerativas, pero también lo es para prevenirlas. Es por ello, que resulta fundamental la participación coordinada de los miembros de las unidades de nutrición y otros servicios, incluyendo médicos, dietistas, nutricionistas y farmacéuticos que desempeñan un papel muy relevante para lograr este objetivo. Teniendo en cuenta el concepto anterior se ha hecho evidente, a lo largo de los años, que las situaciones que demandan la atención de un profesional de la nutrición clínica son numerosas; y que la relación nutrición-salud se ha ido consolidando hasta identificar que, los estilos de vida y los hábitos alimenticios son capaces de prevenir y mejorar la situación clínica de las enfermedades como: desnutrición, sobrepeso y obesidad, diabetes, alteraciones del aparato digestivo y patologías cardiacas y renales entre otras. Grupo Menarini es consciente que muchas de estas problemáticas son consecuencias de una dieta poco saludable, y del hecho que la alimentación y la salud van de la mano. Es por ello que promueve y organiza el III Seminario Centroamericano y del Caribe de Actualización en Nutrición Clínica enfocado en conocer mejor la importancia de la nutrición y la relevancia de los trastornos asociados a ella, consolidando en nuestros profesionales de la atención nutricional este concepto con la visión de mejorar y promover la atención multidisciplinaria de los trastornos nutricionales y sus consecuencias en la biología de la buena salud.

03 octubre
La necesidad de tratar las enfermedades autoinmunes se enfatiza por el hecho que estas afectan a millones de personas a nivel mundial y constituyen una de las principales causas de muerte principalmente en mujeres menores de 65 años. Aunque pueden afectar a cualquiera, más mujeres que hombres padecen estas enfermedades y frecuentemente se presentan durante la etapa reproductiva. Se estima que aproximadamente del 5 al 7% de la población mundial se encuentra afectada por las enfermedades autoinmunes y que su incidencia sigue aumentando rápidamente. La gran mayoría sufre alguno de los problemas más frecuentes: artritis reumatoide, lupus eritematoso sistémico, esclerosis múltiple, diabetes juvenil tipo 1, tiroiditis y enfermedad de Crohn. Estas enfermedades de carácter crónico cursan con períodos de remisión y exacerbaciones que pueden conducir en ocasiones a degeneración incapacitante e incluso mortal, si no se proporciona el tratamiento adecuado a tiempo.

06 septiembre
Este Master Course va dirigido a todos los profesionales o alumnos de odontología de la comunidad latinoamericana de habla castellana que están esparcidos por todo el mundo y especialmente en los países de Norte América, Centroamérica, Caribe, Sudamérica, España y el resto de Europa. Este Master Course es gratuito y está esponsorizado por Grupo Menarini que ha procurado que este formato favorezca la compatibilidad de sus obligaciones profesionales, con las responsabilidades familiares y comunitarias en este tiempo tan duro que nos ha tocado vivir con la pandemia de la enfermedad COVID-19. El Master Course está estructurado en 8 módulos de los cuales 6 son de especialidades odontológicas y 2 son interdisciplinarios de la odontología con un total de 47 conferencias y un turno de preguntas en cada módulo.

18 octubre
Los cambios estructurales y funcionales asociados con el envejecimiento cardiovascular, disminuyen de forma significativa el umbral en el cual las enfermedades cardíacas llegan a ser evidentes, y deben ser conocidos por el personal de salud encargado de cuidar a los ancianos, por esta razón el III Foro Centroamericano y del Caribe de Geriatría, organizado en conjunto con la Asociación Guatemalteca de Medicina del Adulto Mayor (AGMA), se llama Hot Topics en Geriatría que es la práctica de la medicina cardiovascular adaptada al anciano, abarcando la complejidad y peculiaridades de esta población, con el objetivo de fortalecer los conocimientos sobre las enfermedades cardiovasculares y el abordaje de la enfermedad cardiovascular en el adulto mayor, que es un reto hacia el futuro. Esperamos que los tópicos tratados en este foro llenen sus expectativas de educación médica continua.

14 noviembre
Irene E. Newman nacida el 4 de julio de 1875 en EE.UU. es la que se considera como la primera higienista dental de la historia. Corría el año 1906 cuando el Doctor Alfred Fones decidió enseñar a Irene cómo limpiar los dientes y a realizar otros tratamientos preventivos en niños, ya que consideraba que la prevención era fundamental a la hora de evitar el desarrollo de enfermedades. El Colegio de Higienistas de Madrid explica que a Fones precisamente se le atribuye acuñar el término de “higiene dental”, ya que explicaba a sus propios pacientes, también a Irene, que con estas técnicas de higiene se trataba de prevenir y no de curar. Por eso mismo, Fones no quiso llamar a Irene Newman enfermera dental, si no que la denominó Higienista dental. Así fue como, tras aprender del doctor, Irene Newman realizó su primera profilaxis oral para un paciente en el año 1907. Es decir, su primera práctica como higienista dental, convirtiéndose así en la primera profesional del sector. Hoy 115 años después de este gran día los Higienistas Dentales toman una enorme importancia en la clínica dental, generando no solo esa higiene dental tan importante en la salud del paciente, sino también la labor educativa que permite que cada persona pueda cuidar su boca de una mejor manera. Consciente de la importancia de la labor del Higienista Dental, Grupo Menarini Centroamérica y el Caribe, desarrolla este programa de Educación Médica Continua enfocado en brindar educación y formación actualizada al gremio de Higienistas / Asistentes Dentales de la región Centroamericana con el I Curso Centroamericano y del Caribe de Actualización para Higienistas / Asistentes Dentales y generar la discusión de los casos y perfiles de trabajo dentro de la clínica dental, siempre en la búsqueda de la mejora continua de la atención del paciente.

04 octubre
Este Master Course va dirigido a todos los profesionales o alumnos de odontología de la comunidad latinoamericana de habla castellana que están esparcidos por todo el mundo y especialmente en los países de Norte América, Centroamérica, Caribe, Sudamérica, España y el resto de Europa. Este Master Course es gratuito y está esponsorizado por Grupo Menarini que ha procurado que este formato favorezca la compatibilidad de sus obligaciones profesionales, con las responsabilidades familiares y comunitarias en este tiempo tan duro que nos ha tocado vivir con la pandemia de la enfermedad COVID-19. El Master Course está estructurado en 8 módulos de los cuales 6 son de especialidades odontológicas y 2 son interdisciplinarios de la odontología con un total de 47 conferencias y un turno de preguntas en cada módulo.

18 agosto
PROGRAMA DE EDUCACIÓN MÉDICA CONTINUA, ORGANIZADO POR EL HOSPITAL EL PILAR Y PATROCINADO POR ÁREA CIENTÍFICA MENARINI.

02 septiembre
El programa científico se desarrollará el día viernes 2 de septiembre; en un módulo de cinco conferencias, con duración de 45 minutos cada una.

15 septiembre
PROGRAMA DE EDUCACIÓN MÉDICA CONTINUA, ORGANIZADO POR EL HOSPITAL EL PILAR Y PATROCINADO POR ÁREA CIENTÍFICA MENARINI.

14 noviembre
Grupo Menarini, a través de Área Científica Menarini, ha sido pionera en la implementación de la educación continua en las diferentes ramas que brindan atención en la salud de la población en general. Dentro de este contexto, los ginecólogos y obstetras juegan un papel fundamental en el cuidado integral de la salud de la mayor parte de la población, atendiendo las necesidades de la mujer a lo largo de su vida. Las mujeres tienen necesidades de salud únicas, como el cuidado previo, durante y posterior al embarazo y la menopausia, e, incluso, padecimientos que pueden afectar su calidad de vida de manera diferente, como el Síndrome de Anticuerpos Antifosfolípidos, las Hepatitis Virales Crónicas, y el manejo del dolor ante las distintas comorbilidades. La educación médica continua es el medio que, desde hace muchos años, han utilizado los profesionales de la salud para el proceso ininterrumpido de aprendizaje que deben seguir para mantenerse actualizados considerando los continuos avances en la ciencia biosanitaria. La misma debe responder a las necesidades que día a día aparecen en las consultas de los profesionales de la salud y el área de Ginecología y Obstetricia no se queda atrás. Este IV Simposium busca fomentar el trabajo multidisciplinario y el abordaje integral de los temas relevantes en la salud femenina, con especial énfasis en el embarazo de alto riesgo y dolor postoperatorio en los diferentes escenarios clínicos, permitiendo el intercambio de experiencias clínicas y científicas, aportando como Área Científica formación de alto nivel y temas de vanguardia.

06 octubre
PROGRAMA DE EDUCACIÓN MÉDICA CONTINUA, ORGANIZADO POR EL HOSPITAL EL PILAR Y PATROCINADO POR ÁREA CIENTÍFICA MENARINI.

17 octubre
WEBINAR DÍA MUNDIAL DE LA TROMBÓSIS

24 noviembre
Asociación Guatemalteca de Anestesiología, Reanimación y tratamiento del Dolor. AGARTD

03 noviembre
PROGRAMA DE EDUCACIÓN MÉDICA CONTINUA, ORGANIZADO POR EL HOSPITAL EL PILAR Y PATROCINADO POR ÁREA CIENTÍFICA MENARINI.

01 enero
El servicio de Emergencia es aquel ambiente dentro de un centro hospitalario, donde se prestan servicios de salud durante las veinticuatro horas del día a pacientes que demandan atención inmediata. Es en este servicio en donde se evalúa al paciente, se prioriza el daño y se inicia el tratamiento inicial para luego continuar con el manejo en las diferentes secciones del hospital o bien de forma ambulatoria. El personal que está a cargo de las emergencias debe ser muy profesional, capacitado y acreditado, para la atención de forma inmediata. A un servicio de emergencia pueden acudir diferentes pacientes con diversas patologías, desde una crisis hipertensiva, un dolor agudo tanto visceral como músculo-esquelético, una emergencia obstétrica, una complicación oncológica, entre otros. En esta época de pandemia en donde todos hemos aprendido a volvernos a inventar, exige que tengamos conocimientos diversos tanto científicos como personales y es por esto que tenemos a bien ofrecerles el II SIMPOSIUM CENTROAMERICANO Y DEL CARIBE DE EMERGENCIAS, en donde se disertará durante tres sesiones, algunos de los motivos de consulta más frecuentes a nivel hospitalario.

01 enero
El servicio de Emergencia es aquel ambiente dentro de un centro hospitalario, donde se prestan servicios de salud durante las veinticuatro horas del día a pacientes que demandan atención inmediata. Es en este servicio en donde se evalúa al paciente, se prioriza el daño y se inicia el tratamiento inicial para luego continuar con el manejo en las diferentes secciones del hospital o bien de forma ambulatoria. El personal que está a cargo de las emergencias debe ser muy profesional, capacitado y acreditado, para la atención de forma inmediata. A un servicio de emergencia pueden acudir diferentes pacientes con diversas patologías, desde una crisis hipertensiva, un dolor agudo tanto visceral como músculo-esquelético, una emergencia obstétrica, una complicación oncológica, entre otros. En esta época de pandemia en donde todos hemos aprendido a volvernos a inventar, exige que tengamos conocimientos diversos tanto científicos como personales y es por esto que tenemos a bien ofrecerles el II SIMPOSIUM CENTROAMERICANO Y DEL CARIBE DE EMERGENCIAS, en donde se disertará durante tres sesiones, algunos de los motivos de consulta más frecuentes a nivel hospitalario.

14 febrero
La atención primaria de salud es la asistencia sanitaria esencial accesible a todos los individuos adoptando una visión holística de la salud que va mucho más allá del limitado modelo médico. La educación médica continua en atención primaria tiene como finalidad proporcionar conocimiento válido, útil y preciso que permita tomar decisiones dirigidas a prestar una asistencia sanitaria a la población, más adecuada a sus necesidades, más efectiva y de mayor seguridad y calidad. Grupo Menarini Centroamérica y el Caribe, tomando en cuenta que la Atención Primaria es la base del sistema de salud de cualquier país y al mismo tiempo es la solución de los problemas más comunes que aquejan a la población latinoamericana, considera que es de vital importancia proveer las herramientas necesarias al profesional de salud para enfrentar su entorno cada vez más demandante.

01 enero

21 febrero
El programa científico se desarrollará en 3 días, de martes a jueves; en módulos de 2 horas con 30 minutos cada día. Cada módulo consta de 3 a 4 conferencias con una duración de 30 minutos cada una; al finalizar se tendrá una sesión de preguntas y respuestas, con participación de los expositores.

26 septiembre
La Nutrición Clínica es la disciplina que se ocupa de la prevención, diagnóstico y tratamiento de los cambios nutricionales y metabólicos relacionados con enfermedades agudas o crónicas y con condiciones causadas por un exceso o falta de energía. En el campo científico, la nutrición se ocupa de todos los aspectos relacionados con la interacción entre alimentos, nutrientes, vida, salud y enfermedad, teniendo como objeto de estudio, el proceso por el cual un organismo ingiere, absorbe, transporta, utiliza y excreta sustancias alimenticias. Grupo Menarini es consciente que muchas de estas problemáticas son consecuencias de una dieta poco saludable, y del hecho que la alimentación y la salud van de la mano. Es por ello que promueve y organiza el IV Seminario Centroamericano y del Caribe de Actualización en Nutrición Clínica enfocado en conocer mejor la importancia de la nutrición y la relevancia de los trastornos asociados a ella, consolidando en nuestros profesionales de la atención nutricional este concepto con la visión de mejorar y promover la atención multidisciplinaria de los trastornos nutricionales y sus consecuencias en la biología de la buena salud.

27 abril
Este IV Simposium de Síndrome Coronario Crónico tiene como objetivo presentar los aspectos más actualizados en el diagnóstico y tratamiento de esta condición contando con el aval de la Sociedad Dominicana de Cardiología, quien será la anfitriona de este magno evento. Existen tratamientos innovadores como lo es Ranolazina aprobado por FDA y EMA que se utiliza para el tratamiento de primera y segunda línea de la angina crónica, que brinda al paciente una disminución de episodios anginosos a la semana, menor recurrencia de isquemia, mayor tolerancia al ejercicio y mejora la calidad de vida, el cual tendrá un espacio muy importante dentro del programa científico para demostrar su evidencia científica.

28 agosto
Grupo Menarini consciente de la necesidad de la educación médica continua de calidad en el gremio médico, teniendo en cuenta que tiene su núcleo fundamental en el autoaprendizaje individual, realiza este tipo de actividades a nivel mundial y se ha constituido como líder indiscutible en eventos de alto nivel científico en Centroamérica y el Caribe. Este IV Curso Centroamericano y del Caribe de Salud Sexual tiene como objetivo el promover y facilitar a los médicos con educación médica continua en el ámbito de salud sexual, y de los avances en su manejo clínico y tratamiento que permitan una mejoría importante en la salud sexual y mental del hombre y su pareja.

18 septiembre
En la actualidad la salud infantil está mejorando, pero siguen existiendo serios desafíos para alcanzar metas globales que nos permitan reducir la morbi-mortalidad en éste ámbito. Cerca de dos tercios de muertes infantiles son prevenibles mediante intervenciones prácticas y una atención primaria eficaz. Por lo cual en el IV Simposium Centroamericano y del Caribe Multidisciplinario de Actualización en Pediatría, se abordarán temas de relevancia científica y actualidad en el manejo de patologías presentes en el consultorio como lo son: las enfermedades respiratorias, alérgicas y gastrointestinales, además del adecuado manejo de la salud bucal en el paciente pediátrico. Como Área Científica Menarini, nuestro principal interés es la actualización y la educación médica continua, con ponentes referentes en el manejo del paciente pediátrico y de las patologías más frecuentes que afecta a la población infantil.

06 noviembre
La educación médica continua es el medio que, desde hace muchos años, han utilizado los profesionales de la salud para el proceso ininterrumpido de aprendizaje que deben seguir para mantenerse actualizados considerando los continuos avances en la ciencia biosanitaria. La misma debe responder a las necesidades que día a día aparecen en las consultas de los profesionales de la salud y el área de Ginecología y Obstetricia no se queda atrás. Este V Simposium busca fomentar el trabajo multidisciplinario y el abordaje integral de los temas relevantes en la salud femenina, con especial énfasis en el embarazo de alto riesgo y dolor postoperatorio en los diferentes escenarios clínicos, permitiendo el intercambio de experiencias clínicas y científicas, aportando como Área Científica formación de alto nivel y temas de vanguardia.

28 noviembre
En esta época de constantes cambios hemos tenido que aprender a reinventarnos, es una época que nos exige conocimientos y experiencia. Es por ello, que tenemos a bien presentarles el III SIMPOSIUM CENTROAMERICANO Y DEL CARIBE DE EMERGENCIAS MÉDICAS, en donde se abordará a lo largo de tres sesiones algunos de los motivos de consulta más frecuentes a nivel de emergencia, con ponentes de referencia que aportarán a la educación médica continua de la región. Esperamos que este programa sea de gran ayuda para todos y que aporte mucho a su formación integral profesional.

19 junio
El IV Congreso Estudiantil Centroamericano y del Caribe Interfacultades de Odontología, una iniciativa de Área Científica Menarini, busca dar respuesta a las necesidades de formación de los Futuros Odontólogos y ampliar los conocimientos de las técnicas y protocolos clínicos más recientes en Odontología Clínica. La Odontología Moderna es practicada hace años por profesionales y técnicos dentales entrenados con el objetivo de mejorar la calidad y exactitud de los tratamientos dentales, pero sobretodo la comodidad y confort de los pacientes.

22 junio
La implementación de este VI Curso Centroamericano y del Caribe de Actualización en Odontología Digital permite a odontólogos generales y especialistas un contacto personalizado con las técnicas más recientes sobre diseño de sonrisa, además de potenciar el trabajo en equipo de los odontólogos, y representa un avance en un campo novedoso como lo es la odontología estética. Sin lugar a dudas, la organización de este tipo de cursos, será de mucho provecho para el desarrollo profesional de los odontólogos de la región centroamericana y el caribe.

26 junio
Grupo Menarini, a través de Área Científica Menarini, consciente de la necesidad e importancia de la Educación Médica Continua, realiza el XIV Simposium Centroamericano y del Caribe de Actualización en Odontoestomatología, con el fin de transmitir el conocimiento de causa y efecto de cualquier patología oral con todos los pormenores y generar discusión de los casos odontológicos presentados, con los colegas de las diferentes áreas y especialidades médicas que darán como resultado un diagnóstico más seguro de la entidad que está en curso y un tratamiento efectivo para beneficio de la persona que merece todo el esfuerzo por parte del profesional para obtener el mejor resultado del paciente.

18 enero
El envejecimiento progresivo de la población condiciona a que cada vez sean más los pacientes mayores que se atienden a nivel de la consulta médica. El envejecimiento es una situación biológica normal que se produce dentro de un proceso dinámico, progresivo, irreversible, complejo y variado. Difiere en la forma en cómo afecta a las distintas personas e incluso a los diferentes órganos. Durante los últimos años hemos visto la necesidad e interés crecientes por el conocimiento de la patología cardiovascular en el paciente anciano. Las enfermedades cardiovasculares constituyen una de las causas más importantes de discapacidad y muerte prematura en todo el mundo. El envejecimiento del sistema cardiovascular está asociado con cambios característicos a nivel bioquímico, histológico, fisiológico y morfológico. No todas las modificaciones presentadas se asocian con deterioro en la función.

31 julio
Con este VI Seminario Centroamericano y del Caribe de Medicina del Deporte y Rehabilitación, Área Científica de Grupo Menarini, busca ofrecer un panorama multidisciplinario al profesional de la salud tocando aspectos relativos a la salud cardiovascular, manejo de las lesiones y el dolor, nutrición y suplementos nutricionales, todo enmarcado en los principios éticos médicos cuyo interés es atender las demandas físicas y psicológicas de los deportistas, buscando mejorar su rendimiento físico y su bienestar en general.

17 agosto
La anticoncepción consiste en evitar la fecundación de un óvulo por un espermatozoide (concepción) o la adherencia del óvulo fecundado al endometrio (implantación). Los métodos anticonceptivos pueden ser temporales (por ejemplo, píldoras anticonceptivas, un dispositivo intrauterino, anillo vaginal) o permanentes (destinados a evitar el embarazo de forma permanente como, por ejemplo, la vasectomía o la ligadura de trompas). Los métodos anticonceptivos utilizados para el control de la natalidad pueden ser para la prevención de un embarazo no planeado. Esto no solo dependerá de la protección ofrecida por el método, sino también del correcto uso. Para lo cual el asesoramiento médico y la planificación familiar es sumamente importante, ya que permitirá incrementar la satisfacción de quienes los usan, orientándolos hacia la elección del que cubra mejor sus necesidades y estilos de vida.

06 junio
Desde tiempos inmemoriales ha existido la necesidad en el ser humano de poder explicar y comprender de forma adecuada lo que se ha llegado a conocer como la mente e invariablemente poder asociarla a un órgano específico, en este caso es el cerebro al que se ha propuesto y estudiado como la estructura en la cual se asienta la misma, principalmente a partir de Anaxágoras de Klazomene (500-428 a.C.) quien propuso que el cerebro era el órgano de la mente y como este regula la imaginación, el razonamiento y la memoria (componentes básicos del intelecto según Galeno).

15 junio
La anticoncepción consiste en evitar la fecundación de un óvulo por un espermatozoide (concepción) o la adherencia del óvulo fecundado al endometrio (implantación). Los métodos anticonceptivos pueden ser temporales (por ejemplo, píldoras anticonceptivas, un dispositivo intrauterino, anillo vaginal) o permanentes (destinados a evitar el embarazo de forma permanente como, por ejemplo, la vasectomía o la ligadura de trompas).

23 octubre
Este III Simposium Centroamericano y del Caribe de Actualización Integral en Anticoagulación tiene como objetivo concientizar acerca de la carga de mortalidad causada por la trombosis en general, la necesidad de acción y, más específicamente, la amenaza no reconocida y las graves consecuencias de la ETV y la FA. Así mismo, los investigadores y ponentes principales a nivel mundial de estas condiciones, compartirán su experiencia en distintos escenarios que permitan una actualización importante en su abordaje integral. En MENARINI seguimos apostando por mejorar de Todo Corazón la Salud Cardiovascular de sus pacientes.

17 julio
Debido a la relevancia epidemiológica de las enfermedades cardiovasculares y considerando que su morbilidad representa un alto costo para nuestros países y las familias afectadas, el objetivo de este XVII Simposium Centroamericano y del Caribe Online de Actualización en Enfermedad Cardiovascular es fortalecer los conocimientos sobre las enfermedades cardiovasculares, así como promover la conciencia sobre la importancia de la modificación de los hábitos de vida dirigida a reducir los factores de riesgo que conforman la enfermedad cardiovascular. Grupo Menarini Centroamérica y el Caribe, consciente de la necesidad de la educación médica continua de calidad en el gremio médico, teniendo en cuenta que tiene su núcleo fundamental en el autoaprendizaje individual, realiza este tipo de actividades a nivel mundial y se ha constituido como el líder indiscutible en la educación médica continua en Centroamérica y el Caribe.

24 julio
La Sociedad Europea de Hipertensión (ESH) y la Sociedad Interamericana de Hipertensión (ISH) conscientes de la necesidad de la educación médica continua de calidad en el gremio médico y teniendo en cuenta que tiene su núcleo fundamental en el autoaprendizaje individual, realiza este XIII Master Course Online en Hipertensión y Riesgo Cardiovascular, para compartir el conocimiento y crear una relación científica entre las Sociedades y los especialistas de esta región en la actualización del diagnóstico y tratamiento de la hipertensión arterial y sus factores de riesgo, para contribuir a la prevención de la enfermedad cardiovascular en Centroamérica y el Caribe. Este Master Course se enfocará en el manejo integral de la hipertensión y los factores de riesgo cardiovascular, así como la enfermedad coronaria mediante presentaciones y debates de enfoques de actualidad sobre estos temas.

04 septiembre
Creemos en la necesidad de estas actividades docentes en nuestra especialidad, siempre dinámica y en constante renovación. Durante cinco jornadas, los especialistas y médicos residentes dispondrán de una amplia oferta formativa, con la presentación de 19 ponencias, distribuidas en 5 módulos. Para ello contaremos con experimentados cirujanos que mantendrán la cercanía necesaria para que la reunión sea de lo más provechosa e interesante para todos. Sólo nos queda animarle a conocer nuestra manera de emplear las técnicas descritas en los temas seleccionados y a participar de la enriquecedora discusión que se establecerá dentro de esta reunión, que hemos preparado con nuestra mayor ilusión.

17 abril
La deficiencia de vitamina D en niños puede provocar raquitismo, una patología típica de la infancia, caracterizada por una mineralización reducida de los huesos que puede deformarse y causar discapacidad. Mientras en los jóvenes, adultos y ancianos, la deficiencia de vitamina D está relacionada a causar osteomalacia y puede contribuir a la patogénesis de la osteoporosis, así como a una respuesta fallida, a la terapia farmacológica de la misma. También está relacionada a otras patologías como reumatismo, enfermedades dermatológicas y patologías del sistema inmune. Es por eso que para mantener los niveles adecuados de vitamina D, en todas las etapas de la vida, es necesaria la suplementación. Grupo Menarini Centroamérica y el Caribe, siempre comprometido con la educación médica continua y las problemáticas actuales, organiza el I Foro Multidisciplinario de Expertos en Vitamina D, donde se abordarán temas relacionados a los riesgos de padecer esta deficiencia, pero también las soluciones para mejorar la calidad de vida de los pacientes.

08 mayo
Grupo Menarini Centroamérica y el Caribe, siempre comprometido con la educación médica continua y las problemáticas actuales, organiza el I Foro Multidisciplinario de Expertos en Vitamina D, donde se abordarán temas relacionados a los riesgos de padecer esta deficiencia, pero también las soluciones para mejorar la calidad de vida de los pacientes.

16 octubre

09 marzo
Según La Organización Mundial de la Salud (OMS), el dolor es la “mayor amenaza” para la calidad de vida a nivel mundial, ya que conlleva importantes repercusiones clínicas con limitaciones de las actividades diarias, interrupción de la vida social, absentismo e incapacidad laboral. La Sociedad Internacional para el Estudio del Dolor (IASP, por sus siglas en inglés) define al dolor como: “una experiencia sensorial y emocional desagradable, asociada a un daño tisular real o potencial o descrita en términos de tal daño”. Grupo Menarini, es pionera en comercializar el primer Paracetamol bebible en formato stick pack, forma farmacéutica que le confiere un rápido inicio de acción en el manejo del dolor agudo de leve a moderado y el control de la fiebre, bajo la marca Mencetamol®. De esta manera Mencetamol®, rápido alivio que se bebe, gracias a sus características innovadoras: su rápida absorción, no contiene gluten ni lactosa, es fácil de llevar y no necesita agua, se convertirá en una valiosa herramienta terapéutica que puede mejorar la calidad de vida de sus pacientes. I

01 febrero

02 febrero

20 febrero
Las enfermedades bucodentales han afectado a la humanidad desde sus mismos inicios, en especial el dolor agudo dentario producido por una caries profunda o un absceso periapical. Técnicas curativas y rehabilitadoras han sido practicadas por muchos médicos a lo largo de la historia. Teniendo en cuenta la íntima relación existente entre las enfermedades y padecimientos de la cavidad oral con la calidad de vida de las personas, se han recomendado una serie de cuidados bucales por las diferentes sociedades odontológicas internacionales y regionales. La práctica de la odontología es dinámica y sigue evolucionando, es por esto que la formación es un aprendizaje continuo. Las actividades de educación continua son indispensables para el desarrollo profesional de los especialistas, permitiendo estar al corriente del progreso de los avances médicos y odontológicos, mantener los conocimientos y la experiencia necesaria para prestar una atención de alta calidad.

22 marzo
Menarini Centroamérica y el Caribe busca minimizar esta brecha digital y facilitarle a los profesionales de la salud la capacidad de comprender de manera directa cómo esta transformación digital, que está sucediendo de forma acelerada en todas las industrias, impacta directamente en su práctica clínica diaria, tomando en cuenta que el uso de nuevas tecnologías serán de gran beneficio para la relación médico-paciente. El objetivo principal del III Curso de Transformación Digital es poner a disposición de los profesionales de la salud los conocimientos necesarios por parte de ponentes referentes internacionales y regionales de gran prestigio en el ámbito de la salud digital, para que comprendan y aprovechen el uso de estas herramientas y puedan gestionarlas de mejor manera, llevando su práctica clínica al siguiente nivel, dando el salto a un liderazgo digital efectivo.

14 febrero
La atención primaria de salud es la asistencia sanitaria esencial accesible a todos los individuos adoptando una visión holística de la salud que va mucho más allá del limitado modelo médico. La educación médica continua en atención primaria tiene como finalidad proporcionar conocimiento válido, útil y preciso que permita tomar decisiones dirigidas a prestar una asistencia sanitaria a la población, más adecuada a sus necesidades, más efectiva y de mayor seguridad y calidad. Grupo Menarini Centroamérica y el Caribe, tomando en cuenta que la Atención Primaria es la base del sistema de salud de cualquier país y al mismo tiempo es la solución de los problemas más comunes que aquejan a la población latinoamericana, considera que es de vital importancia proveer las herramientas necesarias al profesional de salud para enfrentar su entorno cada vez más demandante.

03 octubre

09 marzo
PROGRAMA DE EDUCACIÓN MÉDICA CONTINUA, ORGANIZADO POR EL HOSPITAL EL PILAR Y PATROCINADO POR ÁREA CIENTÍFICA MENARINI.

15 mayo
Área Científica MENARINI y CGE desean fortalecer una cultura de calidad asistencial en la Región Centroamericana y El Caribe, esperando satisfacer las expectativas del gremio de enfermería hospitalaria. Al realizar el VII Simposium Centroamericano y del Caribe de Enfermería de Hospital en su versión Online, deseamos lograr un consenso para fortalecer el manejo de tromboprofilaxis y protocolización del manejo del dolor en los diferentes escenarios hospitalarios, fundamentados en experiencia clínica y científica, aportando como Grupo Menarini formación científica de alto nivel y temas de vanguardia al gremio de enfermería, comprometido con la calidad asistencial, en el abordaje terapéutico del paciente hospitalizado.

09 octubre
La mayoría de las ETV ocurren después de que el paciente es dado de alta hospitalaria, secundaria a una intervención quirúrgica o estancia en reposo prolongado. Hay que individualizar los riesgos de cada paciente para brindar la tromboprofilaxis y tener presente que cualquier modalidad que se utilice, debe estar de acuerdo con las entidades que se han dado a la tarea de establecer guías para el beneficio de nuestros pacientes. Un hospital que protocoliza, es un hospital que protege. Uno de los objetivos de este XIV Foro Multidisciplinario Online de Expertos en Tromboprofilaxis de Centroamérica y El Caribe es actualizar el conocimiento y brindar educación médica continua de tromboprofilaxis y permitir el intercambio de experiencias en la aplicación de protocolos apegados a las guías internacionales, para que la embolia pulmonar deje de ser la causa principal de muerte

21 agosto
El comercio minorista es uno de los sectores más importantes y dinámicos de la economía de cualquier país, ya que a través de él se operan volúmenes que hacen que tenga un peso relevante dentro del producto interno bruto, por lo cual se hace necesario que los jugadores que en él se desempeñan se adapten a los continuos cambios que sufren. En el último tiempo, se ha producido una saturación de aperturas de tiendas, en diferentes formatos. Hipermercados, supermercados, tiendas de conveniencia y farmacias, que abren el abanico de opciones a los compradores que están buscando satisfacer diversas misiones de compra: llenado, relleno, impulso, entre otras. Por otro lado, en el mercado farmacéutico, existe una creciente multiplicación de proveedores, marcas y presentaciones, con la que se genera la necesidad de colaboración entre proveedores y distribuidores, introduciendo de este modo a la relación netamente comercial, otros elementos que buscan beneficio mutuo como la información relevante del consumidor y comprador, la infraestructura del punto de venta y el talento humano capacitado para la atención y las demandas de los consumidores.

24 agosto
El punto de venta farmacéutico es hoy en día uno de los mercados más competitivos a nivel centroamericano, esto ha generado que las farmacias busquen diferenciarse de sus competidores no solo a nivel de precios sino a través del servicio al cliente y el valor agregado que invite al consumidor a vivir una experiencia de compra diferenciada. El temario de este VIII Simposium ha sido enfocado para ser expuesto por ponentes profesionales del ámbito de los negocios y profesionales de la salud; líderes de opinión en sus áreas y que por su experiencia y trayectoria, pueden compartir con los asistentes al evento información vital y con altos estándares técnico-científicos. Esperamos de esta manera colaborar con el enriquecimiento intelectual del gremio farmacéutico y asistentes de farmacia para garantizar el profesionalismo y una dispensación de medicamentos responsable

03 julio
El XVI Simposium Centroamericano y Del Caribe Multidisciplinario de Enfermedades Alérgicas y de Piel está orientado al manejo integral de las enfermedades alérgicas, enfocándose principalmente en rinitis y urticaria, mediante presentaciones y debates de temas de actualidad. Además, resaltará la importancia de un manejo más profundo de estas patologías a través de métodos que permitan al médico tener el control de los síntomas asociados y brindarle a cada uno de los pacientes una mejor calidad de vida. Las guías recomiendan a los antihistamínicos de segunda generación, como tratamientos de primera línea en el control de los síntomas relacionados a los procesos alérgicos. Rupatadina es un nuevo antihistamínico de segunda generación, y antagonista del PAF (factor activador plaquetario), posee un perfil bioquímico que lo hace no sedante, selectivo, de acción prolongada, que carece de efectos indeseables, lo que lo convierte en un medicamento seguro y eficaz.

10 julio
Desafortunadamente, todas estas enfermedades tienen todavía un elevado número de necesidades insatisfechas, debido en ocasiones a la falta de actualización en el conocimiento científico de los mecanismos de la enfermedad, su prevención, la atención de los pacientes, los determinantes sociales y el abordaje terapéutico óptimo que aún no se ha resuelto. Es por ésto que la difusión de las guías de práctica clínica basadas en la evidencia es la manera ideal de informar y orientar a los médicos que manejan estas patologías. En el deseo de contribuir a combatir este enorme problema global de las enfermedades alérgicas y sus asociaciones hemos decidido desarrollar y presentar este IX Master Class Online en Guías de Práctica Clínica en Rinitis, Rinosinusitis, Asma y Urticaria, cuyo enfoque principal será el abordaje diagnóstico y el tratamiento óptimo y oportuno de cada una de ellas, tomando como base las guías de prestigiosas asociaciones europeas y globales como: ARIA,1-2 EPOS,3 EAACI-GA2 LEN,4 y GINA,5 respectivamente. Esta actividad cuenta con el aval de: EAACI, ARIA, EPOS, ERS y GA2 LEN.*

30 mayo
Grupo Menarini, a través de Área Científica, consciente de la necesidad e importancia de la educación médica continua y de proporcionar a los odontólogos agentes anestésicos locales innovadores de alta confianza y seguridad, realiza la actividad de lanzamiento “Actualización en Técnicas y Anestésicos Locales en Odontoestomatología” con el fin de transmitir conocimiento sobre las técnicas anestésicas más actuales y los diferentes agentes anestésicos, su uso, selección y manejo para que el odontólogo realice un control del dolor efectivo para beneficio de la persona que merece todo el esfuerzo por parte del profesional para obtener el mejor resultado, el paciente.

02 octubre
Los síntomas de la HPB pueden tener un impacto significativo en la calidad de vida de los hombres que los experimentan, afectando sus actividades diarias y su bienestar emocional. La frecuencia de los síntomas aumenta con la edad, y los hombres mayores con HPB pueden experimentar una disminución en la calidad de vida significativa debido a la necesidad de orinar con frecuencia, la dificultad para orinar, la necesidad urgente de orinar y la incontinencia urinaria. 2 Es esencial que los urólogos, médicos generales y dependientes de farmacia estén actualizados en cuanto a los avances más recientes en el diagnóstico y tratamientos de los STUI relacionados con la HPB. Este primer seminario de actualización tiene como objetivo proporcionar a los participantes información relevante y actualizada sobre los diversos enfoques terapéuticos disponibles, desde la fitoterapia hasta la combinación de fármacos, así como destacar el papel crucial que desempeña el dependiente farmacéutico en la detección temprana de los síntomas de HPB. 3

18 mayo
PROGRAMA DE EDUCACIÓN MÉDICA CONTINUA, ORGANIZADO POR EL HOSPITAL EL PILAR Y PATROCINADO POR ÁREA CIENTÍFICA MENARINI.

14 junio
PROGRAMA DE EDUCACIÓN MÉDICA CONTINUA, ORGANIZADO POR EL HOSPITAL EL PILAR Y PATROCINADO POR ÁREA CIENTÍFICA MENARINI.

07 agosto

07 agosto
Durante las últimas décadas, hemos observado cambios sustanciales en la práctica médica de los trastornos gastrointestinales, ya que los conocimientos, técnicas y procedimientos sufren modificaciones permanentemente, surgiendo la necesidad de actualizar y mantener la competencia profesional. El desarrollo profesional médico continuo, se lleva a cabo cuando el conocimiento teórico actualizado periódicamente (incluyendo formación en gestión, calidad, bioética y medicina basada en evidencia) se traslada a la práctica profesional, donde se conjuga con la experiencia y juicio crítico del médico y otros colegas, ofreciendo el mejor escenario para mantener y mejorar la competencia profesional. La educación médica continua en gastroenterología es un proceso de enseñanza-aprendizaje activo, con el fin de mejorar las capacidades frente a la evolución científica-tecnológica y los cambios en las necesidades sociales, para obtener nuevos conocimientos, valorando la vigencia de los adquiridos y complementando las carencias de manera que los resultados del ejercicio profesional sean de máxima calidad. Actualmente, dichas actividades se dirigen a mejorar la capacidad diagnóstica de las principales

21 agosto
El comercio minorista es uno de los sectores más importantes y dinámicos de la economía de cualquier país, ya que a través de él se operan volúmenes que hacen que tenga un peso relevante dentro del producto interno bruto, por lo cual se hace necesario que los jugadores que en él se desempeñan se adapten a los continuos cambios que sufren. En el último tiempo, se ha producido una saturación de aperturas de tiendas, en diferentes formatos. Hipermercados, supermercados, tiendas de conveniencia y farmacias, que abren el abanico de opciones a los compradores que están buscando satisfacer diversas misiones de compra: llenado, relleno, impulso, entre otras. Por otro lado, en el mercado farmacéutico, existe una creciente multiplicación de proveedores, marcas y presentaciones, con la que se genera la necesidad de colaboración entre proveedores y distribuidores, introduciendo de este modo a la relación netamente comercial, otros elementos que buscan beneficio mutuo como la información relevante del consumidor y comprador, la infraestructura del punto de venta y el talento humano capacitado para la atención y las demandas de los consumidores.

11 septiembre
El I Foro Multidisciplinario Centroamericano y del Caribe de expertos en enfermedades infecciosas tiene como objetivo presentarles una nueva opción en antibioticoterapia, Cefditoren, una cefalosporina oral de tercera generación con características diferenciadoras respecto a otros integrantes de este grupo. Durante este foro realizaremos una revisión de lo que este antibiótico puede beneficiar a sus pacientes, tomando como punto de partida las tres claves para seleccionar el antibiótico oral adecuado, la efectividad, con el objetivo de lograr la máxima erradicación microbiológica utilizando el antibiótico con el espectro más restringido posible, la seguridad, minimizando la probabilidad de aparición de efectos adversos relacionados con el antibiótico, especialmente aquellos más graves y la ecología, procurando tener el menor impacto posible sobre la microbiota, ya que la pérdida de su diversidad conduce a una mayor vulnerabilidad a la infección y a la selección de resistencias.

05 diciembre

21 noviembre
En esta ocasión, le presentamos el XI SIMPOSIUM CENTROAMERICANO Y DEL CARIBE DE FARMACÉUTICOS DE HOSPITAL donde se amplían las áreas terapéuticas en las que profundizaremos con excelencia científica. Los tópicos principales serán la farmacovigilancia, enfermedad tromboembólica venosa, uso de heparinas de bajo peso molecular y anticoagulación oral; dolor agudo, gluco corticoterapia, dolor visceral, crisis hipertensiva, entre otros. Pero no todo será conocimiento científico puro, porque necesitamos más que eso como profesión. Se necesita visión, objetivos, determinación y confianza en el desarrollo profesional como proveedores de valor asistencial a los pacientes. Necesitamos el qué, el por qué y el cómo, y por eso también se tratan estos temas en el programa que ha sido preparado de forma integral. Esta época de pandemia en donde todos hemos aprendido a volvernos a inventar, exige que tengamos conocimientos diversos tanto científico como personal. Esperamos que este programa sea de gran ayuda para los asistentes y que aporte mucho a su formación integral profesional.

20 noviembre
En esta ocasión, le presentamos el III MASTER COURSE CENTROAMERICANO Y DEL CARIBE DE FARMACOECONOMÍA EN FARMACIA HOSPITALARIA donde se amplían las áreas terapéuticas en las que profundizaremos con excelencia científica. Los tópicos principales serán la farmacovigilancia, enfermedad tromboembólica venosa, uso de heparinas de bajo peso molecular y anticoagulación oral; dolor agudo, gluco corticoterapia, dolor visceral, crisis hipertensiva, entre otros. Pero no todo será conocimiento científico puro, porque necesitamos más que eso como profesión. Se necesita visión, objetivos, determinación y confianza en el desarrollo profesional como proveedores de valor asistencial a los pacientes. Necesitamos el qué, el por qué y el cómo, y por eso también se tratan estos temas en el programa que ha sido preparado de forma integral. Esta época de pandemia en donde todos hemos aprendido a volvernos a inventar, exige que tengamos conocimientos diversos tanto científico como personal. Esperamos que este programa sea de gran ayuda para los asistentes y que aporte mucho a su formación integral profesional.

19 octubre

06 noviembre
La educación médica continua es el medio que, desde hace muchos años, han utilizado los profesionales de la salud para el proceso ininterrumpido de aprendizaje que deben seguir para mantenerse actualizados considerando los continuos avances en la ciencia biosanitaria. La misma debe responder a las necesidades que día a día aparecen en las consultas de los profesionales de la salud y el área de Ginecología y Obstetricia no se queda atrás. Este V Simposium busca fomentar el trabajo multidisciplinario y el abordaje integral de los temas relevantes en la salud femenina, con especial énfasis en el embarazo de alto riesgo y dolor postoperatorio en los diferentes escenarios clínicos, permitiendo el intercambio de experiencias clínicas y científicas, aportando como Área Científica formación de alto nivel y temas de vanguardia.

06 noviembre
La educación médica continua es el medio que, desde hace muchos años, han utilizado los profesionales de la salud para el proceso ininterrumpido de aprendizaje que deben seguir para mantenerse actualizados considerando los continuos avances en la ciencia biosanitaria. La misma debe responder a las necesidades que día a día aparecen en las consultas de los profesionales de la salud y el área de Ginecología y Obstetricia no se queda atrás. Este V Simposium busca fomentar el trabajo multidisciplinario y el abordaje integral de los temas relevantes en la salud femenina, con especial énfasis en el embarazo de alto riesgo y dolor postoperatorio en los diferentes escenarios clínicos, permitiendo el intercambio de experiencias clínicas y científicas, aportando como Área Científica formación de alto nivel y temas de vanguardia.

05 marzo
Consciente de la importancia de la labor del Higienista Dental, Grupo Menarini Centroamérica y el Caribe, desarrolla este programa de Educación Médica Continua enfocado en brindar educación y formación actualizada al gremio de Higienistas, Asistentes Dentales de la región Centroamericana con el II Curso Centroamericano y del Caribe de Actualización para Higienistas /Asistentes Dentales y generar la discusión de los casos y perfiles de trabajo dentro de la clínica dental, siempre en la búsqueda de la mejora continua de la atención del paciente.

12 febrero
El XIII Simposium Centroamericano y del Caribe de Actualización en Atención Primaria, tiene como objetivo facilitar al profesional de la salud, la capacidad de comprender de manera directa la complejidad de las principales patologías que aquejan a nuestra sociedad, de tal forma que se implemente la prevención y el correcto abordaje y tratamiento de estas patologías.

18 marzo
Como Área Científica Menarini, estamos comprometidos de todo corazón con la actualización y educación médica continua con ponentes internacionales y regionales, referentes en el tratamiento de esta condición crónica que incide en la calidad de vida de la población a nivel mundial y esperamos que este simposio llene sus expectativas académicas y de actualización en el ámbito del abordaje del Síndrome Coronario Crónico

24 junio
La deficiencia de Vitamina D es una problemática que actualmente está padeciendo la población en general especialmente adultos mayores, jóvenes y niños. Los principales factores que afectan los niveles de vitamina D, son entre otros: cambios en el estilo de vida, que incluye la poca exposición al sol diariamente, aplicación de filtros solares, edad, obesidad y el uso de algunos tratamientos farmacológicos. Siempre se ha relacionado la vitamina D con el metabolismo fosfocálcico, sin embargo, en investigaciones más recientes, se ha encontrado receptores de vitamina D o de sus metabolitos en otras células del organismo. Grupo Menarini Centroamérica y el Caribe, siempre comprometido con la educación médica continua y las problemáticas actuales, organiza el II Foro Centroamericano y del Caribe Multidisciplinario de Expertos en Vitamina D, donde se abordarán temas relacionados a los riesgos de padecer esta deficiencia, pero también las soluciones para mejorar la calidad de vida de los pacientes.

26 agosto
La población pediátrica se encuentra expuesta a diferentes tipos de ambientes, los cuales tienen una profunda influencia en su crecimiento y desarrollo. Las exposiciones medioambientales, son tanto nocivas como beneficiosas para la salud, y no funcionan por separado, sino que interactúan como determinantes sociales y nutricionales de la salud, para influir en el bienestar de cada uno de ellos. Sean cuales sean los recursos naturales y el nivel de desarrollo económico, para todos los países y todas las comunidades, la población pediátrica representa el futuro, el cual debe cultivarse y protegerse. Por lo cual en el V Simposium Centroamericano y del Caribe Multidisciplinario de Actualización en Pediatría, se abordarán temas de relevancia científica y actualidad en el manejo de patologías presentes en el consultorio como lo son: las enfermedades respiratorias, alérgicas y gastrointestinales, además del adecuado manejo de la salud bucal en el paciente pediátrico.

15 abril
La calidad asistencial hospitalaria, se define como “el conjunto de propiedades y características de un servicio que le confiere su aptitud para satisfacer las necesidades expresadas o implícitas de los pacientes”. Conseguir un nivel de calidad óptimo equivale, por tanto, a desarrollar grados de efectividad, de eficiencia, de adecuación y de calidad científico-técnica en la práctica asistencial que satisfagan por igual a administradores, profesionales y usuarios. Además se debe proveer la elaboración y cumplimiento de protocolos que prevengan riesgos y complicaciones a los pacientes hospitalizados, tales como: Tromboprofilaxis, tratamiento de la enfermedad tromboembólica venosa (ETV) en su fase aguda y a largo plazo y manejo adecuado del dolor. Área Científica MENARINI y el CGE desean fortalecer una cultura de calidad asistencial en la Región Centroamericana y El Caribe, esperando satisfacer las expectativas del gremio de enfermería hospitalaria. Al realizar el VIII Simposium Centroamericano y del Caribe de Enfermería de Hospital en su versión Online, deseamos lograr un consenso para fortalecer el manejo de Tromboprofilaxis y protocolización del manejo del dolor agudo.

22 julio
Las enfermedades bucodentales han afectado a la humanidad desde sus mismos inicios, en especial el dolor agudo dentario producido por una caries profunda o un absceso periapical. Técnicas curativas y rehabilitadoras han sido practicadas por muchos médicos a lo largo de la historia. Grupo Menarini, a través de Área Científica Menarini, consciente de la necesidad e importancia de la Educación Médica Continua, realiza el XV Simposium Centroamericano y del Caribe de Actualización en Odontoestomatología, con el fin de transmitir el conocimiento de causa y efecto de cualquier patología oral con todos los pormenores y generar discusión de los casos odontológicos presentados, con los colegas de las diferentes áreas y especialidades médicas que darán como resultado un diagnóstico más seguro de la entidad que está en curso y un tratamiento efectivo para beneficio de la persona que merece todo el esfuerzo por parte del profesional para obtener el mejor resultado del paciente.

18 noviembre
Las enfermedades infecciosas representan un grave problema de salud global, la cual se asocia a una elevada morbimortalidad. La medicina actual ha cambiado el panorama de las enfermedades infecciosas por múltiples razones, pacientes geriátricos con comorbilidades, sometidos a procedimientos diagnósticos y terapéuticos más invasivos que propician la infección, además de la utilización de diferentes inmunomoduladores que han cambiado el espectro etiológico de las infecciones, así como la aparición de un nivel de resistencias y modificaciones de la microbiota como no se ha visto hasta ahora, cuya principal consecuencia es la dificultad de acertar con el tratamiento antimicrobiano empírico que incrementa de forma significativa la mortalidad en las infecciones graves. El II Foro Multidisciplinario Centroamericano y del Caribe de Expertos en Enfermedades Infecciosas tiene como objetivo presentarles una nueva opción en antibioticoterapia, Cefditoren, una cefalosporina oral de tercera generación con características diferenciadoras respecto a otros integrantes de este grupo.

22 abril
La importancia de las enfermedades alérgicas radica en su propia naturaleza. Son procesos muy frecuentes, que afectan al paciente, en las fases de su vida en las que la producción laboral o académica es más intensa, además interfieren de forma significativa en las actividades cotidianas y perturban el sueño a menudo. Las consecuencias socioeconómicas de todos estos aspectos son muy importantes y muy superiores a las que hace solo unas cuantas décadas se les atribuía. El XVII Simposium Centroamericano y Del Caribe Multidisciplinario de Enfermedades Alérgicas y de Piel está orientado al manejo integral de las enfermedades alérgicas, enfocándose principalmente en rinitis y urticaria, mediante presentaciones y debates de temas de actualidad. Además, resaltará la importancia de un manejo más profundo de estas patologías a través de métodos que permitan al médico tener el control de los síntomas asociados y brindarle a cada uno de los pacientes una mejor calidad de vida.

29 abril
Las enfermedades alérgicas afectan actualmente a más de 1,000 millones de personas en el mundo y su prevalencia continúa en aumento, esperándose duplicar o incluso triplicar esta cifra para el año 2,050 (50% de la población). Entre las enfermedades alérgicas y sus asociaciones más comunes se encuentran la rinitis/conjuntivitis y asma alérgica, la rinosinusitis con o sin poliposis nasosinusal y la urticaria crónica. La rinitis alérgica (RA) representa un problema de salud mundial que afecta del 10 al 20% de la población total, lo que la convierte en la enfermedad crónica no transmisible de mayor prevalencia En el deseo de contribuir a combatir este enorme problema global de las enfermedades alérgicas y sus asociaciones hemos decidido desarrollar y presentar este X Master Class Online en Guías de Práctica Clínica en Rinitis, Rinosinusitis, Asma y Urticaria, cuyo enfoque principal será el abordaje diagnóstico y el tratamiento óptimo y oportuno de cada una de ellas, tomando como base las guías de prestigiosas asociaciones europeas y globales como: ARIA,1-2 EPOS,3 EAACI-GA2 LEN,4 y GINA,5 respectivamente. Esta actividad cuenta con el aval de: EAACI, ARIA, EPOS, ERS y GA2 LEN.

16 septiembre
El punto de venta farmacéutico es hoy en día uno de los mercados más competitivos a nivel centroamericano, esto ha generado que las farmacias busquen diferenciarse de sus competidores no solo a nivel de precios sino a través del servicio al cliente y el valor agregado que invite al consumidor a vivir una experiencia de compra diferenciada. El IX Simposium Centroamericano y del Caribe de Actualización en Atención Farmacéutica en su versión Online, dirige su máximo esfuerzo en la actualización del personal de farmacia de los principales retailers farmacéuticos de la región y del personal de contacto con el usuario final, proporcionando un medio por el cual el asistente reciba información técnico científica encaminada a la profesionalización de la administración de categorías, la mejora de habilidades comerciales, servicio al cliente y la adecuada orientación y utilización de medicamentos de calidad.

20 junio
En el mercado farmacéutico, existe una creciente multiplicación de proveedores, marcas y presentaciones, con la que se genera la necesidad de colaboración entre proveedores y distribuidores, introduciendo de este modo a la relación netamente comercial, otros elementos que buscan beneficio mutuo como la información relevante del consumidor y comprador, la infraestructura del punto de venta y el talento humano capacitado para la atención y las demandas de los consumidores. Asimismo, la nueva normalidad ha acelerado el proceso de transformación digital en todos los sectores y el punto de venta farmacéutico no es ajeno a esta situación. Es por esto que Área Científica Menarini, comprometido con la formación del gremio farmacéutico, da origen al IX Seminario Centroamericano y del Caribe de Administración de Categorías para el Retail Farmacéutico en su versión Online, el cual busca apoyar las necesidades formativas y el desarrollo técnico en esta disciplina, para las farmacias de la región.

05 agosto
Hablar sobre problemas sexuales es siempre complicado y provoca vergüenza y ansiedad, especialmente para los hombres. Sin embargo, es quizás aún más difícil porque ésto no es siempre visto como un problema médico real con una causa y tratamientos viables. En cualquier caso, la consulta con un médico es recomendada para un correcto diagnóstico y tratamiento. Grupo Menarini consciente de la necesidad de la educación médica continua de calidad en el gremio médico, teniendo en cuenta que tiene su núcleo fundamental en el autoaprendizaje individual, realiza este tipo de actividades a nivel mundial y se ha constituido como líder indiscutible en eventos de alto nivel científico en Centroamérica y el Caribe. Este V Curso Centroamericano y del Caribe de Salud Sexual tiene como objetivo el promover y facilitar a los médicos con educación médica continua en el ámbito de salud sexual, y de los avances en su manejo clínico y tratamiento que permitan una mejoría importante en la salud sexual y mental del hombre y su pareja.

08 abril
Como Área Científica Menarini, nuestro principal interés es la actualización y la educación médica continua, con ponentes referentes de diferentes especialidades implicadas en el abordaje de las infecciones.

21 octubre
El dolor postoperatorio es en la actualidad uno de los problemas asistenciales más comunes en los hospitales, a pesar de los medios terapéuticos que se disponen para su tratamiento. Incide en la morbimortalidad y en la satisfacción de los pacientes e incrementa los costos hospitalarios. Es por ello que en este XVI Simposium Centroamericano y del Caribe Online de Actualización de Dolor Postoperatorio abordaremos temas útiles para la formación médica continua, para afianzar la protocolización según información científica y experiencia clínica de expertos en el manejo del dolor postoperatorio, haciendo hincapié en la necesaria colaboración multidisciplinaria de médicos especialistas para una mejor recuperación del paciente.

25 noviembre
La necesidad de tratar las enfermedades autoinmunes se enfatiza por el hecho que estas afectan a millones de personas a nivel mundial y constituyen una de las principales causas de muerte principalmente en mujeres menores de 65 años. Aunque pueden afectar a cualquiera, más mujeres que hombres padecen estas enfermedades y frecuentemente se presentan durante la etapa reproductiva. En la actualidad se realizan esfuerzos por mejorar tanto el diagnóstico como los tratamientos de estas enfermedades. El programa científico de este simposium, a través de las conferencias y las discusiones, revisará no solo las modalidades básicas del diagnóstico y tratamiento, sino que también abarcará la evidencia proveniente de los estudios más recientes y revisiones a profundidad de la autoinmunidad que han dado paso a las últimas innovaciones en las modalidades de tratamiento con énfasis en Lupus Eritematoso Sistémico, Síndrome Antifosfolípido y su manejo adecuado durante el embarazo, la lactancia y el papel que desempeña la vitamina D en el tratamiento de estas enfermedades.

04 noviembre
La Hiperplasia Prostática Benigna (HPB) es una condición médica común en hombres mayores de 50 años, que se caracteriza por el crecimiento anormal de la glándula prostática y puede resultar en síntomas del tracto urinario inferior (STUI). Se estima que en todo el mundo, alrededor del 50% de los hombres mayores de 50 años tienen síntomas relacionados con la HPB. En América Latina, la prevalencia de HPB se estima en un 50%, con una mayor incidencia en hombres mayores de 70 años. Es esencial que los urólogos, médicos generales y dependientes de farmacia estén actualizados en cuanto a los avances más recientes en el diagnóstico y tratamientos de los STUI relacionados con la HPB. Este segundo seminario de actualización tiene como objetivo proporcionar a los participantes información relevante y actualizada sobre los diversos enfoques terapéuticos disponibles, desde la fitoterapia hasta la combinación de fármacos, así como destacar el papel crucial que desempeña el dependiente farmacéutico en la detección temprana de los síntomas de HPB.

15 julio
Grupo Menarini, a través de Área Científica Menarini, ha sido pionera en la implementación de la educación continua en las diferentes ramas que brindan atención en la salud de la población en general. Dentro de este contexto, los ginecólogos y obstetras juegan un papel fundamental en el cuidado integral de la salud de la mayor parte de la población, atendiendo las necesidades de la mujer a lo largo de su vida. Este VI Simposium busca fomentar el trabajo multidisciplinario y el abordaje integral de los temas relevantes en la salud femenina, con especial énfasis en el embarazo de alto riesgo y dolor postoperatorio en los diferentes escenarios clínicos, permitiendo el intercambio de experiencias clínicas y científicas, aportando como Área Científica formación de alto nivel y temas de vanguardia.

19 agosto
Durante las últimas décadas, hemos observado cambios sustanciales en la práctica médica de los trastornos gastrointestinales, ya que los conocimientos, técnicas y procedimientos sufren modificaciones permanentemente, surgiendo la necesidad de actualizar y mantener la competencia profesional. El desarrollo profesional médico continuo, se lleva a cabo cuando el conocimiento teórico actualizado periódicamente (incluyendo formación en gestión, calidad, bioética y medicina basada en evidencia) se traslada a la práctica profesional, donde se conjuga con la experiencia y juicio crítico del médico y otros colegas, ofreciendo el mejor escenario para mantener y mejorar la competencia profesional. Es por ello que, hemos elaborado el programa del XII Simposium Centroamericano y del Caribe de Actualización en Enfermedades Digestivas basándonos en la importancia de dar a conocer información médica actualizada, a través de casos clínicos, ponencias y discusiones, de temática diversa que abarca los avances actualizados en el manejo clínico y tratamiento de las principales enfermedades digestivas.

09 septiembre
Tenemos el placer de invitarle a participar en el XI Master Course Centroamericano y del Caribe de Patología Quirúrgica Musculoesquelética. Un año más, Área Científica Menarini ha tomado la iniciativa de patrocinar este proyecto. Se trata de una cita para la actualización académica y también una oportunidad de intercambiar experiencias con otros especialistas. Creemos en la necesidad de estas actividades docentes en nuestra especialidad, siempre dinámica y en constante renovación. Durante cinco jornadas, los especialistas y médicos residentes dispondrán de una amplia oferta formativa, con la presentación de 19 ponencias, distribuidas en 5 módulos. Para ello contaremos con experimentados cirujanos que mantendrán la cercanía necesaria para que la reunión sea de lo más provechosa e interesante para todos. Sólo nos queda animarle a conocer nuestra manera de emplear las técnicas descritas en los temas seleccionados y a participar de la enriquecedora discusión que se establecerá dentro de esta reunión, que hemos preparado con nuestra mayor ilusión.

14 octubre
Este IV Simposium Centroamericano y del Caribe de Actualización Integral en Anticoagulación tiene como objetivo concientizar acerca de la carga de mortalidad causada por la trombosis en general, la necesidad de acción y, más específicamente, la amenaza no reconocida y las graves consecuencias de la ETV y la FA. Así mismo, los investigadores y ponentes principales a nivel mundial de estas condiciones, compartirán su experiencia en distintos escenarios que permitan una actualización importante en su abordaje integral. En MENARINI seguimos apostando por mejorar de Todo Corazón la Salud Cardiovascular de sus pacientes.

02 diciembre
La farmacia hospitalaria es el servicio de atención médica que se encarga de elegir, preparar, almacenar, combinar y dispensar medicamentos y productos sanitarios, asesorando a profesionales de la salud y pacientes sobre su uso seguro, efectivo y eficiente. Es la profesión que se esfuerza por mantener y mejorar continuamente la gestión de medicamentos y la atención farmacéutica de los pacientes con los más altos estándares en un entorno hospitalario. La seguridad en el uso de medicamentos siempre es uno de los ejes fundamentales sobre los que deben basarse los procesos de la atención farmacéutica en cualquiera de sus ámbitos de ejecución o la adherencia al tratamiento, al ser éste un elemento clave para el éxito de cualquier terapia con medicamentos.

28 octubre
El personal que está a cargo de las emergencias debe ser muy profesional, capacitado y acreditado, para la atención de forma inmediata. Es por ello, que tenemos a bien presentarles el IV SIMPOSIO CENTROAMERICANO Y DEL CARIBE DE EMERGENCIAS MÉDICAS, en donde se abordará a lo largo de tres sesiones algunos de los motivos de consulta más frecuentes a nivel de emergencia, con ponentes de referencia que aportarán a la educación médica continua de la región.

08 julio
Las enfermedades cardiovasculares constituyen una de las causas más importantes de discapacidad y muerte prematura en todo el mundo. El problema subyacente es la aterosclerosis, que progresa a lo largo de los años, de modo que cuando aparecen los síntomas, generalmente a mediana edad, suele estar en una fase avanzada. Los episodios coronarios y cerebrovasculares agudos se producen de forma repentina y conducen a menudo a la muerte antes de que pueda brindarse la atención médica requerida. Debido a la relevancia epidemiológica de las enfermedades cardiovasculares y considerando que su morbilidad representa un alto costo para nuestros países y las familias afectadas, el objetivo de este XVIII Simposium Centroamericano y del Caribe Online de Actualización en Enfermedad Cardiovascular es fortalecer los conocimientos sobre las enfermedades cardiovasculares, así como promover la conciencia sobre la importancia de la modificación de los hábitos de vida dirigida a reducir los factores de riesgo que conforman la enfermedad cardiovascular.

02 julio
La hipertensión arterial y la cardiopatía isquémica, constituyen la principal causa de mortalidad en el mundo y por ello es considerada la pandemia del tercer milenio. Si bien en la actualidad se hace mucho hincapié en el riesgo cardiovascular general derivado de la combinación de una Presión Arterial (PA) elevada, la presencia de factores de riesgo cardiovascular, la diabetes mellitus, el síndrome metabólico y el daño orgánico subclínico o establecido, el nivel de la PA por sí sola está íntimamente relacionado con el riesgo de mortalidad por motivos cardiovasculares. La Sociedad Europea de Hipertensión (ESH) y la Sociedad Interamericana de Hipertensión (ISH) conscientes de la necesidad de la educación médica continua de calidad en el gremio médico y teniendo en cuenta que tiene su núcleo fundamental en el autoaprendizaje individual, realiza este XIV Master Course Online en Hipertensión y Riesgo Cardiovascular, para compartir el conocimiento y crear una relación científica entre las Sociedades y los especialistas de esta región en la actualización del diagnóstico y tratamiento de la hipertensión arterial y sus factores de riesgo.

09 mayo

24 julio
Hay un interés creciente en el papel de la aldosterona en la fisiopatología de la hipertensión arterial, la enfermedad cardiovascular y el deterioro de la función renal. El presente evento denominado Antagonistas de los receptores mineralocorticoides en enfermedad cardiorrenal recopila algunos de los hallazgos más relevantes en relación al uso de ARM en pacientes con patologías cardiovasculares, haciendo hincapié en sus aplicaciones terapéuticas actuales y potenciales. Grupo Menarini Centroamérica y el Caribe, consciente de la necesidad de la educación médica continua de calidad en el gremio médico, teniendo en cuenta que tiene su núcleo fundamental en el autoaprendizaje individual, realiza este tipo de actividades a nivel mundial y se ha constituido como el líder indiscutible en la educación médica continua en Centroamérica y el Caribe.

25 septiembre
El I Foro Centroamericano y Del Caribe Multidisciplinario de Enfermedades Respiratorias está orientado al manejo integral de las enfermedades respiratorias, enfocándose principalmente en una nueva terapia para el manejo de la tos, Sitocura, producto natural, con efecto expectorante y antitusivo utilizado para el tratamiento de los síntomas asociados a las vías respiratorias superiores y bronquitis crónica inflamatoria facilitando la expulsión de flemas. Además, resaltará la importancia de un manejo más profundo de estas patologías a través de métodos que permitan al médico tener el control de los síntomas asociados y brindarle a cada uno de los pacientes una mejor calidad de vida.

11 abril
Según La Organización Mundial de la Salud (OMS), el dolor es la “mayor amenaza” para la calidad de vida a nivel mundial, ya que conlleva importantes repercusiones clínicas con limitaciones de las actividades diarias, interrupción de la vida social, absentismo e incapacidad laboral. Paracetamol es uno de los fármacos más consumidos y prescritos a nivel mundial, debido a la eficacia y seguridad que tiene a la dosis recomendada. Dada su acción antipirética y analgésica. Paracetamol está indicado en el tratamiento de las enfermedades que cursen con dolor de leve a moderada intensidad y los estados febriles en adultos y niños. De hecho, su uso apenas tiene reacciones adversas y siempre que sea a corto plazo, está permitido durante la lactancia y el embarazo. Grupo Menarini, es pionera en comercializar el primer Paracetamol bebible en formato stick pack, forma farmacéutica que le confiere un rápido inicio de acción en el manejo del dolor agudo de leve a moderado y el control de la fiebre, bajo la marca Mencetamol®.

17 octubre

12 agosto
Grupo Menarini, a través de Área Científica Menarini, sigue siendo pionera en la implementación de la educación continua en las diferentes ramas que brindan atención en la salud de la población en general. Dentro de este contexto, la salud íntima femenina juega un papel fundamental en el cuidado integral de la mujer a lo largo de su vida. Por esta razón, este evento está dedicado a uno de los temas más relevantes en la salud femenina contemporánea: la higiene e hidratación íntima, con un propósito claro y apremiante: explorar cómo los avances en la ciencia y la innovación pueden ofrecer soluciones efectivas y seguras para la higiene íntima femenina, asegurando no solo la protección, sino también la libertad y comodidad de cada mujer, con productos de origen natural creados con componentes que han sido seleccionado con cuidado para ofrecer una solución suave y respetuosa con el cuerpo femenino, proporcionando una sensación de frescura y bienestar que perdura. Desde ya le agradecemos por acompañarnos en esta importante iniciativa hacia la salud íntima femenina!

09 octubre
Les presentamos el I Foro Virtual de Enfermedades Respiratorias. En un mundo en constante evolución, donde los profesionales de la salud enfrentamos nuevos desafíos día a día, es fundamental contar con soluciones innovadoras de dosis precisa. Este evento único les brindará las herramientas necesarias para estar a la vanguardia en el alivio de la tos y mejorar la calidad de vida de las personas. Esperamos que este evento nos permita entender el rol de la farmacia así como una fuente de inspiración y aprendizaje, proporcionando un espacio para el intercambio de ideas y el descubrimiento de nuevas soluciones.

29 julio
En el campo de la cardiología contemporánea, la fibrilación auricular emerge como un desafío clínico de magnitud creciente, con implicaciones significativas en la morbilidad y mortalidad cardiovascular. Ante este panorama, la actualización en anticoagulación se alza como un eje cardinal en la atención integral de los pacientes afectados por esta arritmia, constituyendo un elemento fundamental en la optimización del pronóstico y la calidad de vida. La complejidad fisiopatológica de la fibrilación auricular, caracterizada por la turbulencia eléctrica y mecánica en las aurículas, conlleva un riesgo incrementado de eventos tromboembólicos, tales como accidente cerebrovascular y embolia sistémica. En este contexto, el abordaje terapéutico anticoagulante surge como un pilar irremplazable, destinado a mitigar dicho riesgo y prevenir consecuencias devastadoras para la salud del paciente. La dinámica evolutiva de las terapias anticoagulantes exige un compromiso inquebrantable con la actualización científica y la excelencia clínica.

04 septiembre
Grupo Menarini, a través de Área Científica Menarini, sigue siendo pionera en la implementación de la educación continua en las diferentes ramas que brindan atención en la salud de la población en general. Dentro de este contexto, la salud íntima femenina juega un papel fundamental en el cuidado integral de la mujer a lo largo de su vida. Por esta razón, este evento está dedicado a uno de los temas más relevantes en la salud femenina contemporánea: la higiene e hidratación íntima, con un propósito claro y apremiante: explorar cómo los avances en la ciencia y la innovación pueden ofrecer soluciones efectivas y seguras para la higiene íntima femenina, asegurando no solo la protección, sino también la libertad y comodidad de cada mujer, con productos de origen natural creados con componentes que han sido seleccionado con cuidado para ofrecer una solución suave y respetuosa con el cuerpo femenino, proporcionando una sensación de frescura y bienestar que perdura. ¡Desde ya le agradecemos por acompañarnos en esta importante iniciativa hacia la salud íntima femenina!

11 diciembre
Este foro está dedicado a la actualización de las guías de manejo del síndrome coronario crónico (SCC), presentadas en el Congreso de la Sociedad Europea de Cardiología (ESC) 2024. Este evento está diseñado para brindar a los profesionales de la salud una revisión detallada de las últimas recomendaciones y estrategias basadas en la evidencia más reciente. El manejo del síndrome coronario crónico es fundamental en la práctica clínica cardiovascular, impactando a millones de pacientes en todo el mundo. La actualización de las guías ESC 2024 refleja avances significativos en nuestro entendimiento de la enfermedad coronaria, especialmente en la optimización de terapias farmacológicas.

06 diciembre
Este foro está dedicado a la actualización de las recomendaciones del uso de betabloqueadores según las Guías de Manejo de Hipertensión de la Sociedad Europea de Hipertensión (ESH); el evento está diseñado para brindar a los profesionales de la salud una revisión detallada de las últimas recomendaciones y estrategias basadas en la evidencia más reciente. El manejo de la hipertensión abarca un enfoque multifactorial y requiere la comprensión de los distintos factores de riesgo asociados a las complicaciones de esta patología, la elección de la terapia farmacológica deberá ser individualizada de acuerdo al perfil de riesgo de cada paciente; bajo esta premisa, el uso de betabloqueadores ha tenido una ventaja comparativa por su seguridad y eficacia demostrada en diversos perfiles de pacientes.

17 febrero
GRUPO MENARINI CENTROAMÉRICA Y EL CARIBE, TOMANDO EN CUENTA QUE LA ATENCIÓN PRIMARIA ES LA BASE DEL SISTEMA DE SALUD DE CUALQUIER PAÍS Y AL MISMO TIEMPO ES LA SOLUCIÓN DE LOS PROBLEMAS MÁS COMUNES QUE AQUEJAN A LA POBLACIÓN LATINOAMERICANA, CONSIDERA QUE ES DE VITAL IMPORTANCIA PROVEER LAS HERRAMIENTAS NECESARIAS AL PROFESIONAL DE SALUD PARA ENFRENTAR SU ENTORNO CADA VEZ MÁS DEMANDANTE. EL XIV SIMPOSIUM CENTROAMERICANO Y DEL CARIBE DE ACTUALIZACIÓN EN ATENCIÓN PRIMARIA, TIENE COMO OBJETIVO FACILITAR AL PROFESIONAL DE LA SALUD, LA CAPACIDAD DE COMPRENDER DE MANERA DIRECTA LA COMPLEJIDAD DE LAS PRINCIPALES PATOLOGÍAS QUE AQUEJAN A NUESTRA SOCIEDAD, DE TAL FORMA QUE SE IMPLEMENTE LA PREVENCIÓN Y EL CORRECTO ABORDAJE Y TRATAMIENTO DE ESTAS PATOLOGÍAS.

07 marzo
LA DIABETES MELLITUS TIPO 2 ES UNA ENFERMEDAD EN CONSTANTE CRECIMIENTO Y UN FACTOR DE RIESGO CLAVE PARA LAS ENFERMEDADES CARDIOVASCULARES. CON EL AUMENTO DE LA OBESIDAD Y LA INACTIVIDAD FÍSICA, SE ESPERA QUE EL NÚMERO DE CASOS SIGA EN ASCENSO, IMPACTANDO LA CALIDAD DE VIDA Y LA MORTALIDAD DE LOS PACIENTES. POR ELLO GRUPO MENARINI CENTROAMÉRICA EL CARIBE LE INVITA A ESTE EVENTO EDUCATIVO, DONDE EXPERTOS COMPARTIRÁN CONOCIMIENTOS CLAVE SOBRE EL MANEJO PERSONALIZADO DE LA DIABETES Y SUS COMORBILIDADES PARA REDUCIR COMPLICACIONES Y MEJORAR LOS RESULTADOS CLÍNICOS. ¡ÚNASE A NOSOTROS EN ESTA JORNADA DE ACTUALIZACIÓN MÉDICA!

18 marzo
La educación médica continua es el medio que, desde hace muchos años, han utilizado los profesionales de la salud para el proceso ininterrumpido de aprendizaje que deben seguir para mantenerse actualizados considerando los continuos avances en la ciencia biosanitaria. La misma debe responder a las necesidades que día a día aparecen en las consultas de los profesionales de la salud y el área de Ginecología y Obstetricia no se queda atrás. Este VII Simposium busca fomentar el trabajo multidisciplinario y el abordaje integral de los temas relevantes en la salud femenina, con especial énfasis en el embarazo de alto riesgo, dolor postoperatorio, anticoncepción, así como higiene e hidratación íntima, en los diferentes escenarios clínicos, permitiendo el intercambio de experiencias clínicas y científicas, aportando como Área Científica formación de alto nivel y temas de vanguardia.

21 abril
La importancia de las enfermedades alérgicas radica en su propia naturaleza. Son procesos muy frecuentes, que afectan al paciente, en las fases de su vida en las que la producción laboral o académica es más intensa, además interfieren de forma significativa en las actividades cotidianas y perturban el sueño a menudo. El XVII Simposium Centroamericano y Del Caribe Multidisciplinario de Enfermedades Alérgicas y de Piel está orientado al manejo integral de las enfermedades alérgicas, enfocándose principalmente en rinitis y urticaria, mediante presentaciones y debates de temas de actualidad.

28 abril
Las enfermedades alérgicas afectan a más de 1,000 millones de personas en el mundo, con un constante incremento, que se espera alcanzar el 50% de la población para el 2,050. Entre estas enfermedades, las más comunes son rinitis/conjuntivitis y asma alérgica, rinosinusitis con o sin poliposis nasosinusal y urticaria crónica. La rinitis es una enfermedad crónica no transmisible con una prevalencia del 10 al 20% de la población. Es de gran impacto en el sector económico y la calidad de vida del paciente. Por esto, el objetivo de este Master Class Online es contribuir al diagnóstico, abordaje y tratamiento de esta problemática global, por medio de actualizaciones de las Guías de Prácticas Clínicas de prestigiosas asociaciones europeas y globales como ARIA,1-2 EPOS,3 EAACI-GA2LEN,4 y GINA5, basadas en evidencia científica para formar a los médicos tratantes de estas patologías.

12 mayo
La calidad asistencial hospitalaria se define como el conjunto de características de un servicio que permiten satisfacer las necesidades de los pacientes, garantizando efectividad, eficiencia y adecuación en la atención. Para ello, es fundamental la implementación de protocolos que prevengan riesgos y complicaciones, como la tromboprofilaxis, el tratamiento de la enfermedad tromboembólica venosa (ETV) y el manejo adecuado del dolor. Además, la actualización constante del conocimiento científico del personal es clave para asegurar una atención de calidad, aunado a permanecer a la vanguardia en esta ocasión informando acerca de la aplicación de la Inteligencia Artificial en el campo.

28 octubre
El servicio de Emergencia es aquel ambiente dentro de un centro hospitalario, donde se prestan servicios de salud durante las veinticuatro horas del día a pacientes que demandan atención inmediata. . Es en este servicio en donde se evalúa al paciente, se prioriza el daño y se inicia el tratamiento para luego continuar con el manejo en las diferentes secciones del centro asistencial o bien de forma ambulatoria. A un servicio de emergencia pueden acudir diferentes pacientes con diversas patologías, desde una crisis hipertensiva, un dolor agudo tanto visceral como músculo-esquelético, una emergencia obstétrica, una complicación oncológica, entre otros. En esta época de constantes cambios hemos tenido que aprender a reinventarnos, es una época que nos exige conocimientos y experiencia. Es por ello, que tenemos a bien presentarles el V SIMPOSIUM CENTROAMERICANO Y DEL CARIBE DE EMERGENCIAS MÉDICAS, en donde se abordará a lo largo de tres sesiones algunos de los motivos de consulta más frecuentes a nivel de emergencia, con ponentes de referencia que aportarán a la educación médica continua de la región.

19 mayo
Este VI Simposium de Síndrome Coronario Crónico tiene como objetivo presentar los aspectos más actualizados en el diagnóstico y tratamiento de esta condición. Existen tratamientos innovadores como Ranolazina, aprobados por la EMA y la FDA, que se utilizan para el tratamiento de la angina crónica. Este fármaco brinda al paciente una disminución de episodios anginosos a la semana, menor recurrencia de isquemia, mayor tolerancia al ejercicio y mejora la calidad de vida, el cual tendrá un espacio muy importante dentro del programa científico para demostrar su evidencia científica. Como Área Científica Menarini, estamos comprometidos de todo corazón con la actualización y educación médica continua con ponentes internacionales y regionales, referentes en el tratamiento de esta condición crónica que incide en la calidad de vida de la población a nivel mundial y esperamos que este simposio llene sus expectativas académicas y de actualización en el ámbito del abordaje del Síndrome Coronario Crónico.

07 julio
Las enfermedades cardiovasculares continúan siendo una de las principales causas de discapacidad y muerte prematura a nivel mundial. La aterosclerosis, que progresa silenciosamente a lo largo de los años, es el problema subyacente, manifestándose a menudo en etapas avanzadas cuando aparecen los síntomas. Los eventos coronarios y cerebrovasculares agudos pueden ocurrir repentinamente, subrayando la importancia de la prevención y el manejo temprano. La alta prevalencia de factores de riesgo cardiovascular en la población adulta exige estrategias efectivas para reducir la morbilidad y la mortalidad cardiovascular. Dado el impacto epidemiológico de las enfermedades cardiovasculares y su alto costo para los países y las familias, el objetivo de este XIX Simposio Centroamericano y del Caribe de Actualización en Enfermedad Cardiovascular es fortalecer los conocimientos sobre estas enfermedades y promover la conciencia sobre la importancia de modificar los hábitos de vida para reducir los factores de riesgo.

14 julio
La hipertensión arterial y la cardiopatía isquémica continúan siendo una de las principales causas de mortalidad a nivel mundial, representando un desafío significativo para la salud pública. Si bien el enfoque actual se centra en el riesgo cardiovascular global, que involucra la presión arterial (PA) elevada, factores de riesgo cardiovascular, diabetes mellitus, síndrome metabólico y daño orgánico, el nivel de PA por sí solo sigue siendo un predictor importante de mortalidad cardiovascular. En las guías de 2024, se enfatiza aún más la importancia de la medición ambulatoria de la presión arterial (MAPA) y la auto medición en el hogar para confirmar el diagnóstico y monitorear el tratamiento. Además, se presta mayor atención al manejo de la hipertensión resistente y a la optimización del tratamiento farmacológico, incluyendo combinaciones de medicamentos y la consideración de terapias novedosas. Este Master Course se enfocará en el manejo integral de la hipertensión y los factores de riesgo cardiovascular, así como la enfermedad coronaria mediante presentaciones y debates de enfoques de actualidad sobre estos temas

28 mayo
El bienestar femenino abarca diferentes etapas en la vida, cada una con requerimientos nutricionales específicos que influyen en la salud física y emocional. Los micronutrientes - vitaminas, minerales y compuestos esenciales - juegan un papel fundamental para acompañar esta transición saludable. En la adolescencia, aumentan los requerimientos de hierro, calcio y vitamina D, mientras que el magnesio y los ácidos grasos omega-3 pueden ayudar a mitigar los síntomas del síndrome premenstrual. Como Grupo Menarini hemos trabajado en diseñar cuidadosamente el programa de este evento científico, para ofrecer una visión actualizada en micronutrientes, reuniendo a expertos en salud y nutrición con el objetivo de explorar, desde una perspectiva basada en evidencia, los complementos alimenticios que pueden contribuir al equilibrio nutricional, la salud ósea, el metabolismo energético y la calidad de vida en la mujer.

15 mayo
Primer Congreso de Cardiología del Hospital Roosevelt, titulado Temas Selectos de Cardiología Una Mirada Al Futuro. Fecha: 15 y 16 de mayo Lugar: Hotel Soleil La Antigua, Antigua Guatemala

08 mayo
La SUMMER SCHOOL es una iniciativa académica independiente de la Sociedad Europea de Hipertensión, basada en los programas que esta institución realiza en Europa. En esta edición, el evento presencial se llevará a cabo en la Ciudad de Guatemala y contará con una transmisión en vivo a través de esta plataforma, facilitando así el acceso a profesionales de la salud de toda la región. La presente inscripción corresponde a la modalidad en línea, que le permitirá seguir en tiempo real las conferencias y actividades científicas, impartidas por reconocidos expertos internacionales en el campo de la hipertensión arterial y el riesgo cardiovascular.

16 junio
Estamos pues ante un inminente encuentro entre dos ciencias que comparten mucho más de lo que teóricamente les separa, la psiquiatría y la neurología, dos enfoques complementarios y profundamente necesarios para la mejor comprensión de funciones complejas del sistema nervioso y cuya brecha es cada vez más estrecha. Grupo Menarini consciente de la necesidad de este acercamiento entre la psiquiatría y la neurología organiza el VII Simposium Centroamericano y del Caribe de Neurociencias.

21 julio
Grupo Menarini, a través de Área Científica Menarini, consciente de la necesidad e importancia de la Educación Médica Continua, realiza el XVI Simposium Centroamericano y del Caribe de Actualización en Odontoestomatología, con el fin de transmitir el conocimiento de causa y efecto de cualquier patología oral con todos los pormenores y generar discusión de los casos odontológicos presentados, con los colegas de las diferentes áreas y especialidades médicas que darán como resultado un diagnóstico más seguro de la entidad que está en curso y un tratamiento efectivo para beneficio de la persona que merece todo el esfuerzo

04 agosto
La población pediátrica se encuentra expuesta a diferentes tipos de ambientes, los cuales tienen una profunda influencia en su crecimiento y desarrollo. Las exposiciones medioambientales, son tanto nocivas como beneficiosas para la salud, y no funcionan por separado, sino que interactúan como determinantes sociales y nutricionales de la salud, para influir en el bienestar de cada uno de ellos. Sean cuales sean los recursos naturales y el nivel de desarrollo económico, para todos los países y todas las comunidades, la población pediátrica representa el futuro, el cual debe cultivarse y protegerse.

11 agosto
La salud masculina integral es un tema de creciente interés en la práctica médica, no solo por su impacto en la calidad de vida de los pacientes, sino también por su estrecha relación con diversos factores cardiovasculares, metabólicos y emocionales. Según la OMS se estima que 320 millones de hombres presenten disfunción eréctil en el año 2025, siendo una enfermedad que afecta en su mayoría a los hombres mayores de 40 años, sin embargo, hasta un 20% de la población menor de 40 años puede padecerla. En este contexto, el tadalafilo se ha consolidado como una molécula clave gracias a su eficacia, seguridad y versatilidad terapéutica, con aplicaciones que van más allá de la disfunción eréctil, desde el 2018 la FDA aprobó la dosis de 5mg para el tratamiento de la hiperplasia benigna de próstata. Como Grupo Menarini hemos trabajado en diseñar cuidadosamente el programa de este evento científico, para ofrecer una visión actualizada en el abordaje terapéutico de la Disfunción Eréctil, con el objetivo de explorar, desde una perspectiva basada en evidencia, el abordaje integral de esta patología.

22 septiembre
Grupo Menarini a través de Área Científica Menarini, ha sido pionera en la implementación de la educación continua en las diferentes ramas que brindan atención en salud de la población en general. Dentro de este contexto, el asistente de farmacia juega un papel fundamental en el asesoramiento del paciente y del adecuado uso de los fármacos, además forma parte de la imagen del punto de venta al cual representa. El X Simposium Centroamericano y del Caribe de Actualización en Atención Farmacéutica en su versión Online, dirige su máximo esfuerzo en la actualización del personal de farmacia de los principales retailers farmacéuticos de la región y del personal de contacto con el usuario final, proporcionando un medio por el cual el asistente reciba información técnico científica encaminada a la profesionalización de la administración de categorías, la mejora de habilidades comerciales, servicio al cliente y la adecuada orientación y utilización de medicamentos de calidad.

18 agosto
La educación médica continua en gastroenterología es un proceso de enseñanza-aprendizaje activo, con el fin de mejorar las capacidades frente a la evolución científica-tecnológica y los cambios en las necesidades sociales, para obtener nuevos conocimientos, valorando la vigencia de los adquiridos y complementando las carencias de manera que los resultados del ejercicio profesional sean de máxima calidad. Actualmente, dichas actividades se dirigen a mejorar la capacidad diagnóstica de las principales patologías del tracto gastrointestinal, aplicar nuevos tratamientos, de mejorar en la gestión y calidad integral de la atención especializada al paciente de una manera multidisciplinaria; ya que, cualquier enfermedad digestiva como: un síndrome de malabsorción por deficiencias enzimáticas, desórdenes intestinales y gastroesofágicos, podría conllevar a una afección persistente de la salud y del bienestar físico, mental y social del paciente que la padece. Es por ello que, hemos elaborado el programa del XIII Simposium Centroamericano y del Caribe de Actualización en Enfermedades Digestivas basándonos en la importancia de dar a conocer información médica actualizada.

30 julio
Grupo Menarini Centroamérica y el Caribe, siempre comprometido con la educación médica continua y las problemáticas actuales, organiza la retransmisión del I Foro Multidisciplinario de Expertos en Vitamina D, donde se abordarán temas relacionados a los riesgos de padecer esta deficiencia, pero también las soluciones para mejorar la calidad de vida de los pacientes.

08 octubre
Este V Simposium Centroamericano y del Caribe de Actualización Integral en Anticoagulación tiene como objetivo concientizar acerca de la carga de mortalidad causada por la trombosis en general, la necesidad de acción y, más específicamente, la amenaza no reconocida y las graves consecuencias de la ETV y la FA. Así mismo, los investigadores y ponentes principales a nivel mundial de estas condiciones, compartirán su experiencia en distintos escenarios que permitan una actualización importante en su abordaje integral. En MENARINI seguimos apostando por mejorar de Todo Corazón la Salud Cardiovascular de sus pacientes.

12 agosto
La retransmisión del I Foro Multidisciplinario Centroamericano y del Caribe de expertos en enfermedades infecciosas tiene como objetivo presentarles una nueva opción en antibioticoterapia, Cefditoren, una cefalosporina oral de tercera generación con características diferenciadoras respecto a otros integrantes de este grupo.

10 noviembre
Grupo Menarini consciente de la necesidad de la educación médica continua de calidad en el gremio médico, teniendo en cuenta que tiene su núcleo fundamental en el autoaprendizaje individual, realiza este tipo de actividades a nivel mundial y se ha constituido como líder indiscutible en eventos de alto nivel científico en Centroamérica y el Caribe. Este VI Curso Centroamericano y del Caribe de Salud Sexual tiene como objetivo el promover y facilitar a los médicos con educación médica continua en el ámbito de salud sexual, y de los avances en su manejo clínico y tratamiento que permitan una mejoría importante en la salud sexual y mental del hombre y su pareja.

09 junio
La Enfermedad Arterial Coronaria representa un desafío médico de gran importancia en la actualidad. Según la Organización Mundial de la Salud las enfermedades cardiovasculares son la principal causa de muerte a nivel mundial, cobrando millones de vidas cada año. El Síndrome Coronario Crónico, con sus factores de riesgo, desafíos diagnósticos y terapéuticos, representan un área de constante evolución en la medicina cardiovascular. Como profesionales comprometidos con la excelencia en la atención médica, es imperativo que nos mantengamos al día con las últimas evidencias científicas y las mejores prácticas clínicas en este campo en constante cambio. Este evento científico “Conociendo a los Expertos Edición II” proporcionará un espacio único donde los cardiólogos regionales podrán interactuar y aprender de destacados especialistas internacionales en el campo del Síndrome Coronario Crónico. A través de sesiones interactivas,presentación y discusión de casos clínicos, los participantes tendrán la oportunidad de profundizar sus conocimientos sobre los aspectos más relevantes, incluyendo diagnóstico diferencial, estratificación de riesgos, y opciones de tratamiento médico óptimo.

07 octubre
LA RINOSINUSITIS CRÓNICA CON POLIPOSIS NASAL (RSCCPN) ES UNA ENFERMEDAD CRÓNICA INFLAMATORIA DE LAS FOSAS NASALES Y SENOS PARANASALES QUE CARACTERIZA POR LA PRESENCIA DE PÓLIPOS EN LA CAVIDAD NASAL. SE CONSIDERA CRÓNICA PORQUE LA PRESENCIA DE DOS O MÁS SÍNTOMAS SE PROLONGA DURANTE MÁS DE 12 SEMANAS. AFECTA A ENTRE UN 4 Y UN 5% DE LA POBLACIÓN GENERAL, SOBRE TODO A VARONES, DE ENTRE 40 Y 50 AÑOS, Y SUPONE UN GRAN IMPACTO PARA LA CALIDAD DE VIDA DE QUIENES LA SUFREN. EL IMPACTO EN LA CALIDAD DE VIDA DE LA RSCCPN SE HA LLEGADO A COMPARAR CON OTRAS ENFERMEDADES DEBILITANTES COMO LA INSUFICIENCIA CARDÍACA, EL DOLOR DE ESPALDA CRÓNICO O LA ENFERMEDAD PULMONAR OBSTRUCTIVA CRÓNICA. ESTA PATOLOGÍA SUPONE ADEMÁS UN GRAN CONSUMO DE RECURSOS SANITARIOS, TANTO AMBULATORIOS COMO HOSPITALARIOS Y UN ELEVADO COSTO INDIRECTO EN TÉRMINOS DE PRODUCTIVIDAD LABORAL. ES POR ELLO QUE EN ESTE II CURSO CENTROAMERICANO Y DEL CARIBE DE ACTUALIZACIÓN SOBRE GUÍAS DE RINOSINUSITIS CRÓNICA CON POLIPOSIS NASAL, ABORDAREMOS LOS DIFERENTES CONSENSOS PARA EL DIAGNÓSTICO Y TRATAMIENTO DE LA RSCP, CON EL FIN DE BRINDAR UNA GUÍA PRÁCTICA MULTIDISCIPLINAR QUE PROPORCIONE RECOMENDACIONES BASADAS EN PRUEBAS CIENTÍFICAS.

28 julio
En el campo de la cardiología contemporánea, la fibrilación auricular emerge como un desafío clínico de magnitud creciente, con implicaciones significativas en la morbilidad y mortalidad cardiovascular. Ante este panorama, la actualización en anticoagulación se alza como un eje cardinal en la atención integral de los pacientes afectados por esta arritmia, constituyendo un elemento fundamental en la optimización del pronóstico y la calidad de vida. La complejidad fisiopatológica de la fibrilación auricular, caracterizada por la turbulencia eléctrica y mecánica en las aurículas, conlleva un riesgo incrementado de eventos tromboembólicos, tales como accidente cerebrovascular y embolia sistémica. En este contexto, el abordaje terapéutico anticoagulante surge como un pilar irremplazable, destinado a mitigar dicho riesgo y prevenir consecuencias devastadoras para la salud del paciente. Grupo Menarini Centroamérica y el Caribe, consciente de la necesidad de la educación médica continua de calidad en el gremio médico y tomando en cuenta el impacto de esta condición cardiovascular en nuestra región, reafirma su compromiso de mantener su posición como líder en la educación médica continua.

30 septiembre
Grupo Menarini a través de Área Científica Menarini, ha sido pionera en la implementación de la educación continua en las diferentes ramas que brindan atención en salud de la población en general. Dentro de este contexto, el asistente de farmacia juega un papel fundamental en el asesoramiento del paciente y del adecuado uso de los fármacos, además forma parte de la imagen del punto de venta al cual representa. En la actualidad, el papel de los probióticos en la salud y el bienestar es cada vez más reconocido, y su uso se ha extendido significativamente. Como dependientes de farmacia y farmacéuticos, son un pilar fundamental en la orientación y dispensación de estos productos a los pacientes. El I Curso Centroamericano y del Caribe de Probióticos en la Práctica Farmacéutica en su versión Online, dirige su máximo esfuerzo en la actualización del personal de farmacia de los principales retailers farmacéuticos de la región y del personal de contacto con el usuario final.

19 septiembre
La microbiota intestinal está presente en el ser humano desde la concepción hasta la vejez, está definida como un conjunto de microorganismos que residen en nuestro cuerpo, que a su vez tiene diferentes funciones beneficiosas como la digestión, la síntesis de vitaminas, la protección contra patógenos y la modulación del sistema inmunológico. Grupo Menarini Centroamérica y El Caribe consciente que no todos los probióticos son iguales y de la necesidad de la educación médica continua de calidad y actualizada en el gremio médico, teniendo en cuenta que tiene su núcleo fundamental en el autoaprendizaje individual, realiza este tipo de actividades a nivel mundial, constituyéndose como líder indiscutible en eventos de alto nivel científico en Centroamérica y República Dominicana.

14 octubre

24 noviembre
Las enfermedades infecciosas representan un grave problema de salud global, la cual se asocia a una elevada morbimortalidad. La medicina actual ha cambiado el panorama de las enfermedades infecciosas por múltiples razones, pacientes geriátricos con comorbilidades, sometidos a procedimientos diagnósticos y terapéuticos más invasivos que propician la infección, además de la utilización de diferentes inmunomoduladores que han cambiado el espectro etiológico de las infecciones, así como la aparición de un nivel de resistencias y modificaciones de la microbiota como no se ha visto hasta ahora, cuya principal consecuencia es la dificultad de acertar con el tratamiento antimicrobiano empírico que incrementa de forma significativa la mortalidad en las infecciones graves. El III Foro Multidisciplinario Centroamericano y del Caribe de Expertos en Enfermedades Infecciosas tiene como objetivo presentarles una nueva opción en antibioticoterapia, Cefditoren, una cefalosporina oral de tercera generación con características diferenciadoras respecto a otros integrantes de este grupo.

22 septiembre
La rinitis alérgica es una de las enfermedades crónicas más comunes a nivel mundial, afectando hasta al 40 % de la población mundial, desde niños hasta adultos. Aunque a menudo es subestimada, su impacto en la vida diaria, el rendimiento escolar, la productividad laboral y el bienestar general puede ser considerable. Comprender su naturaleza y las estrategias para su control es fundamental para minimizar sus efectos y mejorar la calidad de vida de los pacientes. Como Grupo Menarini, hemos diseñado cuidadosamente el programa de este evento científico con el fin de ofrecer una visión actualizada sobre el abordaje terapéutico de la rinitis alérgica. Nuestro objetivo es explorar las combinaciones intranasales y dar a conocer la combinación innovadora, Olopatadina- Furoato de Mometasona, desde una perspectiva basada en evidencia y con un enfoque integral para esta patología. Esperamos que este evento represente una valiosa oportunidad para el intercambio de conocimientos y permita fortalecer el compromiso con una atención médica que priorice el bienestar integral del paciente con rinitis alérgica.

04 noviembre
Este II Master Course Centroamericano y del Caribe de Actualización en Odontoestomatología está dividido en 3 módulos, con un total de 28 conferencias donde se abordarán temas muy destacados, algunos de ellos sugeridos por ustedes y que abarcan un amplio abanico de áreas que son del máximo interés para el dentista general y para los especialistas de la odontología.

08 septiembre
Los probióticos son bacterias vivas, que al ser administrados en cantidades adecuadas, confieren un beneficio a la salud en el huésped, actuando directamente en la regulación de la microbiota. Las propiedades beneficiosas están relacionadas con cada cepa. El uso correcto de los probióticos puede contribuir a la microbiota, ayudando a mantener su equilibrio, mejorar la digestión y absorción de nutrientes, y fortalecer el sistema inmunológico. Tienen la capacidad de acortar la duración de la diarrea de diversas etiologías y restaurar la función intestinal. El interés creciente en la microbiota intestinal y su relación con la salud humana ha impulsado una nueva era para su modulación teniendo un papel protagónico los probióticos quienes han pasado a ocupar un lugar relevante en diversas áreas de la práctica médica. Desde la introducción de los probióticos a base de levadura en 1961, las propuestas han evolucionado para incluir formulaciones avanzadas como los productos multicepa.

02 diciembre
La hiperplasia prostática benigna (HPB) es una condición médica común en hombres mayores de 50 años, que se caracteriza por el crecimiento anormal de la glándula prostática y puede resultar en síntomas del tracto urinario inferior (STUI). Se estima que en todo el mundo, alrededor del 50% de los hombres mayores de 50 años tienen síntomas relacionados con la HPB. En América Latina, la prevalencia de HPB se estima en un 50%, con una mayor incidencia en hombres mayores de 70 años. Es esencial que los urólogos, médicos generales y dependientes de farmacia estén actualizados en cuanto a los avances más recientes en el diagnóstico y tratamientos de los STUI relacionados con la HPB. Este segundo seminario de actualización tiene como objetivo proporcionar a los participantes información relevante y actualizada sobre los diversos enfoques terapéuticos disponibles, desde la fitoterapia hasta la combinación de fármacos, así como destacar el papel crucial que desempeña el dependiente farmacéutico en la detección temprana de los síntomas de HPB.

06 octubre
La salud sexual del hombre es un tema de creciente interés en el ámbito médico, no solo por su influencia en la calidad de vida de los pacientes, sino también por su conexión con distintos factores cardiovasculares, metabólicos y emocionales. En este contexto, es crucial que los profesionales de la salud adopten un enfoque holístico que contemple todos estos aspectos interrelacionados. La disfunción eréctil, por ejemplo, no debe ser vista como un problema aislado, sino como un potencial indicador de otras condiciones subyacentes que podrían requerir atención médica. La educación continua y el intercambio de conocimientos entre especialistas son fundamentales para mejorar el diagnóstico y tratamiento de estas condiciones. Al fomentar un diálogo abierto y colaborativo, se desarrollan intervenciones efectivas que aborden el tratamiento integral de estas patologías.

17 febrero
La salud masculina integral es hoy una prioridad médica. Ante la proyección de la OMS de 320 millones de hombres con disfunción eréctil para 2025, incluyendo un 20% de menores de 40 años, la medicina actual exige soluciones que combinen eficacia, seguridad y rapidez. En este escenario, Avanafilo se posiciona como la molécula de última generación gracias a su inmediatez, siendo el inhibidor de la PDE5 de acción más rápida al actuar en solo 15-30 minutos, además de ofrecer una selectividad superior que reduce los efectos secundarios y un perfil farmacocinético que mejora la calidad de vida al permitir una experiencia eficaz y con menor tiempo de espera a pesar de tener comorbilidades como la diabetes mellitus.

12 marzo
La diabetes mellitus tipo 2 (DM2) continúa siendo una de las principales causas de morbimortalidad a nivel mundial, asociándose estrechamente con complicaciones cardiovasculares y renales que comprometen la calidad y expectativa de vida de los pacientes. El enfoque contemporáneo del manejo de la DM2 implica no solo lograr un control glucémico adecuado, sino también prevenir eventos cardiovasculares, minimizar el riesgo de hipoglucemia y preservar la función renal a largo plazo. Grupo Menarini Centroamérica y el Caribe, reconociendo la necesidad de educación médica continua de calidad, organiza este tipo de actividades a nivel mundial, consolidándose como líder en educación médica continúa en la región.

12 febrero

17 marzo
La atención primaria de salud es la asistencia sanitaria esencial accesible a todos los individuos adoptando una visión holística de salud. La educación médica continua en atención primaria tiene como finalidad proporcionar conocimiento válido, útil y preciso que permita tomar decisiones dirigidas a prestar una asistencia sanitaria a la población, ajustada a sus necesidades, garantizando mayor eficacia, seguridad y calidad. En la actualidad la creciente demanda de salud de nuestras poblaciones se ve limitada por una realidad en la cual imperan dos escenarios: la constante problemática de los deficientes sistemas de salud y la pérdida de la relación médico-paciente concebida como la base de la Atención Primaria. Grupo Menarini Centroamérica y el Caribe, tomando en cuenta que la Atención Primaria es la base del sistema de salud de cualquier país y al mismo tiempo es la solución de los problemas más comunes que aquejan a la población latinoamericana, considera que es de vital importancia proveer las herramientas necesarias al profesional de salud para enfrentar su entorno cada vez más demandante.

14 abril
Grupo Menarini, a través de Área Científica Menarini, ha sido pionera en la implementación de la educación continua en las diferentes ramas que brindan atención en la salud de la población en general. Dentro de este contexto, los ginecólogos y obstetras juegan un papel fundamental en el cuidado integral de la salud de la mayor parte de la población, atendiendo las necesidades de la mujer a lo largo de su vida. Las mujeres tienen necesidades de salud únicas, como el cuidado previo, durante y posterior al embarazo y la menopausia, incluso, padecimientos que pueden afectar su calidad de vida de manera diferente, como el Síndrome de Anticuerpos Antifosfolípidos y el manejo del dolor ante las distintas comorbilidades. Este VIII Simposium busca fomentar el trabajo multidisciplinario y el abordaje integral de los temas relevantes en la salud femenina, con especial énfasis en el embarazo de alto riesgo, dolor postoperatorio, anticoncepción, así como higiene e hidratación íntima, en los diferentes escenarios clínicos, permitiendo el intercambio de experiencias clínicas y científicas, aportando como Área Científica formación de alto nivel y temas de vanguardia.

21 abril
En los últimos años, la ciencia nos ha demostrado que el estudio riguroso de estos microorganismos ha revolucionado la medicina moderna. Ya no solo hablamos de su eficacia demostrada en la prevención y tratamiento de trastornos gastrointestinales clásicos, como la diarrea asociada a antibióticos, la infección por Helicobacter pylori o el síndrome de intestino irritable. Hoy, la evidencia científica nos invita a ver más allá y explorar las fascinantes conexiones sistémicas de nuestro cuerpo. Hemos descubierto que el microbioma y su modulación influyen directamente en la respuesta de nuestro sistema inmunológico, e incluso, en la compleja red bidireccional del eje intestino-cerebro, la cual impacta de manera directa en enfermedades neurológicas, psiquiátricas, enfermedades metabólicas e incluso del neurodesarrollo. Es por ello que los invitamos a sumergirse con gran entusiasmo en este simposium de actualización. Durante los próximos tres días de transmisión en línea, contaremos con un programa excepcional diseñado para aportar un alto valor a su labor diaria. Expertos y ponentes de primer nivel nos guiarán a través de conferencias magistrales.

05 mayo
Las enfermedades alérgicas son procesos frecuentes, que afectan en diferentes etapas de la vida, desde la académica y laboralmente productiva, como en las actividades cotidianas y a menudo perturban la calidad de sueño. El objetivo principal de los medicamentos utilizados en la terapia de estas enfermedades son el control de síntomas y la mejora de la calidad de vida, limitando la progresión de la enfermedad y enfocada en el abordaje oportuno de los brotes en fase aguda, siendo los fármacos ideales aquellos con un inicio de acción rápida y duración prolongada, con menores efectos adversos. El XIX Simposio Centroamericano y Del Caribe Multidisciplinario de Enfermedades Alérgicas y de Piel está orientado al manejo integral de las enfermedades alérgicas, enfocándose principalmente en rinitis y urticaria. Busca resaltar la importancia de un abordaje oportuno a través de métodos que permitan al médico tener los parámetros establecidos en las guías de prácticas clínicas para el manejo de los síntomas.

12 mayo
Las enfermedades alérgicas afectan a más de 1,000 millones de personas en el mundo, con un constante incremento, que se espera alcanzar el 50% de la población para el 2,050. Entre estas enfermedades, las más comunes son rinitis/conjuntivitis y asma alérgica, rinosinusitis con o sin poliposis nasosinusal y urticaria crónica. La rinitis es una enfermedad crónica no transmisible con una prevalencia del 10 al 20% de la población. Es de gran impacto en el sector económico y la calidad de vida del paciente. Esto sin tener en cuenta su estrecha relación con el asma, que tiene una prevalencia 5 a 10% de la población general, siendo la rinitis alérgica un factor de riesgo para esta enfermedad, pues aproximadamente el 20-40% de pacientes con RA presentan asma. De igual forma la prevalencia de rinosinusitis crónica (10-15%) y poliposis nasal (2-5%) va en constante aumento. El 90% de los asmáticos con intolerancia a AINEs lo presentan.

17 febrero
Área Científica Menarini les da la más cordial bienvenida a nuestro exclusivo Programa de Retail Farmacéutico. Entendemos que el ecosistema de la farmacia evoluciona a un ritmo sin precedentes, demandando de los profesionales una visión estratégica y actualizada para prosperar. Durante los próximos dos días intensivos, hemos diseñado un espacio de networking y aprendizaje de alto nivel, reuniendo a expertos para abordar los desafíos y oportunidades que definen el futuro del sector. Nuestra primera jornada se centrará en los pilares fundamentales del negocio, comenzando con un análisis profundo sobre el mercado farmacéutico y tendencias globales. Esta perspectiva crucial se complementará con módulos dedicados a la administración eficiente de la farmacia; revisaremos cómo optimizar los procesos internos y logísticos, asegurando una gestión de recursos sólida y una rentabilidad sostenida en un entorno cada vez más competitivo. Asimismo, estaremos abordando temas sobre los servicios de valor agregado en la farmacia y su rentabilidad.

02 junio
Consciente de la importancia de la labor del Higienista Dental, Grupo Menarini Centroamérica y el Caribe, desarrolla este programa de Educación Médica Continua enfocado en brindar educación y formación actualizada al gremio de Higienistas, Asistentes Dentales de la región Centroamericana con el III Curso Centroamericano y del Caribe de Actualización para Higienistas Dentales y generar la discusión de los casos y perfiles de trabajo dentro de la clínica dental, siempre en la búsqueda de la mejora continua de la atención del paciente.
23 noviembre

22 junio
Hablar sobre problemas sexuales es siempre complicado y provoca vergüenza y ansiedad, especialmente para los hombres. Sin embargo, es quizás aún más difícil porque esto no es siempre visto como un problema médico real con una causa y tratamientos viables. En cualquier caso, la consulta con un médico es recomendada para un correcto diagnóstico y tratamiento. Las disfunciones sexuales pueden manifestarse al comienzo de la vida sexual de la persona o pueden desarrollarse más adelante. Algunas de ellas pueden desarrollarse paulatinamente con el tiempo, y otras pueden aparecer súbitamente como incapacidad total o parcial para participar de una o más etapas del acto sexual.

13 mayo
Las enfermedades bucodentales han afectado a la humanidad desde sus mismos inicios, en especial el dolor agudo dentario producido por una caries profunda o un absceso periapical. Técnicas curativas y rehabilitadoras han sido practicadas por muchos médicos a lo largo de la historia. Grupo Menarini, a través de Área Científica Menarini, consciente de la necesidad e importancia de la Educación Médica Continua, realiza el XVII Simposium Centroamericano y del Caribe de Actualización en Odontoestomatología, con el fin de transmitir el conocimiento de causa y efecto de cualquier patología oral con todos los pormenores y generar discusión de los casos odontológicos presentados, con los colegas de las diferentes áreas y especialidades médicas que darán como resultado un diagnóstico más seguro de la entidad que está en curso y un tratamiento efectivo para beneficio de la persona que merece todo el esfuerzo por parte del profesional para obtener el mejor resultado del paciente.

14 mayo
II CONGRESO DE LA UNIDAD DE CARDIOLOGÍA HOSPITAL ROOSEVELT

15 junio
En la actualidad, el papel de los probióticos en la salud y el bienestar es cada vez más reconocido, y su uso se ha extendido significativamente. Como dependientes de farmacia y farmacéuticos, son un pilar fundamental en la orientación y dispensación de estos productos a los pacientes. El I Curso Centroamericano y del Caribe de Probióticos en la Práctica Farmacéutica en su versión Online, dirige su máximo esfuerzo en la actualización del personal de farmacia de los principales retailers farmacéuticos de la región y del personal de contacto con el usuario final.

08 junio
Grupo Menarini Centroamérica y El Caribe consciente que no todos los probióticos son iguales y de la necesidad de la educación médica continua de calidad y actualizada en el gremio médico, teniendo en cuenta que tiene su núcleo fundamental en el autoaprendizaje individual, realiza este tipo de actividades a nivel mundial, constituyéndose como líder indiscutible en eventos de alto nivel científico en Centroamérica y República Dominicana.

03 agosto

21 julio
El VII Seminario Centroamericano y del Caribe de Medicina del Deporte y Rehabilitación, organizado por el Área Científica de Grupo Menarini, ofrece una visión multidisciplinaria orientada a la salud, bienestar y rendimiento del deportista. Basado en los principios éticos del Código Médico del Movimiento Olímpico, el evento abordará el impacto positivo del ejercicio en la prevención de enfermedades crónicas, cardiovasculares y de salud mental. Asimismo, se enfocarán las mejores prácticas para el manejo oportuno de lesiones, dolor, nutrición y suplementación, garantizando una reincorporación segura a la actividad física.

06 julio
Las enfermedades cardiovasculares continúan siendo una de las principales causas de discapacidad y muerte prematura a nivel mundial. La aterosclerosis, que progresa silenciosamente a lo largo de los años, es el problema subyacente, manifestándose a menudo en etapas avanzadas cuando aparecen los síntomas. Los eventos coronarios y cerebrovasculares agudos pueden ocurrir repentinamente, subrayando la importancia de la prevención y el manejo temprano. La alta prevalencia de factores de riesgo cardiovascular en la población adulta exige estrategias efectivas para reducir la morbilidad y la mortalidad cardiovascular. La eficacia de los medicamentos antihipertensivos ha mejorado significativamente. Las guías más recientes enfatizan la necesidad de individualizar el tratamiento, a menudo requiriendo la combinación de medicamentos con diferentes mecanismos de acción para lograr un control óptimo de la presión arterial. El tratamiento combinado se reconoce ahora como necesario para la mayoría de los pacientes con hipertensión.

13 julio
La hipertensión arterial y la cardiopatía isquémica continúan siendo una de las principales causas de mortalidad a nivel mundial, representando un desafío significativo para la salud pública. Si bien el enfoque actual se centra en el riesgo cardiovascular global, que involucra la presión arterial (PA) elevada, factores de riesgo cardiovascular, diabetes mellitus, síndrome metabólico y daño orgánico, el nivel de PA por sí solo sigue siendo un predictor importante de mortalidad cardiovascular. En las guías de 2024, se enfatiza aún más la importancia de la medición ambulatoria de la presión arterial (MAPA) y la auto medición en el hogar para confirmar el diagnóstico y monitorear el tratamiento. Además, se presta mayor atención al manejo de la hipertensión resistente y a la optimización del tratamiento farmacológico, incluyendo combinaciones de medicamentos y la consideración de terapias novedosas.